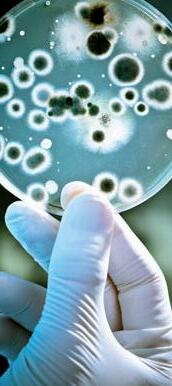

Aumenta procura por procedimentos estéticos



Aumenta procura por procedimentos estéticos


>> Relatório revela o grande número de crianças que não foram imunizadas contra difteria, tétano e coqueluche. Contra pólio, foram 17 mil crianças. MOSSORÓ 3










Lawrence e Allyson têm projetos conflitantes




Presidente da Câmara quer ser vice na chapa do prefeito em 2024. Allyson resiste à ideia. CÉSAR SANTOS 5

Gigante mundial se interessa pelo Porto-Indústria Verde do RN

Empresa chinesa oficializa o pedido de acesso ao estudo de viabilidade do projeto do RN. PRINCIPAL 3
Inventário geológico RN identifica 150 novos locais

Com o novo trabalho, os pesquisadores da UFRN ampliaram os pontos de observação. PRINCIPAL 6
DOMINGO DE CLÁSSICOS NA RODADA DO BRASILEIRÃO

CADERNOS



Organização: CLAUDER ARCANJO


crevia profissionalmente desde 1900 e havia publicado artigos em jornais como o londrino The Guardian, e ainda contos primorosos, ela que reinventou a ficção em língua inglesa, influenciada por Joyce e também por Proust, desconstruiu o gênero épico tornando-o lírico, com leveza, subjetividade e reflexão filosófica. A “trama” deixa de ter o protagonismo na narrativa, substituída pelo fluxo de consciência e individualidade das personagens, que são seres comuns, a maioria sem grandeza, aliás, todos meio apequenados, achatados, longe de heroísmos.
Melhor que tudo, no entanto, é a narração poética, como podemos ver na bela passagem a seguir:
Quem não tem paciência não deve lê-lo. Quem estiver esperando algo como um thriller de tirar o fôlego não deve lê-lo. Porque se trata de livro da espetacular Virginia Woolf (1882-1941) em que o que menos acontece é ação, no sentido usual da palavra. Não há nenhuma peripécia nas mais de 520 páginas de A viagem (SP: Novo Século, 2008, tradução de Lya Luft), seu primeiro romance, iniciado provavelmente em 1906 e publicado em versão definitiva em 1915.
É uma triste viagem. Escrito num período de muito sofrimento da autora pela perda de familiares queridos, pais e irmãos, e ainda passando por profundas crises depressivas, tentativas de suicídio e longo internamento, o livro nos leva da Inglaterra a Santa Marina, pequena cidade portuária em algum lugar da América do Sul (onde a autora nunca pôs os pés). O navio Euphrosyne parte de Londres com um grupo de passageiros, que iremos conhecer aos poucos, entre eles a jovem Rachel, o casal Dalloway (cuja mulher Clarissa será protagonista da obraprima Mrs. Dalloway, de 1925) e os tios da jovem, Ridley e Helen Ambrose, que dela cuidarão durante a viagem e permanência na villa do casal em Santa Marina.
Como se trata de um grande navio de carga com poucos passageiros, a expectativa do leitor é que, como costuma acontecer nas histórias de viagem no mar, ocorrerão muitas aventuras entre os passageiros ou algum desastre com o navio. Mas é de Virginia Woolf que estamos falando. Da escritora à frente de seu tempo, politizada, feminina e feminista – como se verá no ensaio
Um teto todo seu, de 1920, em que fala da dificuldade que as mulheres escritoras e intelectuais enfrentam devido ao domínio dos homens sobre o mercado editorial, praticamente impedindo-lhes a entrada nesse reduto predominantemente masculino à época. Ela, que já es-

Era [o navio] mais solitário do que uma caravana atravessando o deserto; era infinitamente mais misterioso movendo-se por seu próprio poder e sustentado por suas próprias fontes. O mar poderia lhe dar a morte ou alguma alegria sem igual, e ninguém saberia de nada. O navio era uma noiva avançando para seu marido, uma virgem desconhecida dos homens; no seu vigor e pureza podia ser comparado a todas as coisas belas, pois como navio tinha vida própria. (p. 60).
Assim são os personagens de viagem: um grupo de ingleses reunidos num hotel em Santa Marina, muitas vezes entediados com o pouco que fazer, esses tomadores de chá no calor tropical escaldante jogam xadrez e leem jornais, além de fazerem com pontualidade britânica as quatro refeições do dia. Não sabemos a razão da viagem e da longa permanência num lugar que, se tem a beleza do mar, da floresta, nada mais tem a oferecer. A não ser que tivessem o gosto de se sentirem aprisionados por já viverem numa ilha como a Inglaterra. Aí é que entra a perspicaz Virginia Woolf deixandoos tagarelar com sua fina educação cheia de veneno em conversas cifradas ou veladas. Parece que nada vai acontecer até surgirem dois passeios que unirão por amizade alguns personagens e ainda dois noivados. Mas somente o segundo passeio, uma excursão de barco no grande rio (Amazonas?) encaminhará a história para um desfecho doloroso e emocionante. São essas as páginas finais e mais contundentes do romance.
Os temas relevantes perpassam o livro até nas entrelinhas: a crítica à necessidade de casamento para as mulheres; à ocupação levada a sério com tricôs e bordados, frivolidades condenadas por uma autora que também foi criada segundo as rígidas regras vitorianas; crítica sobretudo à diferença da educação oferecida às mulheres, quase todas gatas
até a admirável Mrs. Dalloway, que tinha o dobro da inteligência do importante marido. A funcionária Mrs. Chaney, por exemplo, “lidava com os lençóis como se conhecesse cada um deles por nome, sobrenome, caráter e constituição”, ironiza o narrador. Uma Inglaterra onde as mulheres ainda não tinham direito ao voto e todos se orgulhavam de seu vasto império na Índia e África; um país também de mulheres trabalhadoras, casadas ou descasadas criando seus filhos, mesmo assim tratadas como invisíveis, sem nada dizer sobre si mesmas, como viviam ou o que sentiam, pois delas nada se esperava; e homens como o político Richard Dalloway que considerava necessário manter as mulheres na ignorância, longe da política, sem voz nem voto, sem direito de

DIREÇÃO GERAL: César Santos DIRETOR DE REDAÇÃO: César Santos
GERENTE ADMINISTRATIVA: Ângela Karina
DEP. DE ASSINATURAS: Alvanir Carlos
música, brincando com as crianças e cumprindo seus deveres domésticos.” (p. 107).
Diz o personagem Hewet a Rachel:
– O respeito que as mulheres, mesmo as instruídas, mulheres muito capazes, sentem pelos homens – prosseguiu ele –, deve ser o tipo de poder que dizem que temos sobre cavalos. Eles nos enxergam três vezes maiores do que somos, senão nunca nos obedeceriam. Por isso mesmo tendo a duvidar de que vocês mulheres jamais venham a fazer qualquer coisa quando tiverem o direito ao voto. (p. 315)
E disse muito mais e pior. E, refletindo, a ingênua Rachel iniciava
a sua educação civil.
Percebemos grande semelhança entre Virginia Woolf e Clarice Lispector nesse livro, sobretudo na sensibilidade da composição das personagens femininas e na captura do clima da cena, na delicadeza, como no exemplo a seguir em que Rachel está sozinha na sala, na villa de Santa Marina:

A manhã estava quente, e o exercício de ler deixara sua mente contraindo-se e expandindo-se como a mola principal do relógio. Os sons do jardim lá fora uniram-se aos relógios e aos pequenos rumores do meio-dia, que não se podem atribuir a nenhuma causa definida, todos num ritmo regular. Era tudo muito real, muito grande, muito impessoal, e depois de um ou dois momentos ela começou a erguer o dedo indicador e deixálo cair sobre o braço da cadeira como se trouxesse de volta alguma consciência de sua própria existência. Em seguida foi tomada pela estranheza indizível com relação ao fato de estar sentada na poltrona, de manhã, no meio do mundo. (p. 194).
Nesse primeiro romance já se manifesta o gosto de Virginia Woolf por imagens, como a passagem das horas e do vai e vem das ondas, que serão recorrentes nas obras seguintes, como no poético, genial e de difícil leitura As ondas (1931), considerado talvez o mais experimental de seus livros, depois do impressionista O quarto de Jacob (1922), e ainda o surpreendente e histórico Orlando (1928). A fluidez da onda que vem e passa, se repete e se sucede, vai ao encontro do conceito de inconsciente de Freud, que ela só leu mais tarde em Moisés e o Monoteísmo ao escrever sua última obra Entre os Atos , pouco antes de seu suicídio em 1941. Há, no entanto, registro da escritora Maud Mannoni de que ela dialogou, sim, com o pai da psicanálise, por meio de várias obras, não somente dele, Freud, como também da psicanalista Melanie Klein. Mas Freud não leu Virginia Woolf. Não teve tempo.
Assim, não mais suportando o sofrimento psíquico e aterrorizada ante a possibilidade de perder o controle sobre si mesma, entrou no rio que a levou para sempre. Não sem deixar metaforicamente o seu protesto pelo peso da vida: encheu os bolsos de pedras e, com seu desespero e pulsão de morte, seguiu andando vagarosamente com as ondas para o fundo escuro do Ouse em sua última viagem – sem o barqueiro Caronte e sem volta. Nem a paixão pela escrita, que salvou Joyce da loucura, foi capaz de salvá-la. Foi como aquele navio solitário, avançando, com coragem, para o desconhecido.
Um importante passo para a consolidação do Rio Grande do Norte como um polo de investimentos no Brasil e no mundo. Estamos trabalhando para garantir um futuro próspero e sustentável para o nosso estado e para o nosso povo”.
Foi assim que a governadora Fátima Bezerra (PT) definiu as parcerias firmadas pelo Governo do Rio Grande do Norte com empresas chinesas em missão realizada no país asiático entre os dias 11 e 19 de abril.
A governadora e a comitiva potiguar se reuniram com representantes de importantes empresas chinesas, como a China Communications Construction Company (CCCC), a State Grid e a Kerui, para apresentar as potencialidades do RN e buscar parcerias que possam impulsionar o desenvolvimento econômico do estado, além de tratar de temas importantes como agricultura familiar, mineração e gemas.

Em menos de 24 horas após a apresentação do projeto do Porto-Indústria Verde do Rio Grande do Norte, feita pela comitiva potiguar, a CCCC oficializou o pedido de acesso ao estudo de viabilidade e detalhes do processo. A empresa informou que enviará técnicos para aprofundar os detalhes do projeto em maio. A CCCC tem atuação em 159 países e construiu sete dos dez maiores portos do mundo.
O Porto-Indústria Verde é pensado para servir como apoio à indústria das energias renováveis, fabricação e montagem de equipamentos e exportação, bem como para a produção de hidrogênio e amônia verde.
eN ergia eóli C a Já a State Grid, que possui 15 mil km de linhas de transmissão no Brasil e é pioneira na instalação e operação de parques eólicos no
Na ChiNa
Rio Grande do Norte, comunicou que participará dos dois leilões do governo federal para novas linhas de transmissão. Uma delas atende o estado, com capacidade de transmitir 500gw.
A comitiva potiguar afirmou à empresa que o Rio Grande do Norte está preparado para expandir sua matriz energética com a uti-
lização de fontes como o offshore e o hidrogênio verde. O governo estadual está comprometido em assumir o papel de liderança na produção de energia renovável, tendo em vista que o estado já completou uma década na vanguarda da produção de energia eólica no Brasil. A meta é assumir a dianteira na próxima fase de transfor-
Para o secretário da Sedraf, Alexandre Lima, a pauta relacionada à agricultura familiar foi muito positiva para o estado. “Foi uma visita que deu uma visão muito boa da realidade da mecanização da agricultura familiar da China e atendeu perfeitamente todas as nossas expectativas. Primeiro porque nós pudemos ver no local os equipamentos sendo fabricados e ampliar o diálogo com as fábricas. Segundo porque serviu para aprofundar a articulação com a Universidade Agrícola da China”.
A agenda é um desdobramento do Acordo de Cooperação firmado entre o Consórcio Nordeste, representando os nove estados da região, e a China em setembro de 2022, visando a Mecanização Agrícola na Agricultura Familiar com maquinários desenvolvidos no país oriental.
Segundo Alexandre, a expectativa é que o maquinário chegue ao Rio Grande do Norte no segundo semestre desse ano para serem testados e validados.
“Com isso será possível realmente a gente dar passos importantes para viabilizar
a utilização desse maquinário no processo de tecnificação e modernização da agricultura familiar do Rio Grande do Norte e do Nordeste. E o Rio Grande do Norte será certamente um dos protagonistas desse processo de mecanização da agricultura familiar”, avaliou o secretário da Sedraf.
A cooperação com a China visa superar o baixo índice de mecanização agrícola na agricultura familiar, especialmente do Nordeste, onde, segundo o IBGE (2017), somente 2,3% da agricultura familiar possui mecanização;
mações energéticas, por meio da produção de hidrogênio verde.
Petróleo e gás
A Kerui, maior empresa de petróleo e gás da China, também se reuniu com a governadora e anunciou investimento de 500 milhões de dólares no Brasil, sendo 60% desse valor
0,5% das propriedades nordestinas possuem algum tipo de equipamento para semear e só 0,2 % utilizam algum tipo de equipamento para colher o que produzem.
A Universidade Agrícola da China (CAU) possui dois mil professores, 25 mil alunos e monitora a utilização de mais de um milhão de máquinas utilizadas naquele país por agricultores familiares. Estudos apontam que a mecanização promove aumento de 15% na produção e redução de 30% na emissão de carbono.
destinado ao estado do Rio Grande do Norte. A empresa planeja instalar um escritório em Mossoró e construir uma planta de gás natural.
A empresa foi a primeira companhia privada chinesa a obter um contrato de infraestrutura com a Petrobras.
Em 2018, fechou contrato para construção de uma Uni-
dade de Processamento de Gás Natural (UPGN) no Complexo Petroquímico do Rio de Janeiro (Comperj), em parceria com a empresa brasileira Método Potencial, que é o maior projeto de tratamento de gás natural do Brasil e representa investimento de aproximadamente US$ 600 milhões de dólares.
Outro destaque da visita foi a parceria para instalação de um laboratório de gemas, que funcionará no IFRN do município de Currais Novos. A governadora Fátima Bezerra esteve no Instituto de Recursos Minerais da Academia Chinesa de Ciências Geológicas (CAGS), com o vice-presidente Yan Chengyi, onde assinou um acordo de cooperação que irá trazer avanços na implantação do Laboratório de Certificação de Gemas no Rio Grande do Norte.
“Este é um passo importante para a mineração, especialmente para as pedras preciosas que são extraídas do estado”, afirma Jaime Calado, secretário do Desenvol-
vimento Econômico do RN.
O instituto geológico da China participará com treinamento e outros recursos. Além disso, a senadora Zenaide Maia destinará emendas no valor de dois milhões de dólares para equipamentos. A expectativa é que a iniciativa possa quadruplicar o valor dos minerais e pedras preciosas da região.
A criação do laboratório de gemas, previsto para ser integrado às instalações do Centro de Tecnologia Mineral do IFRN, em Currais Novos, irá abrir o mercado internacional para os produtores de pedras preciosas do Brasil, com foco principal na China e Ásia e potencial para atingir outras partes do mundo.
Oministro Alexandre de Moraes, do Supremo Tribunal Federal (STF), determinou a quebra do sigilo das imagens do Gabinete de Segurança Institucional (GSI) captadas durante a invasão do Palácio do Planalto em 8 de janeiro. Com a decisão, todas as gravações deverão ser enviadas para investigação que está em andamento da Corte.
A determinação foi tomada após a gestão interina do GSI informar ao Supremo que uma sindicância foi aberta em 26 de janeiro pelo órgão para apurar a conduta de agentes que estavam em serviço, mas as imagens da ação dos vândalos não foram divulgadas em função do sigilo da investigação.
Na mesma decisão, Moraes também mandou que a Polícia Federal (PF) realize o depoimento de todos os funcionários do GSI que foram identificados após gravações divulgadas pela CNN Brasil mostrarem o ex-ministro do GSI Gonçalves Dias e outros servidores no interior do Palácio do Planalto durante os atos golpistas.
Na decisão, o ministro afirmou que já havia determinado que todas as imagens da invasão deveriam ser anexadas à investigação dos atos que tramita no Supremo.
responsAbilidAde Para Moraes, as gravações são necessárias para apurar a responsabilidade criminal dos envolvidos.
“Portanto, inexiste sigilo das imagens, com base na Lei de Acesso à Informação, sobretudo por serem absolutamente necessárias à tutela jurisdicional dos direitos fundamentais, ao regime democrático e republicano, que foram covardemente desrespeitados no ataque criminoso à nossa democracia, no dia 8/1/2023”, escreveu o ministro.
8 de jAneiro
>> Imagens da ação dos vândalos no Distrito Federal não foram divulgadas em função do sigilo da investigação
Determinação foi tomada após a gestão interina do GSI informar ao Supremo que uma sindicância foi aberta em 26 de janeiro pelo órgão para apurar a conduta de agentes
Alexandre de Moraes ressaltou que a investigação sobre os atos golpistas também apura as responsabilidades de agentes civis e militares que foram coni -

ventes com os atos.
“A investigação dos atos golpistas não está restrita somente aos indivíduos e agentes públicos civis e militares que criminosamente
pretenderam causar ruptura do Estado Democrático de Direito, na tentativa de violação de direitos fundamentais e na separação de poderes, mas, também, na
STF vai tornar 100 envolvidos em réus nos atos de 8 de janeiro
O Supremo Tribunal Federal (STF) formou o placar de oito votos a zero a favor do recebimento das denúncias contra 100 envolvidos nos atos golpistas de 8 de janeiro deste ano. Na ocasião, vândalos depredaram os edifícios do STF, do Congresso Nacional e do Palácio do Planalto.
O julgamento virtual começou na madrugada de terça-feira, 18, e será finalizado na próxima segundafeira, 24. Na modalidade virtual, os ministros inserem seus votos no sistema eletrônico e não há deliberação presencial.
Até o momento, além do relator, ministro Alexandre
de Moraes, votaram pelo recebimento das denúncias feitas pela ProcuradoriaGeral da República (PGR) os ministros Dias Toffoli, Edson Fachin, Gilmar Mendes, Luís Roberto Barroso, Cármen Lúcia, Luiz Fux e a presidente, Rosa Weber.
Até o fechamento desta edição faltavam os votos de André Mendonça e Nunes Marques. Em função da aposentadoria de Ricardo Lewandowski, somente dez ministros votam no julgamento.
Ação penAl
Ao final do julgamento, os acusados passarão a responder a uma ação penal e
se tornam réus no processo. Em seguida, Moraes deverá analisar a manutenção da prisão dos acusados que ainda permanecem detidos.
Conforme levantamento do STF, das 1,4 mil pessoas presas no dia dos ataques, 294 (86 mulheres e 208 homens) permanecem no sistema penitenciário do Distrito Federal. As demais foram soltas por não representarem mais riscos à sociedade e às investigações.
Na próxima segunda-feira, 24, o Supremo vai julgar as denúncias contra mais 200 investigados. No total, a PGR denunciou 1,3 mil acusados ao Supremo.
identificação e responsabilização das condutas de todos aqueles, inclusive de agentes públicos civis e militares, que, durante a consumação das infrações pe-
nais do dia 8/1 ou, posteriormente, comissiva ou omissivamente, foram coniventes ou deixaram de exercer suas atribuições legais”, concluiu.
Partido Novo pede à PGR abertura de investigação
O Partido Novo pediu à Procuradoria-Geral da República (PGR) a abertura de uma investigação criminal sobre a conduta do g eneral da reserva Marco Gonçalves Dias, o G. Dias, ex-chefe do Gabinete de Segurança Institucional (GSI) do governo Luiz Inácio Lula da Silva (PT), no dia 8 de janeiro.
O Diretório Nacional afirma que o general deve ser denunciado pelo crime de prevaricaçãoquando um servidor age movido por “interesse ou sentimento pessoal”.
“O ex-ministro atuou de maneira condescendente com os atos de van-
dalismo e de depredação do patrimônio público, inclusive conduzindo os invasores a outros locais ou à saída de alguns locais do Palácio do Planalto”, diz um trecho da representação do Novo.
Gonçalves Dias pediu exoneração depois de a CNN divulgar imagens que mostram que ele estava no Palácio do Planalto no dia da invasão. O vídeo registra o general circulando no andar do gabinete presidencial e indicando a saída do prédio aos invasores. Na quinta-feira, 20, ele prestou esclarecimentos à Polícia Federal.
cesar@defato.com
Arelação política entre Allyson Bezerra e Lawrence Amorim está na pauta do dia. As especulações apontam para um estremecimento que pode levar o prefeito e o presidente da Câmara de Mossoró para caminhos opostos à sucessão municipal 2024. Os dois negam.
De fato, há um conflito de projetos de ambos. Lawrence deseja ser o vice de Allyson nas próximas eleições; Allyson não o quer como vice. Isso implica em divórcio político? Não necessariamente, mas, também não pode ser descartado.
O que temos no momento é de simples entendimento: Lawrence trabalha para viabilizar o nome em chapa majoritária; Allyson procura dificultar a mobilidade política de Lawrence para evitá-lo como vice em 2024.
A luta pela construção do santuário de Santa Luzia é um recorte dessa “disputa”. Lawrence assumiu o projeto que pode lhe
render novo patamar de popularidade. A ideia foi abraçada pela imensa comunidade católica e por tantos outros segmentos da sociedade, inclusive, considerável parcela da classe política.
A audiência pública, liderada pelo presidente da Câmara, fortaleceu o processo. Atenderam ao chamamento de Lawrence representantes da Assembleia Legislativa, da bancada federal potiguar, do Governo do Estado, das universidades, classe empresarial e, principalmente, de autoridades da Igreja Católica, com destaque para a referência que é o padre educador Sátiro Cavalcanti Dantas.
A luta pelo santuário de Santa Luzia carimba o mandato de Lawrence com selo de qualidade. Por gravidade, eleva o seu patamar no tabuleiro da sucessão municipal. Os mais açodados chegam a cogitar a possibilidade de uma candidatura a prefeito, o que não é alimentado pelo líder do Legislativo. Pelo menos, até aqui, não. Esse movimento de Lawrence é parecido, guardadas as devidas proporções, com a luta da ex-prefeita Cláudia Regina na sucessão municipal de 2012. Ela não era o nome desejado pelo grupo político da então governadora Rosalba Ciarlini, mas se viabilizou a tal
laWrENCE aMOriM Presidente da Câmara Municipal de Mossoró
A fruticultura do RN gera mais de 20 mil empregos diretos, com concentração maior na região de Mossoró, com destaque para o melão. Esse potencial será apresentado na Expofruit 2023, que chega a 30 anos. Trata-se da maior feita de fruticultura da América Latina, devendo reunir investidores de várias partes do mundo. A Expofruit será realizada entre os dias 23 e 25 de agosto.
Mesmo com parte de setores produtivos afetados pelos ataques criminosos em março, a economia potiguar deu resposta positiva em março. O varejo movimentou mais de R$ 3,4 bilhões, um incremento de 14% em relação ao mesmo mês em 2022. O estado registrou R$ 667 milhões em receitas próprias, um crescimento de 5,4% no comparativo com o mesmo mês do ano passado.
ponto que o rosalbismo teve que apoiá-la. Cláudia foi buscar nas bases a força que precisava para ser a “candidata de Rosalba”.
Pois bem.
Lawrence Amorim não deseja romper politicamente com Allyson Bezerra. Ele quer ser o candidato a vice-prefeito na chapa de Allyson. É um direito natural. Ademais, o presidente da Câmara não se oferece como um “peso”, mas, sim, como um nome que pode somar.
Allyson Bezerra também não quer romper a relação política com Lawrence. Ele deseja ter o apoio do presidente da Câmara, mas não como o seu candidato a vice. O prefeito sabe da importância de Lawrence, da força que o presidente da Câmara tem, e é exatamente isso que o incomoda.
No projeto político de Allyson, ele quer um vice de sua extrema confiança. O prefeito tem a convicção de que se renovar o mandato em 2024, será candidato a governador do RN dois anos depois, em 2026. Para isso, terá que renunciar a Prefeitura de Mossoró; é aí que ele precisa de um vice de dentro de casa para ocupar o cargo, para continuar mandando na gestão municipal.
Allyson tem um nome escolhido. Hoje, não é Lawrence. Amanhã, quem sabe...
lUTO
Morreu dona Brasília Fernandes Rodrigues, aos 94 anos. Era viúva de Francisco Obery Rodrigues, falecido há um ano. Casal do benquerer dos mossoronses, que teve 11 filhos, entre eles, o amigo Obery Rodrigues, exsecretário do Planejamento de Mossoró e do RN.
JUDiCialiZaDO
Termina na quinta-feira, 27, o prazo para o prefeito Allyson Bezerra responder à Justiça se aceita audiência de conciliação com os professores. Até aqui, a resposta é "não". Allyson transformou a luta dos professores pelo novo piso salarial em questão pessoal. Ele decidiu zero por centro de reajuste. E não abre mão disso.
JUDiCialiZaDO ii
Nesta data, em 1999, a comunidade rural de Riacho Grande ganhava o sistema de distribuição de água com a construção de um sistema adutor. Obra da segunda gestão da prefeita Rosalba.
A Unidade Básica de Saúde do bairro Lagoa do Mato foi inaugurada num dia como este, em 2004. Recebeu o nome de UBS José Fernandes de Melo, líder político de Pau dos Ferros. Obra da terceira gestão da ex-prefeita de Mossoró Rosalba Ciarlini.
O publicitário Rilder Medeiros confirma a edição 2023 da Feira do Livro de Mossoró para os dias 2 a 5 de agosto, no campus central da Uern. A reitora Cicília Maia garantiu apoio total ao evento.
Pe lo andar da carruagem o PT potiguar vai ter que engolir os bolsonaristas Getúlio Batista (PTB) no comando do Dnit-RN e Ivan Júnior (União) na direção da Codevasf. Do Planalto, chega à mensagem que os interesses de Brasília são maiores do que o RN.

A governadora Fátima Bezerra (PT) garante o apoio para a segurança do Mossoró Cidade Junina. O evento terá toda a estrutura do Estado para assegurar tranquilidade aos mossoroenses e visitantes. Na edição 2022, o governo investiu R$ 600 mil.
O Sindiserpum já avisou que os professores vão cobrar o pagamento do novo piso salarial na Justiça. A ação será oferecida ao Tribunal de Justiça do RN, tão logo se encerre o prazo dado pelo desembargador Vivaldo Pinheiro para o prefeito se manifestar sobre a conciliação.
CObiÇaDa
O Tribunal de Justiça do RN abre nesta segunda-feira, 24, inscrições para o cargo de membro titular da classe jurista. Os advogados e advogadas vão disputar a vaga ocupada por Adriana Magalhães Faustino, que conclui o mandato em julho. O cargo é bastante cobiçado pela turma da carteira da Ordem.
Durante sua visita a Portugal neste sábado, 22, o presidente Luiz Inácio Lula da Silva (PT) disse que decidirá sobre o futuro do Gabinete de Segurança Institucional (GSI) quando voltar ao Brasil e que a decisão sobre uma Comissão Parlamentar Mista de Inquérito (CPMI) é do Congresso Nacional.

“Eu não decido sobre CPI. É por conta do Congresso Nacional, que decide quando quiser decidir e faz o que quiser fazer. O presidente não vota no Congresso Nacional, eu não voto no Senado e não voto na Câmara”, disse. “E o GSI, quando eu voltar vou tomar a decisão que achar mais importante para o Brasil.”
Em coletiva de imprensa conjunta com o presi -
dente do país, Marcelo Rebelo de Sousa, Lula foi questionado se o GSI deve continuar existindo e se considerava necessária a CPMI para investigar os atos criminosos do 8 de janeiro.
Antes de responder, ele disse não gostaria de perguntas referentes à política interna brasileira neste momento. “Perguntas sobre o Brasil seria bom se fossem feitas para mim
quando eu voltar ao Brasil. Ficar respondendo per-
guntas de problemas internos não é muito justo para quem está ouvindo aqui”, falou antes de responder.
lula diz que CPi de 8/1 é decisão do Congresso Nacional
É NOTÍCia Não estamos vendendo ilusões, mas o santuário de Santa Luzia é viável”Por CNN l ula fez declaração durante coletiva de imprensa conjunta com o presidente de Portugal, Marcelo rebelo de s ousa Assessoria
>> Com o novo trabalho, os pesquisadores ampliaram os pontos de observação em todo o r io Grande do Norte
crispinianoneto@gmail.com
Muito lúcida a postagem da Rede Marco de comunicação e informação: Muito gra ve! o bolsonarista Campos Neto desafia Rodrigo Pacheco, presidente do Senado que é a instituição que referenda escolha do presidente do Banco Central depois da independência. A arrogância desse bolsonarista não tem limites.
Depois de mandar recados pro presidente da República, maior autoridade do país, de que não iria baixar as taxas de juros e que ainda as poderia elevar, Campos Neto “desafiou” o Rodrigo Pacheco.
Apesar de ter ouvido o apelo do presidente do Senado para baixar as taxas de juros, voltou a afirmar ontem, em Londres, que não fará em curto prazo alegando que só 20% do crédito são ligados à Selic, e o restante está relacionado a taxas longas que nada têm a ver com os juros definidos pelo BC.
É uma canalhice porque o efeito é cascata. A taxa Selic é o parâmetro para todas as demais aplicadas pelos bancos e que estão sufocando a economia. Isso é o combinado com Jair Bolsonaro: não deixar o governo Lula crescer.
açude Gargalheiras, no município de acari, faz parte do patrimônio geológico do rio Grande do norte
 por Vilma Torres Secom uFrN
por Vilma Torres Secom uFrN
Pela primeira vez, um grupo de pesquisadores da Universidade Federal do Rio Grande do Norte (UFRN) sistematizou o inventário do patrimônio geológico do estado. Antes do projeto, alguns Locais de Interesse Geológico (LIGs) já haviam sido identificados, contudo sem uma sistematização ou mesmo critérios para identificação. A falta de organização das publicações impedia a caracterização das informações anteriores como um inventário propriamente dito.
Nos pontos listados anteriormente pela Comissão Brasileira de Sítios Geológicos e Paleontológicos, apareciam o Pico do Cabugi, o Lajedo de Soledade e o Atol das Rocas. Somados a eles também havia LIGs mapeados durante os trabalhos para o inventário do patrimônio geológico no território do Projeto Geoparque Seridó.
Com o novo trabalho, os pesquisadores ampliaram os pontos de observação em todo o RN e chegaram a 150 novos locais. A equipe que organizou o inventário é formada pelos pesquisadores do Pibic-CNPq Marília Cristina Santos Souza Dias, Filipe Freire Alencar, Ítalo Mendonça Nascimento Barbalho e pelo professor Marcos Antonio Leite do Nascimento, do Departamento de Geologia (CCET/UFRN).
O resultado da pesquisa e os lugares apontados como novos LIGs, foram publicados recentemente no artigo Inventory of the Geological Heritage of the State of Rio Grande do Norte, NE of Brazil, em uma das melhores revistas internacionais sobre patrimônio geológico, a Geoheritage.
O professor Marcos Nascimento diz que, com o levantamento feito para o inventário, é possível apontar usos práticos para as novas informações. “Dois principais usos podem ser destacados. Um deles são as práticas turísticas como novos

atrativos, principalmente para o uso geoturístico, e o outro apoiado em práticas educativas, sendo usados para popularização do conhecimento geocientífico nos ensinos fundamental, médio e superior”, explica.
Durante o levantamento, os pesquisadores contam ter ficado admirados com alguns pontos que se mostram frequentemente usados, seja de maneira científica, educativa ou turística, como os diques de diabásios do Rio Salgado, o calcário do Lajedo de Soledade e as calcissilicáticas da Mina Brejuí.
Trabalho sem fim
Um inventário, como brinca Marcos, nunca acaba de ser feito, apenas é interrompido. Isso porque, com o passar das estações, novos locais de interesse geológico podem ser descobertos e alguns existentes podem ser destruídos ou até mesmo descaracterizados. Por isso que todo inventário deve ser revisado de tempos em tempos.
O artigo da Geoheritage diz que as rochas são capazes de contar a história de um território. Então, o que as rochas potiguares contam sobre a nossa história? Marcos responde:

“Ler o que tem numa rocha não é simples e nem fácil, mas nós geólogos estamos preparados para fazer essa leitura. O estado do Rio Grande do Norte apresenta um dos mais
completos e belos patrimônios geológicos encontrados no Nordeste brasileiro e talvez no Brasil. Esses são decorrentes dos inúmeros processos naturais a que este estado foi submetido ao longo do Tempo Geológico”. No Rio Grande do Norte, existe uma diversidade de rochas constituindo exemplares científico-didáticos-turísticos. No esta-
do, temos rochas metamórficas que falam de um passado bem distante, com cerca de 3,6 bilhões de anos, sendo consideradas as rochas mais antigas da América do Sul. Aqui também encontramos rochas vulcânicas de 130 milhões de anos que mostram a separação dos continentes sul-americano e africano.
E não apenas isso: no RN, rochas sedimentares
O artigo da Geoheritage também ressalta as ameaças contra os afloramentos – em Geologia, um afloramento é qualquer exposição de camada, veio ou rocha na superfície do terreno – e sugere que a situação exige ações urgentes de manejo.
Segundo a pesquisa, as principais ameaças associadas aos LIGs são a incapacidade das autoridades em identificar, proteger e gerir esses locais; a falta de monitoramento; a inexistência de contato com os proprietários dos locais e seus potenciais utilizadores; o mau uso ou a destruição intencional e a falta de conhecimento sobre a existência desses locais.
Este último problema é indicado pelo professor como o mais danoso. “Acredito que a principal atitude a ser tomada é considerada a primeira de todas: é a produção do inventário, pois com ele teremos a real noção de quais são os LIGs e com isso podemos trabalhar diferentes ações que venham mitigar os impactos sobre eles”, diz Marcos.
acumulam petróleo e gás em profundidade e estão presentes em falésias no litoral, junto com sedimentos de dunas expostas ao longo das praias potiguares.
Além disso, destacam os pesquisadores, as terras potiguares têm sítios arqueológicos com inúmeras pinturas e gravuras esculpidas em rochas, bem como sítios paleontológicos com fósseis de diferentes idades.
Gol conTra
Tremendo gol contra tem se mostrado essa insistência das opsiçoes de extrema direita exigindo uma CPMI para investigar os atos terroristas de 8 de janeiro. Finalmente, o PT e o governo aceitaram a CPMI, mas como o governo tem maioria, vai ter a presidência e a relatoria. Isto significa dizer que com essas duas posições estratégicas e com os melhores debatedores e a razão em cima dos fatos, a oposição será massacrada na CPMI e o bolsonarismo será responsabilizado pela tragédia golpista de 8 de janeiro.
direiTa liderada pela esquerda?
Léo Índio, primo e amigo íntimo de Carlos Bolsonaro, a esposa do General Villas Boas presentes e fazendo fotos e vídeos, Magno Malta incentivando “atos duros” naquele dia 8 de janeiro, igrejas evangélicas ligadas a pastores fascistas e empresas de ônibus viajando quase de graça para derrubar o presidente Lula... E ainda tem quem diga que aqueles vândalos terroristas que estavam bagunçando os símbolos da democracia eram incentivados pelo PT. Que bom que vai ter a CPMI! Como que a extrema direita estaria sendo liderada pela esquerda, que a oposição estava sendo dirigida pelo governo? O problema dos direitistas é que eles são imbecis e acham que todo mundo é.
rápido balançlo da quinzena de lula
1- Conseguiu R$ 50 bilhões em investimentos da China;
2- Mais R$ 12 bilhões nos Emirados Árabes; 3 - Mais R$
2,5 bilhões dos EEUU 4 - Conseguiu acordo com a Shein pra gerar 100 mil empregos diretos. 5 - Ainda falta Portugal e Espanha.
finalmente, a verdade pura e simples. O general Gonçalves Dias, em seu depoimento à Polícia teria dito que o responsável pela bagunça golpista de 8 de janeiro é o general Heleno Augusto, seu antecessor no comando do GSI. Disse que o ‘ex’ continua tendo agentes infiltrados ali. E que ainda hoje os tem.
Mais Médicos
>> Profissionais vão ser destacados para atuar em 28 municípios do estado; no país serão contratados 6.252 médicos e médicas Reprodução
ORio Grande do Norte tem 74 vagas reservadas pelo Edital n º 4 do programa Mais Médicos, publicado nesta semana no Diário Oficial da União. Segundo o documento, as vagas miram a atuação em 28 municípios do estado.
O edital prevê a adesão ou renovação de municípios e do Distrito Federal no programa e reserva 6.252 vagas para serem preenchidas em 2.074 municípios, das 27 Unidades da Federação, para atuação pelo período de quatro anos incluindo mil postos inéditos para a Amazônia Legal.
No Nordeste, lideram a lista os estados do Ceará, com 330 vagas, Bahia (303), Maranhão (263) e Pernambuco (173).
Os 28 municípios do Rio Grande do Norte previstos no edital do Mais Médicos devem receber pelo menos um profissional nesta fase do programa. Desses, quatro cidades têm no mínimo três vagas reservadas. A capital Natal lidera, com 32 vagas. Em seguida, aparece o município de Nova Cruz, com seis vagas. A lista prossegue com Macaíba (cinco) e Mossoró (três vagas).
r eG iões
No recorte regional, a
Médicos e médicas devem ocupar vagas em áreas mais necessitadas dos estados
Região Sudeste detém o maior número de vagas do país, com 1.848 profissionais voltados para 497 mu-
nicípios. A Região Norte reúne 1.539 vagas destacadas para atuação em 294 cidades.
Para atender as regiões que mais precisam, o Mais Médicos utiliza critérios na distribuição das vagas, como a situação de vulnerabilidade social, maior dependência do SUS para o acesso da população à saúde e dificuldade de provimento de profissionais.
Neste edital, 47% das vagas foram destinados a regiões de alta vulnerabilidade social, com 1.118 postos destinados a municípios de extrema pobreza e 1.857 para contemplar a categoria alta e muito alta de vulnerabilidade. Outras 666 vagas (10,6%) estão indicadas para municípios do G100, as cidades com mais de 100 mil habitantes e baixo rendimento per capita.
Segundo um levantamento realizado pelo Ministério da Saúde, 41% dos participantes do Mais Médicos desistem em busca de capacitação e qualificação. Desta forma, um dos desafios no atendimento às regiões de mais difícil acesso é justamente a permanência.
Para reduzir essa rotatividade, o Mais Médicos traz mais oportunidades educacionais e de formação. O médico que participa do programa pode fazer especialização e mestrado em até quatro anos. Os profissionais também passam a receber benefícios, proporcionais ao valor mensal da bolsa, para atuarem em periferias e regiões remotas.
O Mais Médicos também
pretende atrair profissionais formados com apoio do Governo Federal. Os beneficiados pelo Financiamento ao Estudante do Ensino Superior (FIES) que participarem do programa poderão receber incentivos, o que ajudará no pagamento da dívida.
Para apoiar a continuidade das médicas mulheres no programa também será feita uma compensação, de modo a atingir o mesmo valor da bolsa durante o período de seis meses de licença maternidade, complementando o auxílio do INSS. Para os participantes do programa que se tornarem pais, será garantida licença com manutenção de 20 dias.
Na região Nordeste, são 1.346 vagas e 641 municípios.
A Região Sul concentra
e stado
De acordo com o edital, oito estados têm previsão de receber mais de 300 vagas do programa. São eles: São Paulo (1.043), Pará (644), Rio Grande do Sul (552), Amazonas (478), Minas Gerais (402), Paraná (338), Ceará (330) e Bahia (303).
1.114 vagas em 481 localidades e a Centro-Oeste, 405 vagas para 161 cidades.
Na esfera dos municípios atendidos, Manaus (AM) detém o maior número de vagas. Para a capital do Amazonas estão previstos 256 profissionais. São Paulo aparece na sequência, com 150 vagas. Na lista das dez cidades com mais vagas ainda aparecem Boa Vista (RR), com 134; Fortaleza (CE), com 91; Rio de Janeiro (EM), com 79; Porto Alegre (RS), com 67; Belém (PA), com 62; Brasília (DF), com 52; Campinas (SP), com 47; e Macapá (AP), com 37.
Bolsas para médicos têm valor de R$ 12,8 mil
Retomado oficialmente em março deste ano, o Mais Médicos prevê a abertura de 15 mil novas vagas até o fim deste ano. A meta é chegar a 28 mil profissionais em todo o país, levando-se em conta os contratos ainda ativos, com presença principalmente em áreas de extrema pobreza. As bolsas são de cerca de R$ 12,8 mil, acrescidas de ajuda de custo de moradia.
O objetivo é permitir que 96 milhões de brasileiros tenham garantia de atendimento médico na atenção primária, a porta de entrada do Sistema Único de Saúde (SUS). Com atuação nas unidades básicas, esse primeiro
atendimento faz o acompanhamento da situação de saúde da população, prevenção e redução de agravos. O investimento previsto por parte do Governo Federal é de R$ 712 milhões neste ano.
“Um dos mais importantes méritos do Mais Médicos é a prioridade para a formação no SUS, no trabalho das unidades básicas, pois é no cotidiano dos serviços de saúde que são vividos os problemas e construídas soluções, através de um processo de aprendizado permanente”, destaca a ministra da Saúde, Nísia Trindade.
A prioridade no Mais Médicos é para profissio-

nais formados no Brasil. Se sobrarem vagas, podem ser acionados brasileiros formados no exterior. Se ainda assim não forem preenchidos todos os postos, haverá espaço para médicos estrangeiros estabelecidos no Brasil e, por último, para médicos estrangeiros.
“O novo Mais Médicos vem com um conjunto de medidas e vantagens para estimular médicos formados no Brasil a atuarem na atenção básica e se especializarem durante um período de atuação neste nível de atenção”, afirma o secretário de Atenção Primária à Saúde do Ministério da Saúde, Nésio Fernandes.


“O Jornal de Fato é um importante veículo de comunicação do Rio Grande do Norte que se destaca por sua atuação cidadã e comprometimento com questões sociais e ambientais.
Um exemplo disso foi a publicação de reportagem especial falando sobre o projeto Lixo Zero no CEEP, o encontro de Lixo Zero de melhores práticas em Mossoró e a Semana Lixo Zero 2022.
Essas iniciativas demonstram o comprometimento do Jornal de Fato em informar e sensibilizar a população sobre a importância da gestão adequada dos resíduos e como a filosofia lixo zero pode contribuir para o desenvolvimento sustentável das cidades.



Essa atitude reflete o compromisso do Jornal de Fato em incentivar a participação da sociedade na construção de um mundo mais justo.
Diante disso, o Jornal de Fato é merecedor do título “Atitude Cidadã” do Instituto Lixo Zero Brasil, pois tem sido um importante agente de transformação social e ambiental em sua comunidade.”





Instituto Lixo Zero Brasil.

O evento movimenta a economia local, beneficiando a rede hoteleira, comerciantes formais e informais
aM ina Costa da redação
Com o lançamento da programação completa do Mossoró Cidade Junina (MCJ) deste ano de 2023, feito pela Prefeitura de Mossoró, nesta semana, os mossoroenses já estão na expectativa para o evento, que a cada ano vem ganhando destaque entre as cidades com tradição na realização do São João. Com atrações de destaque nacional e regional, a edição deste ano traz formato parecido com a do ano passado, mas com algumas alterações.
A realização de um evento deste porte é fundamental para a economia do município, beneficiando desde a costureira até a rede hoteleira, passando por vendedores ambulantes, flanelinhas, comércio de rua e shoppings. De acordo com dados da Câmara dos Dirigentes Lojistas (CDL) de Mossoró, desde que o formato do MCJ 2023 foi apresentado aos mossoroenses, no final de fevereiro, a rede hoteleira da cidade apresentou aumento na busca por diárias.

Especialmente para o
cial e um bem econômico ao município”, salientou o professor Leovigildo Cavalcanti, que coordenou a pesquisa.
divulgação
edição 2023 do Mossoró Cidade Junina foi lançada para o trade turístico do rio Grande do norte na quinta-feira
Pingo da Mei Dia, evento que abre o São João de Mossoró no dia 3 de junho, alguns hotéis e pousadas da cidade não têm mais vagas disponíveis. Essa lotação de 100% da rede hoteleira tem animado os comerciantes da cidade, que veem a possibilidade de aumento nas vendas não apenas nos polos do evento. Com o aumento do número de pessoas da cidade
Para o palco do “Polo Estação das Artes”, na antiga estação ferroviária da cidade, a Prefeitura montou uma programação diversificada, com vários ritmos e estilos.
As atrações confirmadas para esse polo são: Dorgival Dantas, Simone Mendes, Eric Land, Xand Avião, Zé Vaqueiro, Felipe Amorim, Zé Cantor, Joelma, Taty Girl, Mari Fernandez, Nattan, Desejo de Menina, Mara Pavanelly, Walkyria Santos, Márcia Fellipe, Leonardo e Júnior Viana.
O “Arraiá do Povo” será instalado no Parque de Exposições Armando Buá, mais conhecido como “Feira do Bode”. Para o local, a Prefeitura confirmou as bandas Bonde do Brasil, Cavaleiros do Forró, Kátia Cilene, Waldonys e Ferro na Boneca.
POLO CIDADELA
Cidade cinematográfica que reproduz os
ganham, além da rede hoteleira, os vendedores que atuarão no evento, proprietários de bares, restaurantes e comércios locais. Uma pesquisa feita no ano passado pela CDL Mossoró em parceria com a Universidade do Estado do Rio Grande do Norte (Uern) apontou que mais de 780 mil pessoas visitaram Mossoró durante a realização do MCJ 2022. Ainda de acordo com a
última pesquisa, a estimativa foi de que os gastos do público com o evento tenham somado R$ 115,6 milhões, o que corresponde a R$ 146 reais gastos por participante, em média. A CDL apontou que, para cada R$ 1 investido no evento, houve um retorno de, aproximadamente, 11 reais movimentados nos setores hoteleiro, de bares e restaurantes, ambulantes e permissionários
primeiros arraiás regionais. O polo reúne famílias, amigos e conta com palcos para apresentações de atrações musicais, além de barracas de comerciantes locais. As apresentações são feitas por artistas locais e a programação ainda não foi divulgada.
e pelas quadrilhas, além dos gastos efetuados pelos turistas e moradores locais.
A pesquisa apontou ainda que o MCJ foi responsável por gerar em torno de 6.100 empregos diretos e indiretos. “Os dados apontados pelo estudo indicam um recado de que o Mossoró Cidade Junina não representa um gasto, mas um investimento a ser tratado como um bem so -
ARENA DAS QUADRILHAS
A Arena Deodete Dias, mais uma vez, será o palco para as quadrilhas de Mossoró e de todo o Nordeste se apresentarem em um dos maiores concursos de quadrilhas juninas do país.
POLO CIRCO DO FORRÓ
O polo será montado na Praça de Convivência, com apresentações de artistas locais e muita música regional, durante todos os dias de festa.
POLO POETA ANTÔNIO FRANCISCO
O polo homenageia um dos maiores poetas e toda a sua bagagem cultural. Será montado no Memorial da Resistência com programação diária.
POLO IGREJA SÃO JOÃO
Apoio à festa de São João Batista, que ocorre no bairro Doze Anos, uma das mais tradicionais festas de padroeiro da cidade.

Para este ano, as expectativas são ainda maiores, levando em consideração que o evento começou a ser anunciado em fevereiro, antes de ser divulgada a programação de outros grandes São Joões que têm tradição e história, como é o caso dos festejos realizados em Assú e Campina Grande. Outro grande diferencial para este ano é a variedade de estilos musicais dos artistas contratados.
As apresentações nos polos contarão com grandes artistas locais, regionais e nacionais, como é o caso do cantor Leonardo e da cantora Simone, que se apresentarão na Estação das Artes Elizeu Ventania, nos dias de evento. Além do sertanejo e do típico forró, a Prefeitura vem investindo também na contratação de bandas de axé, repetindo o que ocorreu no ano passado com o Pingo da Mei Dia e Boca da Noite. Neste ano, Bell Marques, Parongolé e Cláudia Leitte se apresentam nos trios elétricos dos eventos que abrem e fecham o São João.
De acordo com a pesquisa “Os impactos socioeconômicos do evento Mossoró Cidade Junina – MCJ” sobre a economia local, realizada pela Universidade do Estado do Rio Grande do Norte (UERN), em parceria com a Câmara de Dirigentes Lojistas de Mossoró (CDL/Mossoró), 788 mil pessoas visitaram o MCJ no ano passado, ano da retomada do evento de forma presencial, o que não ocorreu em 2021 e 2020 (realizados no formato virtual).
Esse quantitativo representou um aumento aproximado de 10% em relação ao público presente em 2017, quando foi realizado o último estudo do tipo pela Uern.
Organizadora, a Prefeitura de Mossoró divulgou pesquisa
CONT. DA CAPA

VIVA OS NO I VOS!
GEORG IANO A ZEVEDO
Divulgação
georgianoazevedo@gmail.com

sentam e percebam os sintomas é de fundamental importância não esperar por melhora sem a orientação de um profissional de saúde.
de Básica de Saúde da região onde se reside, a fim de que seja realizado o acompanhamento pelas
mento especializado nos
A recomendação é buscar atendimento nas UBSs para realizar acompanhamento
Wanderson Diniz comemorou idade nova durante feriadão, em Tibau, ao lado da esposa Alaianny Medeiros.
A Dra. Priscila Duarte curte merecidas férias visitando pontos turís�icos da Europa, inclusive, comemorou idade nova por lá. Só alegria!
A modelo Monique Rego, Miss Rio Grande do Norte 2018, começou a semana de idade nova e daqui segue o nosso abraço!
Em Mossoró, a população pode encontrar vários equipamentos que trabalham com saúde mental, como Unidades Básicas de Saúde (UBSs), Centros de Atendimento Psicossocial (CAPS), Hospital Psiquiátrico Milton Marques de Medeiros, PAM do Bom Jardim, Centro Especializado em Reabilitação e Unidade de Pronto Atendimento do Santo Antônio.
AO maior bloco junino do Brasil, o “Pingo da Mei Dia”, abre oficialmente o período junino de Mossoró, no dia 3 de junho. Até o momento, a Prefeitura de Mossoró já anunciou, ao menos, duas atrações nacionais.
EQUIPAMENTOS:
Unidades Básicas de Saúde (UBSs): UBSs de Mossoró desenvolvem ações de promoção e prevenção à saúde mental;
CAPS II Antônio Herculano: Atendimento a todas as faixas etárias para transtornos mentais graves e persistentes;
CAPS II Mariana Neuman: Atendimento a todas as faixas etárias para transtornos mentais graves e persistentes;
cossocial (Caps).
Em viagem para Itália, o casal Leonardo Vale e Luana Mendonça anunciou noivado. Parabéns!
Rannier Ferrari e Roberta Duarte celebrando 24 anos de casados. Muito amor!
O estilista potiguar, Wallace Macedo, atualmente radicado em Los Angeles, comemorou aniversário na sexta-feira, 7, no P.F. CHANG’S China Bistrô, com almoço intimista para seus convidados. Em seguida, reuniu queridos para um jantar no OMNIA NIGHT CLUB no CESARES PALACE, e encerrou as comemorações na festa SECRETA no LUXOR HOTEL & CASSINO no domingo, 9, com uma badalada pool party. Todos convidados receberam de lembrança peças exclusivas da sua coleção color collection da sua marca WM SWIMWEAR.
O aniversariante Wallace Macedo em dia de #BDay no P.F Chang’s China Bistrô, em Las Vegas. Aí, sim!
MISS UNIVERSO RIO GRANDE DO NORTE

George Azevedo, coordenador do Miss Universo Rio Grande do Norte, confirma data da edição 2023. Será no dia 17 de maio, na capital potiguar. Voltaremos com detalhes!

Um dos grandes sucessos da edição passada, o cantor Bell Marques está de volta ao Pingo da Mei Dia. Segundo a pesquisa da UERN e CDL, o bloco junino no ano passado reuniu um público estimado de 150 mil pessoas. Outra atração de renome nacional é Raí Saia Rodada, que se apresentou na edição do ano de 2019, na qual também arrastou considerável público.
CAPS AD III: Equipamento de atenção psicossocial com foco em todas as faixas etárias, especializado em transtornos pelo uso de álcool e outras drogas;
CAPS Infantil: Equipamento de atenção psicossocial para pessoas com transtornos mentais severos e/ou persistentes com foco em crianças e adolescentes;
Já o “Boca da Noite” é o evento que encerra o MCJ 2023 em alto nível. Mantendo a tradição, o município preparou uma festa com a presença de artistas locais e nacionais. O grupo Parangolé e a cantora Cláudia Leitte já foram confirmados para o evento, que ocorre no dia 24 de junho.

Hospital Psiquiátrico Dr. Milton Marques de Medeiros: Internamento de pacientes para tratamento de saúde mental. Regulados por meio da UPA do Santo Antônio;
Centro Clínico Prof. Vingt-un Rosado (PAM): atendimentos ambulatoriais de adolescentes, adultos e idosos;
Nesta semana, a Prefeitura de Mossoró iniciou o credenciamento dos comerciantes que vão montar estruturas no Corredor Cultural durante os dois eventos. No primeiro momento, o credenciamento foi destinado para os pretensos autorizatários que manifestarem interesse na utilização dos passeios públicos na área do seu imóvel, desde que comprovem a propriedade ou a posse do mesmo no trecho do percurso oficial do evento.
UPA Conchecita Ciarlini: UPA do Santo Antônio possui urgência em saúde mental;
Centro Especializado em Reabilitação – CER IV: Reabilitação intelectual (cognitiva e Transtorno de Espectro Autista), física, auditiva e visual. Marcação por meio de UBSs.
A partir de amanhã, 24, até o dia 26 de abril, será realizado o cadastramento para os interessados em utilizar os demais espaços públicos, disponibilizados pela Secretaria Municipal de Infraestrutura, Meio Ambiente, Urbanismo e Serviços Urbanos (SEIMURB). Nesse caso, deverão comparecer nos respectivos dias, das 8h às 12h e das 14h às 17h, no auditório da Biblioteca Municipal Ney Pontes, situado na Praça da Redenção, s/n, bairro Centro.
>> o número consta no novo relatório global lançado pela UNICEF, e o total corresponde ao período de 2019 a 2021. Para a vacina contra pólio, foram 17 mil no mesmo período
Relatório “Situação Mundial da Infância 2023: Para cada criança, vacinação”, lançado pelo Fundo das Nações Unidas para a Infância (UNICEF), mostra que no Rio Grande do Norte 19 mil crianças não receberam nenhuma dose da vacina DTP entre 2019 e 2021. De acordo com o levantamento, no Brasil, o número chega a 1,6 milhão no mesmo período. Já no mundo o total alcança 48 milhões. O documento não traz dados por município.
Os números brasileiros fazem parte de um desafio global urgente. Segundo o relatório, o mundo vive o maior retrocesso contínuo na imunização infantil em 30 anos, alimentado pela pandemia de covid-19. Entre 2019 e 2021, as coberturas vacinais diminuíram em 112 países. A pandemia também exacerbou as desigualdades existentes.
O estudo aponta que as crianças que não estão recebendo vacinas vivem nas comunidades mais pobres, remotas e vulneráveis. Nos domicílios mais pobres, uma em cada cinco crianças não recebeu nenhuma vacina; enquanto nos mais ricos, apenas uma em 20. O relatório identificou ainda que crianças não vacinadas vivem, frequentemente, em comunidades de difícil acesso, tais como zonas rurais ou favelas urbanas.
O novo relatório global do UNICEF mostra que a interrupção de serviços na pandemia, sistemas de saúde sobrecarregados, falta de recursos e mudanças na percepção sobre a importância das vacinas impactaram esse número. O relatório faz um alerta para a urgência de retomar as coberturas vacinais no mundo.
“Essas crianças foram deixadas para trás, ficando desprotegidas de doenças sérias e evitáveis. As crianças nascidas pouco antes ou durante a pandemia agora estão ultrapassando a idade em que normalmente seriam vacinadas, ressaltando a necessidade de uma ação urgente para alcançar aquelas que perderam as vacinas e prevenir surtos e a volta de doenças já erradicadas no Brasil, como a pólio”, explica Youssouf Abdel-Je-
lil, representante do UNICEF no Brasil.
Para uma criança ser considerada imunizada, ela precisa tomar todas as doses recomendadas de cada imunizante e as doses de reforço, quando indicadas. O relatório global traz dados por país e usa como base a tríplice bacteriana (DTP), que conta com três doses. No Brasil, a DTP é oferecida como “pentavalente”, protegendo também contra hepatite B e contra a haemophilus influenza tipo b.
“Temos o grande desafio de retomar as altas coberturas vacinais em todo o Brasil após o retrocesso que vivemos nos últimos anos. Atualmente, o Brasil conta com uma cobertura vacinal das mais baixas da sua história desde a criação do Programa Nacional de Imunizações”, afirma a ministra da Saúde do Brasil, Nísia Trindade.
“Já tivemos 95% de cobertura em relação a vacinas como a da poliomielite, e agora não chegamos a 60% de crianças vacinadas. Esse quadro tem que mudar. Para isso, de uma maneira muito clara, temos de combater o negacionismo em relação a essa proteção dada pelas vacinas e às fake news que infelizmente têm sido veiculadas de uma forma irresponsável e criminosa”, completou a titular da Saúde enfatizando a queda da imunização no país nos últimos anos.
PÓlio
No Brasil, para a vacina contra a pólio, os dados são semelhantes aos da DTP: 1,6 milhão não receberam nenhuma dose entre 2019 e 2021. Para a vacina contra pólio no território potiguar, foram 17 mil no mesmo período.
O relatório está pedindo aos governos que: identifiquem e alcancem urgentemente todas as crianças, especialmente aquelas que perderam a vacinação durante a pandemia de covid19; fortaleçam a demanda por vacinas, inclusive construindo confiança; priorizem o financiamento de serviços de imunização e atenção primária à saúde; e reforcem os sistemas de saúde, incluindo investi -
O relatório Situação Mundial da Infância 2023 revela, também, que a percepção sobre a importância e a confiança nas vacinas para crianças diminuiu em 52 dos 55 países pesquisados. No Brasil, embora os índices continuem altos, houve uma queda de 10 pontos percentuais –antes da pandemia, 99,1% dos brasileiros confiavam nas vacinas infantis, e pós-
covid-19 são 88,8%.
Diferentemente dos resultados globais, no Brasil, a queda de confiança foi mais acentuada entre homens mais velhos (maiores de 65 anos). Na maioria dos países pesquisados, a queda foi maior entre mulheres e pessoas com menos de 35 anos.
Para vacinar cada criança, é vital fortalecer a atenção primária à saúde e for-
mento e valorização de profissionais de saúde, em sua maioria mulheres.
buSCa aTiVa
VaCinal Diante dos dados brasileiros, o UNICEF destaca duas linhas de ação complementares e fundamentais. Em curto e médio prazo, o País precisa investir para ampliar os percentuais de coberturas vacinais em todos os estados e municípios, em um esforço conjunto em nível federal, estadual e municipal para que todas as cidades retomem ao patamar de mais de 95% de cobertura vacinal de rotina, recomendado pela Organização Mundial da Saúde (OMS).



Em paralelo, é urgente encontrar e vacinar cada uma dos 1,6 milhão de crianças que ficaram para trás e não receberam nenhuma vacina contra a pólio ou a DTP entre 2019 e 2021, e também aquelas que perderam outras vacinas do calendário ou estão com doses atrasadas. “Uma busca ativa dessas crianças, olhando para municípios e estados com maiores números absolutos de não vacinadas e não imunizadas, é essencial, pois elas já ficaram para trás, e correm o risco de nunca ser imunizadas e protegidas contra doenças evitáveis. É urgente, também, retomar as campanhas de vacinação e estratégias de comunicação voltadas a famílias e profissionais de saúde, mas de forma regionalizada, respeitando a situação específica de cada território”, defende Youssouf Abdel-Jelil. Essas também são as prioridades do Ministério da Saúde. “O Movimento Nacional pela Vacinação lançado pelo Ministério da Saúde em fevereiro deste ano visa unir todo o País no propósito de recuperar as altas coberturas vacinais para que o Brasil volte a ser uma referência em todo o mundo. Vamos reconstruir a confiança da população brasileira nas vacinas e na ciência. É um movimento em defesa da saúde e da vida. Vacinas e água potável são responsáveis pelo aumento da expectativa de vida em todo o mundo. As vacinas salvam vidas”, reforça Nísia Trindade.
necer aos trabalhadores da linha de frente, em sua maioria mulheres, os recursos e o apoio de que precisam.
O relatório global constata que as mulheres estão na linha de frente da distribuição de vacinas, mas recebem baixos salários, têm empregos informais e enfrentam falta de treinamento formal e oportunidades de carreira e ameaças à sua segurança.
Para contribuir com esse esforço nacional, o UNICEF no Brasil conta com a estratégia de Busca Ativa Vacinal (BAV), desenvolvida para apoiar municípios para encontrar crianças não vacinadas ou com atraso vacinal, e tomar as medidas necessárias para que elas atualizem sua carteira de vacinação. A estratégia conta com capacitações para profissionais de saúde, educação e assistência social, e uma ferramenta tecnológica para auxiliar nesse trabalho intersetorial. Para a BAV, o UNICEF conta com a parceria estratégica da Pfizer e o apoio da Fundação José Luiz Egydio Setúbal.
>> Esta semana será dedicada à realização das matrículas; Semana de Planejamento Pedagógico começa dia 2 de maio, enquanto aulas serão a partir do dia 8
Quando criança, Jonas Iuri ficava encantado ao assistir programas de tv sobre animais e plantas. Decidido a estudar o que ele já gostava desde a infância, optou por concorrer, no último Exame Nacional do Ensino Médio (Enem), a uma das vagas no curso de Ciências Biológicas da Universidade do Estado do Rio Grande do Norte (Uern). O resultado foi positivo e o jovem e mais cerca de outros 2 mil calouros(as) desbravarão um novo mundo de aprendizado a partir do dia 8 de maio, data de início nas aulas do semestre 2023.1.
“A minha expectativa de ingressar na Uern está em alta, imagino pela novidade de conhecer novas pessoas e me aprofundar mais ainda na área que já amo desde pequeno. Sinto que tenha criado um sentimento de afeto muito grande sobre esta área da ciência, que só ficou maior quanto mais lia e aprendia sobre”, revela o ex-aluno do ensino médio de uma escola privada de Mossoró.
Ansiosa também está Julia Rebouças, caloura de Educação Física. “A expectativa de ingressar na universidade está alta, pois será uma nova jornada na minha vida, que me acrescentará não só profissionalmente, mas também pessoalmente”, acredita.
A escolha pelo curso se deu pelo interesse que ela tem em assuntos relacionados à saúde e à prática de exercícios físicos. “Escolhi a Uern tendo em vista o tempo de atuação da universidade junto ao curso e também o currículo do corpo docente. Vejo que muitos profissionais que compõem o corpo docente de outras universidades tiveram suas formações na Uern, então isso contribuiu bastante na minha escolha”, comentou.

Titular da Pró-reitoria de Ensino de Graduação (Proeg), a professora Fernanda Abreu destaca que, desde o recesso em curso,
o próximo semestre se estenderá até 2 de setembro, totalizando 101 dias
a Universidade está trabalhando para receber calouros e veteranos, que são a razão da existência dos processos educativos da Instituição. “Gostaríamos de lembrar a todos e todas que, de 24 a 28 de abril, acontecerão as nossas matrículas de veteranos e todos devem estar atentos para participar. Já no dia 8 de maio começam as nossas aulas e a expectativa é das melhores com o retorno de todos e todas as nossas salas de aulas”, comenta a pró-reitora acrescentando que a Semana de Planejamento Pedagógico começa no dia 2 de maio.
A partir deste semestre, será preciso usar o Sistema Integrado de Gestão de Atividades Acadêmicas (SIGAA). Os(as) veteranos(as) devem acessar e realizar sua “Solicitação de Matrícula”, disponível na área do aluno. No portal.uern.br, há um tutorial ensinando a como recuperar login e senha.
No caso dos(as) ingressantes, a matrícula será realizada pela respectiva Unidade Universitária em
Jonas Iuri está ansioso para ingressar no curso de Ciências Biológicas
todos os componentes curriculares do primeiro semestre letivo do curso no qual está ingressante. As datas são diferentes, levando em conta se o(a) candidato(a) foi aprovado (a) na chamada regular
(10 a 20 de abril), na segunda chamada (1 º a 5 de maio) ou na terceira chamada (29 de maio a 2 de junho). Posteriormente, o(a) estudante ingressante poderá fazer o ajuste de matrícula pelo Sigaa.
to (a) acompanhar a publicação de todos os atos, editais e comunicados referentes ao processo de Matrícula Curricular nos cursos de graduação da Uern, para o semestre letivo 2023.1, os quais serão divulgados no portal.uern. br.
O iminente semestre letivo 2023.1 se estenderá até 2 de setembro, totalizando 101 dias letivos, sendo 88 dias úteis e 13 sábados letivos. Já o semestre 2023.2 inicia dia 19 de setembro de 2023 e segue até 9 de março de 2024, também com 101 dias letivos.
a SS i STÊNC ia
Os novatos e veteranos encontram na Uern vários serviços que visam tornar mais tranquila a jornada acadêmica dos seus milhares de estudantes.
Os programas e auxílios de assistência estudantil conduzidos pela Pró-Reitoria de Assuntos Estudantis (Prae) incluem o Programa de Moradia Universitária (modalidades Residência Universitária e Auxílio Financeiro), o Programa de Apoio ao Estudante (PAE), o Auxílio Inclusão Digital, o Programa Auxílio-Creche, o Auxílio à participação de estudantes em atividades acadêmicas, científicas e culturais e o atendimento psicossocial por meio de equipe multiprofissional.
Pessoas com deficiência, sejam estudantes, professores ou técnicos administrativos, contam com o apoio da Diretoria de Políticas e Ações Inclusivas (DAIN), criada em 2008, com o objetivo de atender, acompanhar e apoiar essas pessoas com base na Política Nacional de Educação Especial, na perspectiva da educação inclusiva, bem como na Lei de Diretrizes e Bases da Educação Nacional com vistas à garantia dos direitos do espaço de ensino, pesquisa e extensão que consolidem ações e práticas voltadas às diferenças, à inclusão educacional, social e inserção no mercado de trabalho.
A respectiva Unidade, nos dias 15 e 16 de maio, ficará responsável por efetuar a matrícula dos(as) alunos(as) especiais em seus cursos.
Será de inteira responsabilidade do (a) candida -
Para estudar no próprio campus ou retirar livros e outros materiais para estudar em casa, os discentes podem contar com o Sistema Integrado de Bibliotecas Reitor Pe. Sátiro Cavalcanti Dantas, que conta, em todos os campus, com amplo acervo físico, ambientes para estudo e acesso à internet, biblioteca on-line, aplicativo, entre outros serviços.


Apresença de buracos em vias de trânsito também tem se tornado uma constante em todo o Rio Grande do Norte. A problemática representa um perigo para condutores de veículos que precisam redobrar a atenção em estradas urbanas municipais, estaduais e federais que cortam o território potiguar. Com a incidência de chuvas, os riscos de acidentes de trânsito com danos materiais, e vítimas feridas e até com mortes têm demonstrado tendência de aumento.
Relatos e imagens de buracos existentes em vias de trânsito pelo Rio Grande do Norte, tanto em áreas municipais, estaduais, quanto federais, têm sido publicados de forma frequente na internet nos últimos dias. A reportagem do Jornal DE FATO consultou um ativista de trânsito com atuação no estado e um profissional ligado ao Observatório Nacional de Segurança Viária (ONSV). Para o ativista de trânsito com atuação no Rio Grande do Norte, Clélio Soares, muitas vias do Rio Grande do Norte estão “em estado crítico, precisando urgentemente de ações eficientes de longo prazo e não mais ações do tipo tapa-buraco que não resolvem o problema”.
Ele chama a atenção para o fato de que todos os anos é o mesmo problema. “Choveu, e exatamente onde foram tapados os buracos, o asfalto literalmente se dissolve porque já é um ponto de fragilidade e não suporta o intenso fluxo de
carro responda efetivamente. Segundo ponto, com relação à qualidade dos pneus, porque até mesmo esses sofrem com os impactos violentos contra os buracos, aumentando riscos de estourar”, cita, alertando também sobre a questão da calibragem dos pneus e da velocidade na via.
“Um impacto contra um buraco já em velocidades superiores a 70 km/h já é capaz de causar danos e alterar a trajetória do veículo fazendo com que esse perca sua dirigibilidade”, acrescenta, recomendando ainda a preferência em transitar durante o dia para ter mais visibilidade dos buracos. “Uma grande quantidade de acidentes com buracos na pista acontece justamente à noite pela falta de visibilidade do condutor que não consegue reduzir a tempo”, alerta.
veículos que passa naquele local. O problema é que em, praticamente, toda nossa malha viária temos estradas em péssimas condições, as RNs que cortam cidades como Mossoró a Governador estão intransitáveis a velocidades superiores a 30 km/h em muitos trechos”, observa ele.
O ativista de trânsito pontua que o que mais se vê são motoristas tendo prejuízos diários em seus veículos por conta de pneus furados e quebras da suspensão.
“E com isso tudo vem o au -
mento da gravidade e letalidade de acidentes nesse tipo de estrada. A BR-304 é uma via que mesmo com o DNIT atuando para tentar tapar, a quantidade dos buracos que surgem é imensamente maior que a capacidade de recuperação, justamente pela razão que citei anteriormente, porque não são medidas efetivas de longo prazo”, avalia Clélio Soares, que luta pela melhoria e duplicação da BR304.
Ele lembra que a estrutura de estradas ainda é da
“Com certeza, precisamos de um alto investimento em modernização das nossas estradas para suportar o trânsito atual. Esse é um investimento muito alto na casa dos bilhões de reais, mas que é extremamente necessário. Precisam ser feitos estudos de engenharia de tráfego para que a partir desses estudos possa-se escolher o modelo de pista que mais suportará o tipo atual de trânsito que temos. Se não der para fazer isso de forma ampla para todas as estradas, mas que se crie um planejamento de começar com as de maior fluxo e que, consequentemente, têm o maior índice de acidentes”.
A declaração sobre quais medidas o poder público deve adotar para prevenir e conter a existência de buracos em vias públicas, e assim evitar a ocorrência de acidentes de trânsito provocados por essa problemática, é do ativista de trânsito com atuação no Rio Grande do Norte, Clélio Soares. Ele diz que com a incidência das chuvas nos últimos dias, os buracos nas vias têm se tornado mais evidentes e que tem notado uma maior presença de buracos em vias públicas de Mossoró e região, “principalmente, em bairros onde o asfalto é antigo e já reconsertado várias vezes; todos os anos, têm sempre muitos
buracos, bairros como Abolição 2, 3 e prolongamento do 4 são exemplos de uma imensidade de buracos que os motoristas precisam, diariamente, ter que desviar”.
Clélio Soares complementa que dentro da cidade o risco maior que vê é para os motociclistas que caem nesses buracos e que podem ser atropelados por outros veículos ou terem, por si só, da própria queda ferimentos graves ou mesmo a morte. “Ainda Mossoró não é uma cidade em que engarrafamentos são vistos diariamente, porém a presença de buracos nas vias lentifica o trânsito nos horários de pico e afeta o psi -
década de 70, sendo que o trânsito que havia, peso dos veículos, velocidade com que esses trafegam mudou drasticamente de lá para cá, mesmo com as mesmas estradas e cheias de remendos. “Esse caos nas nossas estradas não vai acabar enquanto não houver um foco e investimento maciço e bilionário para refazer toda a malha viária com uma estrutura modernizada para o volume e o tipo de tráfego atual que temos. Enquanto os governos levarem essa situação no paliativo, mui -
tas mais mortes e prejuízos os cidadão terão que suportar”, ressaltou.
O ativista de trânsito orienta sobre quais cuidados o condutor pode tomar para evitar se envolver em acidentes de trânsito provocados pela presença de buracos nas vias. Ele menciona quatro cuidados básicos. “Primeiro, avaliar o sistema de freios do veículo, fazer uma vistoria e manutenção antes de viajar para ver se está funcionando tudo corretamente para que numa possível freada brusca o
Reprodução
Números
A reportagem encaminhou e-mail para assessorias de imprensa de órgãos como a Prefeitura de Mossoró, a de Natal, do Departamento Estadual de Trânsito (DETRAN) e para a Polícia Rodoviária Federal (PRF) solicitando dados sobre a quantidade de acidentes de trânsito registrados nos últimos anos envolvendo buracos nas vias, mas não houve retorno até o fechamento desta matéria.
rios que todos os dias os motoristas do nosso estado têm ou para não terem precisam ser verdadeiros malabaristas na estrada para conseguir desviar dessa ‘outra face da lua’ (referência irônica ao lado da lua que só tem crateras) que é o nosso karma e vergonha de todo do norte-rio-grandense que recebe alguém aqui para passear pelo nosso belíssimo interior”, reflete Clélio Soares.
o bra s
Clélio soares chama a atenção para a necessidade de planejamento
cológico do motorista que todo dia enfrenta aquela circunstância estressante”, pondera ele, contando que recentemente um colega da segurança pública, um Policial Rodoviário, teve um enorme prejuízo por volta
dos R$ 2 mil por conta de um impacto contra um buraco na RN-015. O ativista relata que o ocorrido causou uma fissura na roda do veículo e danos na suspensão.
“Esse é um caso dos vá -
Obras de reparo são realizadas em determinados trechos de vias municipais, estaduais e federais do Rio Grande do Norte. No começo deste mês, o Governo do Estado anunciou obras de conservação de rodovias em todo o território potiguar para serem executadas, adequando-se “às condições climáticas, respeitando os limites impostos pelo período de chuvas”.

de veículos precisam redobrar a atenção por conta da presença frequente de vias de trânsitoDÓLAR
COnt. pág. 5
Para o observador certificado do Observatório Nacional de Segurança Viária (ONSV), Guto Castro, a presença de buracos em vias de trânsito precisa ser vista com mais atenção por parte das autoridades que cuidam da estrutura de tráfego. Ele ressalta que as chamadas RNs, PBs, PEs são campeãs de buracos que geram danos materiais nos veículos e acidentes de trânsito que resultam em feridos e mortos.
Odólar operou novamente em queda nesta quarta-feira, 12. Foi o segundo dia de recuo relevante da moeda americana, depois de resultados mais brandos da inflação brasileira e, nesta quartafeira, 12, da americana. A desaceleração dos preços aumenta a perspectiva de queda das taxas de juros aqui e nos Estados Unidos, o que anima investidores a deixar investimentos seguros e partir para ativos de risco. É uma situação que favorece investimentos em países emergentes, como o Brasil.
“Muito além de pneus furados, amortecedores quebrados, freios danificados, quebra de rodas e até capotamento de veículos, os buracos nas estradas federais, estaduais e municipais são responsáveis por uma série de acidentes que matam e deixam centenas de brasileiros sequelados todos os anos. Constitui-se, portanto, um problema grave e que gera demandas na saúde pública e que precisa ser visto com mais atenção pelas autoridades e gestores que cuidam dos sistemas viários nos municípios, estados e rodovias federais”, observa Guto Castro.
No início da tarde desta quarta-feira, 12, a moeda norte-americana caía 1,30%, cotada a R$ 4,9405. Na mínima do dia, o dólar chegou a R$ 4,9171. Na véspera, o dólar teve queda expressiva de 1,17%, cotada a R$ 5,0067, no menor patamar em 10 meses. Com o resultado, passou a acumular perdas de 1,23% no mês e de 5,14% no ano.
O que está mexendo com os mercados?
As divulgações dos índices de inflação do Brasil e dos Estados Unidos foram duas boas notícias para os agentes do mercado financeiro, que se preocupam com
>> Guto Castro, vinculado ao Observatório Nacional de Segurança Viária, diz que problemática precisa ser vista com mais atenção por autoridades que cuidam da estrutura de tráfego
lho dos EUA. Nos últimos 12 meses, o índice americano tem alta de 5% antes do ajuste sazonal — foi o menor patamar desde maio de 2021. Economistas previam que os custos ao consumidor cresceriam 5,2% na base anual, após aumento de 6% em fevereiro.
a responsabilidade do buraco na via – do município, do governo estadual ou da União. Hoje, conta-se nos dedos o número de cidades que mantém a operação tapa-buracos. Esse trabalho tem que ser permanente”, analisa o observador certificado do ONSV, complementando que as chamadas RN s, PBs, PEs “são campeãs de buracos e esses buracos mais do que danos nos veículos são responsáveis por parte dos acidentes de trânsito que geram dezenas de mortos e feridos nas rodovias estaduais”.
“O índice de habitação foi de longe o maior contribuinte para o aumento mensal de todos os itens. Isso mais do que compensou o declínio no índice de energia, que caiu 3,5% no mês, com a queda dos principais índices de componentes do setor. O índice de alimentos permaneceu inalterado em março, com o índice de alimentação em casa caindo 0,3%”, diz o comunicado.
Ele diz que o ideal era não achar natural a convivência com os buracos no sistema viário. “Mas, a verdade é que eles nascem, crescem e se multiplicam todos os anos, principalmente depois do período de chuvas. E aliado a esse diagnóstico, temos a falta de recursos para manutenção das vias que ‘obriga’ os condutores a manter essa convivência perigosa”, pontua. “Dependendo, em algumas regiões o ideal é evitar os trechos esburacados, usando rotas alternativas. Mas, se tem que enfrentar o cenário sem outra opção, a orientação é reduzir a velocidade, observar
desaceleração da economia global. Ambos os dados indicam que a subida dos juros está fazendo efeito nos preços, e que poderão ser reduzidos em um prazo mais curto. Na terça-feira, o dólar te-
a via, visualizar a fissura e evitar frear sobre o buraco ou entrar na contramão do fluxo”, orienta.
ve um forte recuo, que o colocou no patamar de R$ 5, após inflação brasileira vir abaixo do esperado. O Índice Nacional de Preços ao Consumidor Amplo (IPCA) subiu 0,71% em março, enquanto a expectativa de mercado era
de alta de 0,77%. Com isso, o país passa a ter uma inflação acumulada de 4,65% na janela de 12 meses. É o menor valor para 12 meses desde janeiro de 2021. Nesta quarta-feira, os números de inflação dos Esta-
“Outra dica importante é manter o veículo em ordem com as revisões recomendadas em dia e um pneu reserva em bom estado. A revisão do sistema de
freios e amortecedores também é de grande valia para evitar acidentes. Ajuda a enfrentar melhor o desafio de viajar pelas estradas do país”, acrescenta Guto Castro, chamando a atenção para o fato de que temos um país com dimensões continentais e desa -
A Receita Federal vai intensificar a fiscalização do pagamento de impostos de produtos importados via comércio eletrônico. Segundo o órgão, não haverá aumento de tributo, pois hoje já existe a tributação de 60% sobre o valor da encomenda, “mas que não tem sido efetiva”.
do exportador e do importador. Em caso de subfaturamento ou dados incompletos ou incorretos haverá multa.
Com o tema “No trânsito, escolha a vida”, a campanha Maio Amarelo completa dez anos agora em 2023. A ação iniciada em 2014 tem a proposta de chamar a atenção da sociedade para o alto índice de mortes e feridos no trânsito. A segunda maior cidade do Rio Grande do Norte participa da iniciativa.
“O que se está se propondo são ferramentas pra viabilizar a efetiva fiscalização e exigência do tributo por meio de gestão de risco”, informou. “A Receita vai centrar sua fiscalização nas remessas de maior risco, em que nossos sistemas de gestão de riscos, alimentados pelas declarações antecipadas, apontem risco maior de inconsistências”, explica o comunicado.
A proposta da Receita é obrigar a apresentação de declarações completas e antecipadas da importação, com identificação completa
No começo deste mês, a Prefeitura de Mossoró, por meio da Secretaria Municipal de Segurança Pública, Defesa Civil, Mobilidade Urbana e Trânsito (SESDEM), e a coordenação do PVT (Programa Vida no Trânsito), deram início aos preparativos para a campanha Maio Amarelo deste
Atualmente, existe isenção de impostos sobre remessas internacionais até US$ 50, somente para transações feitas de pessoas físicas para pessoas físicas. Entretanto, o órgão está propondo mudanças no processamento de encomendas para evitar fraudes por grandes empresas estrangeiras.
e físicas. “Hoje as remessas por pessoas físicas de bens com valor relevante são absolutamente inexpressivas. Essa distinção só está servindo para fraudes generalizadas nas remessas”, argumentou.

ano. A Prefeitura de Mossoró informou que durante o mês de maio serão realizadas ações educativas, blitze de conscientização, passeio ciclístico, seminários e várias outras ações.

A campanha contará com a participação de diversas instituições, que somarão nas ações do movimento. “Sobre o projeto ‘Maio Amarelo’, é sempre de extrema importância a participação da coletividade”, ressaltou Luís Correia, diretor executivo de Mobilidade Urbana de Mossoró.
“Esse benefício é apenas para envio de pessoa física para pessoa física, mas vem sendo amplamente utilizado fraudulentamente, para vendas realizadas por empresas estrangeiras”, explicou o órgão em nota à imprensa, na noite desta terçafeira (11) para esclarecer informações divulgadas pela imprensa de que o órgão acabaria com esta isenção específica de imposto.
A Receita quer dar o mesmo tratamento nas remessas de pessoas jurídicas
Na edição do Maio Amarelo do ano passado, a campanha também teve adesão no Rio Grande do Norte, com atividades como ações
Para a Receita, as medidas visam beneficiar os consumidores. “Com a declaração antecipada, a mercadoria poderá chegar no Brasil já liberada (canal verde), podendo seguir diretamente para o consumidor”, afirmou. “Com o tempo, o próprio consumidor vai preferir comprar de empresas confiáveis, que atendam estritamente a legislação brasileira”, completa.
educativas de trânsito voltadas para estudantes.
Na ocasião, a iniciativa contou até com simuladores de embriaguez, em que os participantes usaram óculos para ter uma experiência virtual com os efeitos do álcool sob o condutor embriagado. Em 2022, o Maio Amarelo teve como tema “Juntos Salvamos Vidas”. A organização da ação lembra que a cor amarela, que no semáforo é utilizada para chamar atenção tanto dos motoristas quanto dos pedestres, foi a escolhida para simbolizar a atenção necessária para a campanha, que tem um laço na cor amarela como símbolo do movimento.
Atualmente, as importações por pessoas físicas não podem ultrapassar US$ 3 mil por operação. Até US$ 500, o imposto é simplificado e corresponde a 60% da compra, incluindo o valor do produto e de eventuais taxas de frete e de seguro. De US$ 500 a US$ 3 mil, também incide o Imposto sobre a
Circulação de Mercadorias e Serviços (ICMS), administrado pelos estados, e uma taxa de despacho aduaneiro de R$ 150.
fios enormes. “Um deles, por exemplo, diz respeito à municipalização do trânsito nos 5. 568 municípios brasileiros. Os buracos nascem nas cidades e milhares destes municípios não contam com instrumentos de gestão para o trânsito e sua malha viá -
Acima de US$ 3 mil, a
dos Unidos também vieram abaixo das expectativas. O Índice de Preços ao Consumidor (CPI, na sigla em inglês) teve alta de 0,1% em março, depois de aumentar 0,4% em fevereiro, informou o Departamento do Traba -
ria”, avalia. “Ora, se não há municipalização do trânsito também não haverá recursos e não existindo recursos o poder público não tem como reparar permanentemente a ocorrência de fissuras no sistema viário. E aí fica esse debate de quem é
compra passa a ser considerada de pessoa jurídica. Cada produto é tarifado conforme o Imposto de Importação e são acrescidos outros tributos como Imposto
aCidente peSSOal
Já o núcleo dos preços dos EUA veio em linha com o esperado, de 0,4% no mês e 5,6% em 12 meses. O ritmo é ligeiramente mais rápido em comparação anual com os 5,5% de fevereiro, mas levemente mais lento no mensal (0,5% em fevereiro).
Investidores monitoravam os resultados, pois um dado forte no relatório de inflação poderia alimentar apostas de que o Federal Reserve (BC dos EUA) continuará elevando os juros em sua próxima reunião de política monetária, no início de maio.
O observador certificado do Observatório Nacional de Segurança Viária (ONSV), Guto Castro, conta que há alguns anos deixou a metade do cano de escape do carro dele em um buraco entre as cidades de Parnamirim e Natal. “Tive que parar o carro mais adiante no acostamento e retirar o cano de escape da via para não causar um outro acidente. Além do buraco o problema maior foi retirar com as mãos uma peça que trabalha em alta temperatura. Tive que esperar esfriar para depois remover”, relatou.
sobre Produtos Industrializados (IPI), Programa de Integração Social (PIS) e Contribuição para o Financiamento da Seguridade Social (Cofins).
>> Desaceleração dos preços aumenta a perspec�iva de queda das taxas de juros aqui e nos Estados UnidosFoi o segundo dia de recuo relevante da moeda americana

Keiller; Igor Gomes, Vitão, Mercado e Renê; Baralhas, Gustavo Campanharo (Johnny), Alan Patrick e Wanderson; Pedro Henrique e Alemão. Téc. Mano Menezes
FLAMENGO
Santos; Fabrício Bruno, David Luiz e Léo Pereira; Marinho, Vidal, Thiago Maia, Gerson e Ayrton Lucas; Gabigol e Pedro. Téc. Jorge Sampaoli
Após fazer sua estreia e ajudar o Flamengo a se reabilitar na Libertadores, o técnico Jorge Sampaoli terá o seu primeiro desafio no Campeonato Brasileiro neste domingo, 23, às 11h, quando enfrenta o Internacional, no BeiraRio, pela segunda rodada.
O Flamengo vem de uma vitória por 3 a 0 sobre o Coritiba e segue sendo um dos favoritos ao título. Já o Internacional apenas empatou com o Fortaleza por 1 a 1 e viu a pressão aumentar em cima do técnico Mano Menezes.
Inter e Flamengo já se enfrentaram em 85 oportunidades, com 32 vitórias do time colorado, 24 empates e 29 triunfos do rubro-negro. No ano passado, no Brasileirão, o time gaúcho venceu por 3 a 1 e segurou um empate por 0 a 0.
Jorge Sampaoli deve repetir a escalação que usou na Libertadores, priorizando nomes com quem já trabalhou: os volantes Gerson e Vidal, além do atacante

FUTEBOL NACIONAL
>> Duelo acontece hoje, às 11h, no Beira-Rio
Marinho. Pedro e Gabigol também devem seguir na equipe.
O desfalque fica por conta do atacante Bruno Henrique. O jogador vem recebendo um tratamento individual e, por isso, não foi relacionado para o confronto deste domingo.
“O sentimento popular por esse clube é muito, muito grande. Sem dúvidas, tudo que nós queremos dentro do campo para fora gerará maior ilusão e tentaremos que a equipe
RIO – Vasco recebe o Palmeiras neste domingo, 23, às 16h, no Maracanã, pela segunda rodada do Campeonato Brasileiro. A partida marca o reencontro do Vasco com a Série
A como mandante, após dois anos disputando a Série B. Por esse motivo, espera-se a presença de mais de 60 mil vascaínos.
O time carioca terá o desfalque do técnico Maurício Barbieri, expulso na vitória sobre o AtléticoMG, por 2 a 1, no jogo de estreia na competição. A equipe será comandada pelo auxiliar técnico Maldonado, ex-jogador chileno que teve passagem de sucesso no futebol brasileiro. A tendência é de que a escalação seja repetida.
Se o Vasco está confiante por ter vencido o Galo fora de casa, o Pal-
meiras está embalado com quatro vitórias consecutivas. O time de Abel Ferreira venceu em sequência o Água Santa, Tombense, Cuiabá e Cerro Porteño, no Paulista, Copa do Brasil, Brasileiro e Libertadores, respectivamente. O Verdão terá desfalques importantes com Rony e Raphael Veiga, que estão no departamento médico.
Esta será a primeira vez que Vasco e Palmeiras se enfrentam no Maracanã no Século 21. A última vez foi em 2000, pelo primeiro jogo da final do Torneio Rio-São Paulo. Na ocasião, o Alviverde venceu por 2 a 1, gols de César Sampaio e Pena, com Romário descontando. No segundo jogo, o Verdão confirmou o título ao golear o CruzMaltino por 4 a 0.
consiga cumprir a expectativa da torcida em um time de tanta história”, disse Sampaoli.
No Internacional, Mano Menezes deve seguir rodando o elenco para não desgastar os seus jogadores nesta forte sequência do time. Com isso, poderá utilizar novamente um time misto.
Quem deve receber nova chance entre os titulares é o atacante Alemão, que fez o gol da vitória sobre o Metropolitanos. Caso isso
aconteça, Luiz Adriano iniciará no banco de reservas. Já o meia Maurício está de volta, após se recuperar de lesão, e também pode aparecer entre os 11.
“Precisamos dar uma resposta para os nossos torcedores e estamos trabalhando nisso. Sabemos da importância do Campeonato Brasileiro e, por isso, a vitória é essencial diante de uma equipe que também brigará pela parte de cima da tabela”, disse Mano Menezes.
Natal – O ABC volta a campo neste domingo, 23, para enfrentar o Vitória pela 2ª rodada da Série B do Campeonato Brasileiro. O “Elefante potiguar” tenta a primeira vitória na Segundona, enquanto o adversário visa engatar o segundo triunfo consecutivo.
Na partida de estreia, os abecedistas visitaram o Londrina e foram derrotados pelo placar mínimo no último domingo, 16, ficando na 14ª posição. Diferente do ABC, os rubro-negros largaram com o pé direito e derrotaram a Ponte Preta no Barradão, por 3 a 0, ocupando a 3ª colocação e somando três pontos.
Indo com força máxima, o ABC tem novidades para encarar os leoninos.
Recém-contratados junto
ao Água Santa, o Elefante pode ter as presenças de Ramon, Lucas Tocantins e Júnior Todinho na partida, porém o trio é aguardado para figurar como alternativa no banco de reservas.
Já Matheus Anjos, que não atua pelo alvinegro desde 4 de fevereiro, é cotado para iniciar como opção entre os suplentes. Em contrapartida, Thonny Anderson declarou ainda não estar 100% fisicamente e fica ausente da lista de relacionados diante do rubro-negro baiano.
O técnico Fernando Marchiori reconhece a maratona pesada a ser encarada pelo ABC. De acordo com o treinador, porém, a Segundona é o foco da equipe.
AGENDA JOGOS, DOMINGO (23)
SÉRIE A
11h – Inter x Flamengo
16h – Santos x Atlético/MG
16h – Vasco x Palmeiras
18h30 – Coritiba x Fortaleza
19h – Goiás x Corinthians
SÉRIE B
15h30 – Chapecoense x Londrina
18h – ABC x Vitória

fabiowillard@hotmail.com
fabio willard de oliveira

Já com carta branca, como pleiteava como condicionante para continuar como CEO do Potiguar, Márcio Mossoró vai conduzindo os rumos do clube, em termos de formação de elenco, para a Série D. As primeiras ações foram centradas na renovação de contrato dos meias Giovanni e Wilson, além da extensão do contrato de Romeu por mais uma temporada, cujo vínculo inicial terminaria ao final deste ano. Três jogadores importantes na campanha desta temporada. Além dessas permanências, o clube anunciou a contratação do atacante Michel, um dos destaques do Santa Cruz de Natal no estadual deste ano. Bom jogador. São ações pontuais e importantes. Mas ainda há muito o
que se fazer, pois o elenco carece de reforços em todos os setores. Não adianta se enganar. A terceira colocação no estadual não serve de parâmetro para uma competição nacional. O elenco tem boas peças? Claro que sim, mas tem peças destoantes, portanto longe de ser um elenco equilibrado o suficiente para encarar um Campeonato Brasileiro, caso haja projeto de ascensão. Se for apenas para participar, menos que isso já serve. Mas não creio que o pensamento de Márcio seja tão simplório assim, como provavelmente seria em outras mãos. O início da trajetória, se não empolga, também não decepciona. Prefiro tratar com reservas e aguardar cenas dos próximos capítulos.
''O nome de Radames ainda não apareceu no BIP”
sérgiO maria, preparador de goleiros do Potiguar em 2018, confundindo com o Boletim Informativo Diário com o BIP, aquele aparelhinho que transmitia mensagens, que também se chamava de Page, e antecedeu ao celular.

O tEmpO urgE
Falando em passos no Potiguar, embora as ações de renovação e contratação estejam sendo pontuais, bem analisadas, como se espera, não há tempo a perder. A estreia na Série D começa em duas semanas.
rEspOnsabiliDaDE
Júnior Câmara se reapresenta nesta segunda-feira (24) para reassumir o comando técnico do Potiguar. Sua permanência é uma aposta pessoal de MM8, que bancará a escolha.
COta EsgOtaDa
O atacante Henrique Nunes, 20, não seguirá no Potiguar para a Série D. Foi devolvido ao Mossoró. A informação de dentro do clube é que uma coleção de indisciplina encurtou sua trajetória no alvirrubro.
m
Ao invés de Brasileiro agora, Henrique vai disputar a 2ª divisão potiguar, no segundo semestre. Até lá terá muito tempo para repensar sua vida e convencer o Mossoró (leiase Edinho Cardoso e João Dehon) a continuar apostando nele. Caso contrário, poderá voltar para a várzea.
CrOsstraining
potiguar, vice-campeão estadual de


2006: Marcão (preparador de goleiro), Claudevam Moreira, Erivan, Herivelto Moreira, Ricardo Schrombeger, Mazinho Nascimento, e Leandro Carioca; Fábio Giuntini, Canindezinho, Jânio Guerreiro, Ricardo Lima e Niel. 2006 vice-campeão

Hoje (23), o técnico DalCivan, de longa história no futebol amador local, entra para o clube dos cinquentões. Saúde, paz e sucesso, amigo!
FUtEbol ClUbE
Reprodução
bErg burg
Bairro Boa Vista
Torcedor do Vasco da Gama
Começou ontem (22) e segue neste domingo (23) o Ropefit, competição de crosstraining no Ginásio Pedro Ciarlini. Mais de 100 atletas participam do evento. A entrada é 1 kg de ração para cães ou gatos.
Em entrevista ao canal CCTV, da China, o presidente Lula afirmou assistir aqui muitos jogos do campeonato chinês. Segundo ele, aqui “tem canal que transmite”. Hoje, ninguém transmite para o Brasil.
O América de Natal, com a chegada da SAF e seu milionário investimento, se credencia a dar um salto em sua história. Reorganizado pelo ídolo do clube, Souza, recebe as condições para manter uma gestão de futuro.
De acordo com o Chat GPT, aplicativo de inteligência artificial, a seleção do futebol mundial de todos os tempos tem Buffon; Cafu, Baresi, Beckenbauer e Maldini; Zidane, Cruyff e Maradona; Messi, Cristiano Ronaldo e Pelé. Embora caiba discussão, é uma seleção considerável.
Esteticista e micropigmentadora, Gilmara dos Santos, explica que além de evitar fazer alguns procedimentos no período de verão, também é indicado tomar alguns cuidados após a estação mais quente do ano.
Independente do período do ano, a procura por procedimentos estéticos tem aumentado. As pessoas estão cada vez mais interessadas em cuidar e investir na aparência, principalmente, como uma forma de autocuidado. No entanto, alguns procedimentos estéticos devem ser evitados no período de verão, época quando há maior possibilidade de exposição ao sol, como explica a esteticista e micropigmentadora Gilmara Arcanjo dos Santos.
A profissional que está fazendo pós-graduação em estética e cosmetologia explica que começou a trabalhar na área de estética e beleza atuando com Design de Sobrancelhas e depilação.




Atualmente, ela realiza procedimentos na Área de Estética
Facial, Micropigmentação, Depilação a Laser e ainda promove cursos profissionalizantes, repassando seus conhecimentos para outras pessoas interessadas em atuar na área.
Gilmara dos Santos comenta que além de evitar fazer alguns procedimentos no período de verão, também é indicado tomar alguns cuidados após a estação, como é o caso da limpeza de pele, necessária para hidratar e reduzir o acúmulo de impurezas causado pelo sol, praia, piscina e etc.
“Pode e deve-se associar a limpeza de pele a outros procedimentos estéticos, como o microagulhamento e peelings para estimular o colágeno da pele”, reforça a especialista.
Após a realização de procedimentos como esses também é
preciso manter alguns cuidados, como a manutenção de uma rotina de skin care, adaptada às suas necessidades, que deve ser complementada com uma boa alimentação e exercícios físicos realizados regularmente.

E os cuidados com a pele devem iniciar já na adolescência, como explica Gilmara. Segundo a esteticista, dependendo da necessidade da adolescente ou do adolescente, já é indicado começar a fazer a limpeza de pele a partir dos 13 anos.
E o procedimento de limpeza deve ser realizado de forma regular. “O ideal seria a realização da limpeza de forma mensal. No entanto, como esta é uma realidade muito distante, indicamos que seja feito pelo menos a cada 90 dias, a depender da necessidade do paciente”, orienta.
www.sergiochaves.com | sergiodefato@gmail.com



Hoje é dia de vivas para a querida Sônia Maria do Vale Rocha, Liliane de Medeiros Gastão Costa, a fonoaudióloga Flávia Dantas Gurgel Pereira, Gilca Leonardo, o bacana Ramón Silva Pilares e o amigo Raniére Fernandes. Amanhã (24), é dia de festejar o colunista Toinho Silveira. O empresário Rutênio Queiroz Gondim, a querida Mara Lidiane Felisardo e Helena Praxedes. Para vocês paz, saúde, amor e alegrias. Parabéns!



AS FERAS
No programa As Feras desse domingo (23), eu, Saudade Azevedo e Nelsinho Filho vamos bater um papo com a advogada Vânia Furtado e saber um pouco mais sobre pensão alimentícia, assunto tão em pauta sempre. Tem ainda o Sacolão das Feras, sorteio de brindes e aquela seleção musical que faz a diferença. Esperamos vocês a partir das 19h, na 93 FM/Nossa TV. Até lá!
O Mossoró Cidade Junina se aproxima e as atrações vão sendo fechadas. Pingo da Mei Dia com Bell Marques e Raí Saia Rodada e, Boca da Noite com Cláudia Leite e Parangolé são os pontos altos até aqui. Na Estação, das atrações anunciadas até aqui, destaque para Xand Avião e Leonardo. Um ponto que tem recebido muitas críticas são os altos preços dos camarotes. A Prefeitura de Mossoró reuniu a imprensa natalense na quinta (20), no auditório do SESC/Cidade Alta para fazer o lançamento do MCJ’23. Foi sucesso!
FEMEA
A 3ª edição da Feira de Mulheres Empreendedoras e Artesãs (FEMEA) acontecerá entre os dias 12 e 13 de maio e pretende reunir empreendedoras das mais diversas áreas com seus produtos. A Feira irá acontecer na Praça de Eventos no Corredor Cultural da avenida Rio Branco. Desfiles e shows culturais prometem movimentar o espaço. Interessadas entrem em contato pelo 84/988165116 ou pelo instagram @feira_femea.
 Sérgio Chaves
Sérgio Chaves

O Ilumine Studio Médico, bem instalado no Mossoró Mall, foi inaugurado na sexta (14), em evento que reuniu muita gente bacana, com buffet de Júnior Souza, marketing de Larissa Gabriele e projeto assinado pela arquiteta Isadora Saraiva. Os drs. Nelson Lariú, Assia Giselle, Pedro Henrique e Mirna Gurjão estão de parabéns!




Não sou nada. Nunca serei nada. À parte disso, tenho em mim todos os sonhos do mundo.” FERNANDO


Georgiano Azevedo bateu o martelo e o Miss Universe Mossoró acontece no próximo dia 5, a partir das 18h30., no Thermas Hall, numa superprodução da Tráfego Models e CYM Iluminação & Design. Doze candidatas concorrem ao título, escolhidas numa seletiva que aconteceu na semana passada. Retorno.

O jornalista Toinho Silveira comemora idade nova na segunda (24) e recebe amigos jornalistas para o “Première Breakfest”, das 8h às 10h30, no piso superior da Mercatto, em Natal. Momentos de descontração e bom gosto bem ao estilo do anfitrião. Daqui desejo toda a felicidade a Toinho!



 NEY ROBSON VIEIRA ALENCAR conexaosaude.defato@outlook.com conexaosaude.defato@outlook.com
NEY ROBSON VIEIRA ALENCAR conexaosaude.defato@outlook.com conexaosaude.defato@outlook.com

Apesar dos contrastes, ambos têm uma coisa em comum: a grande e complexa capacidade de causar doenças graves. Vírus e bactérias nem sempre provocam esses problemas, mas são potenciais patógenos de enfermidades graves. Quer entender melhor o assunto? Continue a leitura.
Pouquíssimas são as similaridades entre os dois organismos. Por exemplo, eles não podem ser vistos a olho nu e se multiplicam com grande facilidade. Mas, há mais diferenças do que semelhanças.
Vamos começar falando das bactérias.
Seres unicelulares de composição simples, elas medem cerca de 0,05 milésimos de milímetro, mas são dez mil vezes maiores que os vírus!
A bactéria é a forma de vida mais antiga do nosso planeta e tem um papel importante na limpeza do ambiente, pois são alta-
mente eficientes no processo de decomposição de animais e de plantas mortas.
Os vírus, por outro lado, são tão simples que nem chegam a ser considerados seres vivos, antes, são tidos como um material genérico. Além disso, eles necessitam de estruturas celulares de organismos vivos para se reproduzir e possuem apenas uma capa proteica para proteção.
Cientistas consideram que podem existir trilhões de espécies de vírus no planet a! Esse dado nos diz muito sobre o quão pouco ainda sabemos sobre eles.
Basicamente, a diferença entre doenças virais e bacterianas está no modo como elas se desenvolvem no hospedeiro. Uma vez que todos os tipos de vírus necessitam das células para se reproduzir, a progressão do problema se dá na proporção em que células são afetadas. As bactérias, por outro lado, não necessitam disso. Circulam livremente no organis-
mo e o avanço da patologia por ela causada também acontece à medida que se espalha.
Por outro lado, esses agentes apresentam sintomas muito similares no início das doenças infecciosas. Mal-estar, febre, diarreia, náuseas, entre outros, são os primeiros sinais e, de acordo com seu progresso, os sintomas vão se diferenciando.
Bactérias são seres altamente interativas. Na verdade, nós vivemos uma relação íntima, no estrito sentido da palavra, com elas. Alguns cientistas apostam, ainda, que os micro-organismos formam boa parte do corpo humano.

Precisamos delas e elas precisam de nós. A esse relacionamento damos o nome de cooperação. Fica claro, portanto, que o problema não é ter bactérias no nosso organismo e, sim, quais vivem nele.
As doenças causadas por bactérias mais comuns são:

• Botulismo;
• Cólera;
• Sífilis;
• Disenteria;
• Febre maculosa;
Os vírus são responsáveis por problemas complexos e, ao contrário das bactérias, muitas doenças virais não têm cura!
Conheça as principais viroses:
• AIDS;
• Herpes;
• Resfriado Comum;
• Gripe;
• Novo Coronavírus;





• Febre amarela;
• Hepatite;
• Dengue;
• Caxumba;
• Catapora;

• Raiva;
• Varíola;
• Pneumonia bacteriana;
• Gonorreia;
• Hanseníase;
• Leptospirose;
• Tuberculose;
• Tétano.
• Rubéola;
• Sarampo;
• Poliomielite;



• Mononucleose Infecciosa.
É possível contrair essas patologias de diversas formas, com a má higiene, relações sexuais desprotegidas, picadas de insetos, etc.
O modo mais eficaz de combater as doenças bacterianas é com o uso prescrito de antibiótico s ; já no caso das viroses não há medicação específica. Por outro lado, em ambos os cenários, a vacinação é uma grande aliada!
É muito importante que os profissionais intensivistas e emergencistas tenham conhecimento e experiência prática para socorrer vítimas de casos críticos desses agentes. Isso envolve, por exemplo, o correto manejo da Sequência Rápida de Intubação (SRI).
Entre os dias 18, 19 e 20 deste mês, o maior shopping de Natal foi bastante movimentado por modelos, estilistas, estudantes de moda e afins com a edição Outono-Inverno 2023 do Midway Fashion Day’s.


Na programação, bate-papo e talk show todos com representantes do Senai, UNP e SEBRAE RN. “Esse ano, envolvemos empresas que participaram do Kick O da Moda, e convidamos algumas para apresentarem suas coleções, entre elas, George Azevedo Art, DePedro, Marcos Ramalho, Human,


Dali Modas e Moulemar. Esse evento é de grande importância para o setor de moda do Estado “, falou Verônica Melo, do SEBRAE.







No “line up” de lojistas do Midway Mall,

nomes como Riachuelo, Fio a Fio, Carmen Steffens, Taco, Skyler, Toli, Romance Brazil, Litoraneus, A Graciosa, You Com, Morana, Mioche, Blu K, Pratas Art, Live e Stomp. Os desfiles infantis ficaram por conta das lojas Lilica & Tigor, Puket, Bibi e Baton com Bola.

A apresentação do evento ficou sob o comando da Influencer Thay Rosado e toda a estrutura de som, luz e ambientação, da Criativa. Paraocasião,osdesfilestiveramprodução da Revista GLAM e os desfiles também contaram com o seleto cast da Tráfego Models.
Aqui, um resumo dos primeiros dias do evento!
Governo do RN reforça luta por curso de Medicina em Mossoró
Combater as fakes news é importante para reforçar a cultura de paz nas escolas
RN garante reajuste do piso dos professores de forma integral


Planejamento está pronto e prevê a recuperação de toda a malha rodoviária do Rio Grande do Norte. A RN-117, que cruza toda a região Oeste, a partir de Mossoró, é uma das prioridades da ação do governo

RN tem contas públicas equilibradas e sem déficit após 10 anos
Governo do RN apresenta







Porto-Indústria

Verde à maior construtora do mundo
Maricultoras potiguares ganham nova alternativa de renda


 MOSSORÓ (RN), DOMINGO, 23 DE ABRIL DE 2023
MOSSORÓ (RN), DOMINGO, 23 DE ABRIL DE 2023

Acomitiva do Rio Grande do Norte retorna da China otimista com novos e importantes investimentos no estado, a partir das tratativas e parcerias firmadas com empresas e instituições do país asiático. Destaque para a apresentação do projeto Porto-Indústria Verde à maior construtora do mundo, a China Communications Construction (CCCC).
A gigante chinesa está presente em 159 países e construiu sete dos dez maiores portos do mundo. A reunião com CCCC permitiu que a governadora Fátima Bezerra apresentasse o importante projeto, destacado como a principal prioridade para o povo do Rio Grande do Norte, dada a importância de um projeto de desenvolvimento sustentável que vai garantir o crescimento da economia potiguar.
O Porto-Indústria Verde é imprescindível para o setor de energias renováveis eólica e solar, tanto em terra como no mar, inclusive produzindo peças e equipamentos, e para a produção de hidrogênio e amônia verde.
“Agora que temos conhecimento básico sobre o projeto, vamos analisar com mais profundidade. Nós temos uma equipe que vai analisar os dados técnicos e a viabilidade econômica”, afirmou Yun Liang, presidente da CCCC.
“Estou ciente que o projeto é de grande importância para o RN e para o país. Somos engenheiros e como engenhei-
ros ficamos muito felizes quando vemos bons projetos como esse. Esperamos em breve termos resultados concretos”, destacou Liang ao final da reunião em Pequim, com a governadora Fátima e com os secretários de Estado do Desenvolvimento Econômico, Jaime Calado; do desenvolvimento Agrário e Agricultura Familiar, Alexandre Lima; de Comunicação Social, Daniel Cabral; e o coordenador de Desenvolvimento Energético do RN, Hugo Fonseca. O Governo do RN também obteve apoio importante da
embaixada brasileira na China. “A embaixada servirá de ponte para que a CCCC possa receber o máximo de informações possíveis para analisar o projeto que é tão importante para o Brasil e para o RN”, declarou Marcos Brandão, Embaixador do Brasil na China.

A comitiva do Governo do RN também se reuniu com o presidente da State Grid Corporation Of China, Zhang Zhigang, em Pequim. Na ocasião, foi feita a apresentação da ca-

pacidade de produção do Estado no campo das energias renováveis e do atlas eólico.
Aos dirigentes da State Grid a govenadora afirmou que o RN está pronto para ampliar a matriz energética com o offshore e hidrogênio verde.
“Naquilo que depender do Governo do Estado, agora, ao completarmos 10 anos de liderança na produção de energia eólica em nosso país, estamos prontos para assumir o protagonismo dessa nova fase de transformações com a produção do hidrogênio verde”, afirmou.
A comitiva liderada pela governadora Fátima Bezerra conheceu, na Universidade Agrícola da China (CAU), as iniciativas de apoio ao pequeno agricultor e à agricultura familiar. A CAU possui dois mil professores, 25 mil alunos e monitora a utilização de mais de um milhão de máquinas utilizadas naquele país por agricultores familiares.
Estudos apontam que a mecanização promove aumento de 15% na produção e redução de 30% na emissão de carbono.
Em setembro de 2022, por meio do Consórcio Nordeste, o Governo do RN assinou acordo com a CAU que permitiu iniciar a troca de experiências com a instituição e o governo chinês. O objetivo é ampliar e fortalecer parcerias técnico-científicas para modernização da agricultura familiar no RN.
No Brasil, a agricultura familiar produz 70% dos alimentos consumidos pela população, embora o pequeno produtor não seja devidamente remunerado. O país tem enorme potencial de mudança desta realidade social e a mecanização vai contribuir significativamente para isso e, ainda, consequentemente, vai promover melhor qualidade de vida.
Comitiva do Governo do Rio Grande do Norte durante reunião com a CCCC em Pequim, na China
A comitiva do Rio Grande do Norte foi recebida pelo Instituto de Recursos Minerais da Academia Chinesa de Ciências Geológicas (CAGS), na China. Na reunião com o vice-presidente Yan Chengyi, o governo assinou um acordo de cooperação que irá trazer avanços na implantação do Laboratório de Certificação de Gemas no Rio Grande do Norte.
Este é um passo importante para a mineração, especialmente para as pedras
preciosas que são extraídas do estado. A governadora Fátima Bezerra estava acompanhada do secretário Jaime Calado, do Desenvolvimento Econômico, da Ciência, da Tecnologia e da Inovação, e de Luis Guimarães, presidente da Associação SinoBrasileira de Mineração (ASBM). A criação do laboratório de gemas, previsto para ser integrado às instalações do Centro de Tecnologia Mineral do IFRN, em Currais No-
vos, irá abrir o mercado internacional para os produtores de pedras preciosas do Brasil, com foco principal na China e Ásia e potencial para atingir outras partes do mundo.
Com sede em Pequim, a CAGS é a principal organização de pesquisa geológica da China, responsável pela exploração, pesquisa e gestão de recursos minerais e energéticos, proteção ambiental e sustentabilidade.
O Governo do RN, em convênio com o IFRN, promoverá a fundação do Instituto Brasileiro de Gemologia Ensaios e Testes (IBGET), integrado às instalações do Centro de Tecnologia Mineral Professor José Yvan Pereira Leite (CT Mineral do IFRN), com o objetivo de abrigar uma unidade de desenvolvimento de pesquisa, certificação e va-
lorização de gemas e joias no estado.
O equipamento vai ampliar conhecimentos e gerar riquezas no segmento das pedras preciosas e semipreciosas. A certificação de gemas e a lapidação são elementos essenciais para agregar valor ao produto no mercado de pedras preciosas. Estima-se que uma gema certificada pode quadruplicar de preço a depender do tipo, tamanho e do seu grau de pureza.
Entre as ações está a necessidade de combater as fake news, que têm causado temor aos pais e responsáveis
Ocombate as fake news é uma das ações mais urgentes para inibir casos de ameaça à comunidade escolar no Rio Grande do Norte. Esse foi um dos pontos definidos pelo Grupo de Trabalho instituído para tratar de providências a curto, médio e longo prazos quanto aos eventuais casos de ameaça.
Representantes dos três Poderes, além da participação de instituições e entidades ligadas à educação, reuniram-se nesta semana para definir uma estratégia para garantir a paz nas escolas. As notícias falsas foram apontadas por gestores das escolas da rede pública e privada como as maiores causadoras de temor aos pais e responsáveis por jovens estudantes.
As discussões técnicas pretendem a consolidação da “cultura de paz nas escolas”. Além do enfrentamento à desinformação, comum especialmente nas redes sociais, representantes de instituições do Governo do Estado também adotaram medidas de reforço do policiamento ostensivo e preventivo com maior proximidade nas escolas.


Também foram definidas ações de investigação da Polícia Civil do RN e agências de inteligência do Governo Federal, com alguns resultados importantes já obtidos. Algumas pessoas já foram identificadas e todas as medidas legais adotadas, seja quanto ao infrator, ou mesmo de responsabiliza-
ção às respectivas famílias.
As denúncias sobre supostas ameaças, ou situações suspeitas devem ser encaminhadas às autoridades da segurança pública pelos telefones 181 e 190, e evitar o compartilhamento dessas situações por meio de grupos, em redes sociais, ambiente que colabora com o pânico e que podem não chegar a quem de fato pode e deve averiguar: as polícias.
O Governo do Estado começou a divulgação dos canais de denúncia às eventuais situações de risco e ameaças, e tem orientado os gestores das escolas da rede pública e privada quanto à adoção de algumas medidas necessárias neste momento, mas com a cautela necessária. Entre as ações em
discussão está também a definição de protocolos de segurança.
A Secretaria de Estado da Educação, da Cultura, do Es-
porte e do Lazer (Seec) contratou recentemente psicólogos e esses profissionais atuam, inclusive, observando o atual contexto. Na reunião, os repre-
- Denúncias sobre supostas ameaças, ou situações suspeitas devem ser encaminhadas às autoridades da segurança pública pelos telefones 181 e 190;
- Evite o compartilhamento dessas situações por meio de grupos, em redes sociais;
- Evite ambientes que colaboram com o pânico;
- Governo do RN está divulgando os canais de denúncia às eventuais situações de risco e ameaças.
O vice-governador Walter Alves participou representou o Rio Grande do Norte na reunião convocada pelo presidente da República, Luiz Inácio Lula da Silva, para discutir políticas de proteção do ambiente escolar nos estados.
No encontro, o governo federal apresentou um pacote de R$ 3 bilhões para ações nas escolas em reação às ameaças e ataques em unidades de diferentes regiões do Brasil. O
valor destinado a cada federação será definido pelo governo federal.
Walter Alves considerou as medidas anunciadas muito importantes. “Foi debatido como podemos fortalecer uma cultura de paz nas escolas. E no Rio Grande do Norte, esse trabalho já começou com a criação um grupo de trabalho para implementar soluções a curto, médio e longo prazos”, disse.
O Ministério da Educação determinou a antecipação de R$ 1,097 bilhão referentes à parcela de setembro do Programa Dinheiro Direto na Escola (PDDE) e liberou R$ 1,8 bilhão de recursos de anos anteriores que estão parados nas contas das escolas.
Ainda dentro do programa, também foram disponibi-
sentantes de cada instituição ou entidade se comprometeram a atuar em busca de encaminhamentos que contribuam, seja no campo Legislativo, de gestão ou administrativo, e que proporcionem a prática de alguns projetos.
A titular da pasta, professora Socorro Batista, conduziu as discussões do Grupo de Trabalho e destacou a importância dessas medidas sob discussão chegarem com a maior brevidade possível às famílias, de maneira a evitar pânico e apontar também outros rumos diante do tema que está em debate no país e no mundo.
A Assembleia Legislativa do Rio Grande do Norte, por meio da Comissão de Educação, comprometeu-se a agilizar tramitação de matérias, que cheguem à Casa Legislativa, sobre a cultura da paz na comunidade escolar. Já a Ordem dos Advogados do Brasil (OAB-RN) se colocou à disposição para contribuir com eventuais cursos de capacitação a profissionais que atuariam como multiplicadores, via comissões da Seccional RN.

O Tribunal de Justiça do RN e o Ministério Público do Rio Grande do Norte ressaltaram experiências exitosas, como a “Justiça Restaurativa”, que a médio prazo começa a ser implementada no que se refere aos conflitos relacionados às escolas. Marcus Aurélio de Freitas Barros, promotor de Justiça da Infância e Juventude, destacou a prioridade quanto às ações e medidas que busquem passar à sociedade o que de fato está sendo desenvolvido neste momento e manter em outra frente às discussões e trabalho com foco em práticas para médio e longo prazos.
O Grupo de Trabalho volta a se reunir nesta semana, quando serão apresentadas algumas dessas ações voltadas à rede pública e particular de ensino no Rio Grande do Norte.
lizados aos prefeitos e governadores R$ 200 milhões de recursos do Programa de Ações Articuladas (PAA) para que sejam usados na implementação de núcleos psicossociais nos ambientes escolares.
O Executivo Federal já havia anunciado um edital de R$ 150 milhões para a implantação de projetos a fim de projetos a fim de aprimorar a segurança nas escolas em todo o país. No Rio Grande do Norte
os projetos são elaborados em parceria entre as secretarias de Estado da Educação e Cultura (SEEC) e Secretaria de Estado da Segurança Pública (SESED).
O Governo federal repassará recursos para que, diante da aprovação dos projetos, as ações possam ser implantadas. Cada estado deve apresentar a proposta de um projeto, cujo custo global não ultrapasse os R$ 3 milhões.
http://www.rn.gov.br
/governodorn/GovernodoRN/GovernodoRN
Governo vai pagar o novo piso de forma integral e igualitária a ativos e aposentados já neste mês de abril

- Aplicação de 14,95% em abril (em folha suplementar) para os professores que ganham abaixo do Piso, retroativo a janeiro;
- Aplicação de 7,21% em maio para todos que já recebem acima do Piso (ativos, aposentados e pensionistas com paridade);
- Aplicação de 3,69% em novembro; (ativos, aposentados e pensionistas com paridade);
- Aplicação de 3,49% em dezembro (ativos, aposentados e pensionistas com paridade);
- Retroativo quitado em 8 parcelas, entre maio e dezembro de 2024, contemplando ativos, aposentados e pensionistas com paridade
O Governo do RN e o Sindicato dos Servidores da Administração Indireta do Rio Grande do Norte (Sinai) homologaram acordo referente à recomposição salarial de 2022 na ordem de 10,06% para servidores da Ceasa, Datanorte e Emparn. Esses servidores não haviam sido contemplados por lei específica de reajuste ou enquadramento.

A decisão alcança cerca de 1.000 empregados públicos e implicará em um impacto mensal aproximado de 58 mil reais nas despesas do Poder Executivo Estadual.
A homologação do acordo
foi realizada durante sessão de conciliação liderada pela juíza do trabalho Rachel Vilar de Oliveira Villarim, no Centro Judiciário de Solução de Conflitos e Cidadania, do Tribunal Regional do Trabalho da 21ª Região (TRT-RN).
A partir do acordo, o Estado do Rio Grande do Norte, na qualidade de responsável financeiro pelas folhas de pagamento da Ceasa, Datanorte e Emparn, implantará no contracheque de cada servidor abrangido nos autos o reajuste salarial já concedido no salário-base e ADTS de 10,06% sobre as demais verbas de natu-
OGoverno do Rio Grande do Norte é pautado pela coerência e compromisso em defesa da educação pública de qualidade. Essa meta passa pela valorização dos trabalhadores em Educação. É exatamente isso que a atual gestão estadual está cumprindo desde o primeiro momento. O Rio Grande do Norte é o único estado que garante o reajuste do piso salarial dos professores de forma integral, ou seja, para quem está abaixo do piso e para toda a carreira, incluindo os aposentados e pensionistas.

Seguindo essa meta de valorização dos profissionais da Educação, o Governo do RN vai pagar o piso salarial definido pelo Governo Federal de forma integral e igualitária a ativos e aposentados
já neste mês de abril.
O calendário de pagamento foi acordado com a categoria, em mesa de diálogo com o Sindicato dos Trabalhadores em Educação do Rio Grande do Norte (SINTE-RN). Conforme definido, os professores com salários acima do piso receberão o reajuste de 14,95% de maneira escalonada, em três parcelas, nos meses de maio (7,21%), novembro (3,69%) e dezembro (3,49%).
“Os professores entenderam a proposta do governo como sensata e exequível. Propomos o que pode ser suportado pelas finanças estaduais mantendo o compromisso de pagar em dia não só os servidores da Educação, mas de todo o Estado, como é orientação da governadora Fátima Bezerra”, afirmou a secretária de Educação, Socorro Batista.
reza salarial, a partir do mês de junho de 2023.
Os valores brutos mensais das diferenças salariais decorrentes da incidência do reajuste salarial já concedido, correspondente aos meses de março de 2022 a maio de 2023, serão pagos em 10 parcelas mensais, sem multa e juros para o Governo do RN, sendo a primeira em junho de 2023 e a última em março de 2024.
Do valor devido, serão deduzidos os descontos legais como contribuição previdenciária e imposto de renda. Os honorários contratuais devidos por servidor também serão deduzidos, sendo em 10% para associados do Sinai e 20% para não associados.
Professores valorizados fortalecem o ensino público no Rio Grande do Norte
Prevaleceu o diálogo e o entendimento entre o Governo do RN e os servidores da saúde. Na mesa de negociação, foi definida proposta que atende aos anseios da categoria, além de manter o canal aberto para continuar o debate sobre outras pautas. O governo propôs o pagamento de progressão de nível a partir do mês de maio, implementação da gratificação de incentivo à qualificação e implantação do abono de permanência e adicional de insalubridade

automáticos até dezembro. Outra garantia dada pelo governo foi o aumento no valor das diárias pagas aos servidores que viajam a serviço da Secretaria Estadual de Saúde (Sesap/RN), com acréscimos que vão de 60% a 75% em cima dos atuais valores.
A Sesap/RN e os demais entes do governo ainda se comprometeram a avaliar outras propostas, que voltarão ao debate em junho, como o reajuste salarial de 21,87% que a categoria reivindica.
MOSSORÓ

(RN), DOMINGO, 23 DE ABRIL DE 2023 http://www.rn.gov.br
A governadora Fátima Bezerra apresentou ao ministro da Educação, Camilo Santana, apoio à solicitação para a implantação do curso de Medicina na Faculdade Católica, justificando na importância que a abertura de curso terá em Mossoró e toda a região Oeste. O ministro mostrou-se sensível ao pedido da governadora e se comprometeu com o processo de implantação do novo curso.
- Direito
- Ciências Contábeis
- Fisioterapia
- Psicologia
- Teologia
- Nutrição
- Gastronomia
Governo do RN se engajou na luta para Mossoró contar com mais um curso de Medicina. A proposta é da Faculdade Católica do Rio Grande do Norte, instituição mantida pela Associação Santa Teresinha de Mossoró, da Diocese de Santa Luzia que conta com o tradicional Colégio Diocesano (CDSL).Mossoró conta atualmente com três cursos de Medicina, sendo dois em instituições públicas, na Universidade Federal Rural do Semi-Árido (UFERSA) e na Universidade do Estado do Rio Grande do Norte (UERN), e um na faculdade privada Faceme.
Há uma necessidade de ampliar o número de vagas para formação de profissionais da medicina, como forma de atenuar o déficit de médicos e médicas na rede de assistência à saúde. Mossoró é um importante polo econômico do Rio Grande do Norte, segundo município mais populoso, com 300 mil habitantes, e atende à população de toda a Mesorregião do Oeste potiguar e parte dos estados do Ceará e Paraíba, com população total estimada em mais de 800 mil habitantes.
Diante da importância re-

presentada por Mossoró e região, o Governo do RN se dispõe a lutar no Ministério da Educação para que a Faculdade Católica venha a contar com o curso de Medicina. Como o ministro Camilo Santana, que foi governador do Ceará, conhece bem as necessidades da região, inclusive, na área de formação em Medicina, ele assume o compromisso de viabilizar todo o processo.
Além de Mossoró, há também uma necessidade de implantar curso de Medicina na cidade de Pau dos Ferros, no Alto Oeste potiguar, onde existem campus da Uern, Ufersa e faculdades privadas. Inclusive, uma proposta já foi apresentada ao Ministério da Educação para autorizar a abertura de um curso no campus da Ufersa.
Em novo ranking divulgado pela Associação Nacional de Educação Católica do Brasil (ANEC), a Faculdade Católica do Rio Grande do Norte obteve a 2ª posição na lista das melhores instituições de ensino superior do país. Os dados referem-se ao Conceito Preliminar de Curso (CPC) e ao índice Geral de Cursos (IGC), divulgados pelo Ministério da Educação e pelo Instituto Nacional de Estudos e Pesquisas Educacionais Anísio Teixeira (INEP), referentes ao ano de 2021.

A Faculdade Jesuíta de Filosofia e Teologia (FAJE) e a Faculdade Católica do Rio Grande do Norte consagraram-se como destaques pela altíssima pontuação no IGC contínuo. Além disso, a Católica do RN, dirigida pelo padre Charles Lamartine, se mantém como referência para Mossoró e Região pelo brilhante reconhecimento de excelência de todos os seus cursos pelas recentes avaliações do Ministério da Educação.
“A ANEC analisou os resultados e constatou que a Educação Católica segue fir-
me em seu compromisso de oferecer aos jovens estudantes do Brasil uma educação superior de qualidade e relevância. A grande quantidade de notas 4 e 5, maiores conceitos da avaliação, comprovam que nas IES confessionais católicas a excelência acadêmica é palavra de ordem”, destaca o comunicado da ANEC.
Com essa conquista, a instituição tem legitimidade para solicitar ao Ministério da Educação a criação do curso de Medicina. Essa autorização permitirá a formação e capacitação de profissionais de saúde no interior do Estado, reduzindo a migração de jovens para outros centros urbanos e atraindo inteligências que contribuirão para o desenvolvimento local.
Faculdade Católica do Rio Grande do Norte é a 2ª melhor colocada em ranking nacional
Aprestação de contas das receitas, despesas e investimentos públicos referentes ao Governo do RN no ano de 2022 foi entregue à Assembleia Legislativa neste mês de abril. Os números são positivos e comprovam que, pelo segundo ano consecutivo, o Estado não tem déficit, o que comprova que a atual conseguiu recuperar as contas públicas.
O secretário de Estado do Planejamento e Finanças, Aldemir Freire, registra que o Estado passou dez anos com déficit orçamentário que resultou em dívidas com fornecedores e pessoal. Desde 2019, quando o atual governo assumiu, vem sendo feito um trabalho de recuperação que tem apresentado resultados positivos.
“Esta prestação de contas do exercício 2022 tem significado especial porque mostra que o Governo do Estado cumpriu seus compromissos e metas. É o relatório do último ano do primeiro mandato e nos dá a certeza do dever cumprido”, afirma Aldemir.
A Controladora-geral adjunta do Estado, Daniele Assunção, disse que “o Governo cumpre o dever constitucional, conscientiza e dá transparência sobre as contas públicas, aplicabilidade dos recursos e cumprimento das políticas públicas à população.” Por isso, foi possível reorganizar as contas e devolver ao RN o poder de investimentos em ações que beneficiam diretamente a vida das pessoas.

O atual governo quando assumiu, em janeiro de 2019, as dívidas eram de R$ 1,9 bilhão. Hoje, não há déficit, mesmo tendo enfrentado uma pandemia e mudança orçamentária pelo Governo Federal, ano passado, em pleno exercício fiscal, que reduziu a alíquota de imposto (ICMS) sobre combustíveis, serviços e comunicações.
Agora, com as contas equilibradas, é possível o governo ampliar ações, dar continuidade e conclusão de obras importantes como os Institutos Estaduais de Educação Profissional e Tecnológica (IERNs), a barragem de Oiticica em Jucurutu, a conclusão do ramal do Apodi na transposição de águas do rio São Francisco, investimentos de R$ 50 milhões na rede pública de saúde em
todo o Estado, na recuperação e reconstrução da malha rodoviária estadual.

O documento Prestação de Contas Anuais do Governo do Estado do Rio Grande do Norte 2022 contém 1.940 páginas e apresenta os resultados da
gestão do Poder Executivo, além dos números consolidados com o Poder Legislativo, incluindo a Fundação Djalma Marinho, o Poder Judiciário, o Ministério Público do Estado, a Defensoria Pública e o Tribunal de Contas (TCE/RN).
O Balanço Geral do Estado consolida as contas do Estado e de suas autarquias, fun-
dações públicas, empresas estatais dependentes e fundos especiais, observando a legislação do direito financeiro brasileiro, em especial as normas emanadas do TCE/ RN e o Manual de Contabilidade Aplicada ao Setor Público.
Já o Relatório Geral e Circunstanciado do Controle In-
vid”, disse.
O 1º Seminário de Elaboração do Plano Plurianual, realizado agora em abril, reuniu representantes de órgãos da administração direta e indireta do Governo do Estado e de outros poderes. Trata-se da principal peça orçamentária para direcionar a aplicação dos recursos públicos a partir do próximo ano.

O titular da pasta de Planejamento e Finanças, Aldemir Freire, ressaltou que o
grande desafio do PPA é conciliar desejos e possibilidades. “São demandas gigantescas e limitações orçamentárias e financeiras na mesma proporção. Para não frustrar quem acredita no governo, precisamos estabelecer prioridades cabíveis dentro das possibilidades de execução e sempre considerando um futuro de incertezas, como foi o de 2019 quando ninguém esperava a pandemia da Co-
A secretária de Gestão de Projetos, Virgínia Ferreira, afirmou que haverá um monitoramento das metas estabelecidas no PPA. “Não queremos um PPA para ficar no papel. Por isso, precisamos construir diretrizes realistas, prioritárias. Para isso, contamos com a representação de cada órgão para construirmos um Plano transparente e sob a ótica da democracia participativa”, disse a gestora.
O Seminário contou ainda com a palestra da professora doutora Glenda Dantas Ferreira, do Departamento de Ges-
Elisa Elsieterno apresenta a execução dos orçamentos previstos na Constituição Estadual, assim como, dentre outras informações, as realizações nas áreas de educação, saúde, assistência social, previdência social, segurança, investimentos em obras públicas, infraestrutura e atendimento às comunidades rurais.
tão Pública da Universidade Federal da Paraíba. Ela frisou que as limitações financeiras para construção do PPA é uma realidade nacional, sobretudo, a partir da década de 90.
“O PPA não é e não deve ser o único instrumento de planejamento do Estado. Ele deve fazer parte de um alinhamento com outros instrumentos, sendo fundamental a participação da sociedade. É fundamental também que o Governo do Estado olhe os diferentes territórios para definir quais são as iniciativas, metas e indicadores que estão relacionados a cada região”.
MOSSORÓ (RN), DOMINGO, 23 DE ABRIL DE 2023 http://www.rn.gov.br


Com a nova Portaria que regulamenta as ações do Programa de Fortalecimento Emergencial do Atendimento do Cadastro Único no Sistema Único da Assistência Social (Procad-SUAS), o Governo do RN desenvolve uma série de atividades específicas para fortalecer o apoio aos municípios no que diz respeito ao CadÚnico e Novo Programa Bolsa Família. A ação é coordenada pela Secretaria do Trabalho, Habitação e Assistência Social (SETHAS).
A Portaria do Ministério do Desenvolvimento e Assistência Social, Família e Combate à Fome (MDS) nº 871, publicada no dia 29 de março de 2023, regulamenta as ações do Procad SUAS, instituído e aprovado por meio da Resolução MDS/CIT nº 01, de 7 de fevereiro de 2023, da Comissão Intergestores Tripartite (CIT) e Resolução MDS/CNAS nº 96, de 15 de fevereiro de 2023, do Conselho Nacional de Assistência Social (CNAS).

Além disso, diante do novo cenário que favorece a política de assistência social no país, o planejamento da Sethas inclui diálogos do Cadastro Único e Programa Bolsa Família com as Secretarias Nacional de Renda de Cidadania (SENARC) e de Avaliação, Gestão da Informação e Cadastro Único (SAGICAD).
A portaria 871 completa as portarias anteriores, apresentando o direcionamento quanto os objetivos do Procad, bem como as ações e atividades que podem ser realizadas com recursos destinados aos municípios. Agora, explica ela, é garantido que o repasse irá ocorrer. Com isso, ela ressalta a responsabilidade dos municípios para as respectivas execuções financeiras, reprogramações e prestação de contas de acordo com as normativas.
- Apoio técnico, capacitação e formação continuada;

- Diálogos do Cadastro Único e PBF, com a Secretaria Nacional de Renda de Cidadania (SENARC) e Secretaria de Avaliação, Gestão da Informação e Cadastro Único (SAGICAD);


- Capacitação de novos multiplicadores para entrevistadores do Cadastro Único;
- Capacitação do Sistema V7 com a Caixa Econômica. Estas são ações de formações presenciais e remotas ofertadas aos técnicos(as) e
gestores(as) do CadÚnico e do PBF para serem habilitados(as) a utilizar corretamente o Sistema V7 e o Sistema de Gestão de Benefícios;
- Diálogo permanente com as Coordenações Municipais.
O Programa de Fortalecimento Emergencial do Atendimento do Cadastro Único no Sistema Único da Assistência Social (PROCAD - SUAS) é o recurso utilizado para fortalecer as ações do CadÚnico. “É importante que as coordenações municipais acompanhem os informes compartilhados pela SETHAS com as respectivas orientações para aplicação e prestação de contas desse recurso”, enfatiza a subcoordenadora da Vigilância Socioassistencial.
O governo federal programou o depósito das parcelas para o mês de abril. Todos os municípios receberão de acordo com o porte, sendo o valor mínimo de R$12.000,00 e terão acesso ao valor por meio do Visdata, o Sistema de Gerenciamento e Visualização dos diversos programas, ações e serviços do MDS. O pagamento será em parcela única.


Para execução do recurso, o município precisa elaborar o Plano de Ação e garantir a prestação de contas, seguindo Portaria MDS nº 113, de 10 de dezembro de 2015.
A Sethas já compartilhou nos grupos oficiais institucionais com as coordenações municipais do CadÚnico e PBF, todos os documentos necessários para o acesso aos recursos disponibilizados pelo Governo Federal. A COGESUAS mantém diálogo permanente com as coordenações municipais. É importante ressaltar que está previsto para ser lançado um manual do Procad, que o Governo está elaborando.
Os beneficiários do Cadastro Único, na hora da entrevista com os requerentes à inclusão nos benefícios federais, devem estar atentos ao perfil unipessoal, maior público impactado com as averiguações e encontro de inconsistências.
A Família Unipessoal corresponde às pessoas que se cadastraram como se vivessem sozinhas. Ou seja, era composta por apenas um membro, inscrita no Cadastro Único para Programas Sociais do Governo Federal, e que tiveram cadastros incluídos ou atualizados de novembro de 2021 a outubro de 2022, com renda familiar de até meio salário mínimo por pessoa.
O Novo Programa Bolsa Família dá continuidade à versão original. Retoma estratégias não exigidas durante o Programa Auxílio Brasil quanto às condicionalidades e readequa o cálculo para o benefício de acordo à estrutura familiar beneficiada.
A nova estrutura do Cadastro Único tem como foco o Bolsa Família, seguindo a garantia de renda para a nova geração famílias beneficiárias.

profissional facilita o retorno do privado de liberdade à sociedade e reduz a reincidência criminal
OGoverno do Rio Grande do Norte, por meio da Secretaria de Administração Penitenciária (SEAP), vem ampliando as ações que promovem a recuperação de internos do sistema prisional por meio da qualificação profissional e do trabalho. É o caminho daqueles que buscam um recomeço. A capacitação profissional facilita o retorno à sociedade e reduz a reincidência criminal.

Um exemplo disso foi a reforma do Presépio de Natal, obra arquitetônica de Oscar Niemeyer que estava abandonada, que recebeu as novas instalações da SEAP e monitoramento por câmeras. A obra foi totalmente executada utilizando mão de obra de pessoas privadas de liberdade, resultando em cerca de 40% de economia para o Estado. No local funciona o Escritório Social e a Central Integrada de Alternativas Penais. Os Escritórios Sociais são voltados ao atendimento dos egressos do sistema prisional.
Atualmente, 22 pessoas privadas de liberdade da Penitenciária Estadual de Alcaçuz, em Nísia Floresta, participam do curso de pedreiro de alvenaria, ofertado pela SEAP por meio do Serviço Nacional de Aprendizagem Industrial (SENAI). Eles buscam de uma nova profissão e um recomeço.

Outros 100 internos de todo Estado estão matriculados em oficinas produtivas visando à capacitação profissional.
O curso é diário e, em 160 horas/aula teórica e prática, habilitará o aluno na leitura de plantas arquitetônicas, marcação de obra, cálculo de quantitativo de material, amarração de paredes, elevação de paredes, uso de prumo, execução de piso, entre outras disciplinas.
“As avaliações são diárias para a obtenção do certificado. Esperamos contribuir para a mudança de realidade de todos que concluírem o curso”, disse o instrutor de Formação Profissional do SENAI, Francisco das Chagas.
A Secretaria de Administração Penitenciária incentiva à capacitação profissional no sistema penitenciário como forma de facilitar o retorno do privado de liberdade à sociedade e para reduzir a reincidência criminal.
Todas as atividades envolvendo educação e trabalho são supervisionadas por equipes de policiais penais, que cuidam de toda rotina de segurança. Os internos capacitados são em-
Levantamento realizado pelo Departamento Penitenciário Nacional (DEPEN), divulgado no final de 2022, apontou que o Rio Grande do Norte é o sétimo estado, entre as 27 unidades da federação, com mais atividades educacionais no Brasil. O resultado é expressivo ao se compa-
rar com o ano de 2018, quando o RN era o último colocado. Os números confirmam os avanços realizados na educação como mecanismo de ressocialização. Segundo o último ranking, 74,27% dos internos em regime fechado do Estado estão envolvidos em alguma atividade educa-
pregados em projetos de reinserção social da Administração Penitenciária em atividades no
próprio Sistema Penitenciário ou em convênio com outras secretarias para reformar esco-
las, hospitais, equipamentos como macas e carteiras escolares, além de prédios públicos.

SENAI FOI CONTRATADO PELA SEAP PARA OS SEGUINTES CURSOS:
- Costureiro industrial de vestuário em malha, no Complexo Penal Estadual Agrícola Dr. Mário Negócio Feminino, em Mossoró;
- Pedreiro de alvenaria, na Penitenciária Rogério Coutinho Madruga, em Nísia Floresta;
- Encanador hidráulico e pedreiro de alvenaria, na Penitenciária Estadual Dr. Francisco Nogueira Fernandes, em Alcaçuz, Nísia Floresta;
- Eletricista no Complexo Penal João Chaves Feminino, em Natal.
cional, seja matriculado nos cursos regulares de educação fundamental ou ensino superior, cursos de qualificação ou projetos de leitura no cárcere, este último envolvendo mais de 4 mil internos dos regimes fechado e semiaberto. Em sala de aula são, aproximadamente, 900 internos estudando regularmente.

O recorde de pessoas privadas de liberdade inscritas no último Exame Nacional do Ensino Médio das Pessoas Privadas de Liberdade (ENEM PPL), que ocorreu em janeiro de 2023,
também confirma a importância da política social dentro do sistema prisional. Foram 1.378 internos realizando as provas. O quantitativo é o dobro do registrado em 2021. O exame é utilizado como mecanismo de acesso à educação superior. Atualmente, 78 detentos fazem curso superior no Estado e outros 800 estão matriculados em cursos regulares. Outro recorde foi a realização do Exame Nacional para Certificação de Competências de Jovens e Adultos para Pesso-
as Privadas de Liberdade (Encceja Nacional PPL), para 2.632 internos do regime fechado. Em quatro anos (entre 2019 a 2022), o RN saiu de último para quarto colocado em número de inscritos no Encceja, no Brasil, proporcionalmente ao tamanho do sistema prisional.
Para o ENEM PPL e o ENCCEJA PPL, os internos se prepararam o ano inteiro por meio de aulas a distância e cursos regulares nas unidades prisionais, em parcerias com instituições públicas e voluntárias.

Aprodução de mudas de cajueiro utilizando mão de obra carcerária está a todo vapor nas estufas da Penitenciária Agrícola Doutor Mário Negócio, em Mossoró. Neste mês, 10 mil mudas foram entregues a agricultores de Carajás, zona rural de Porto do Mangue. Em 2023, o sistema penitenciário do Rio Grande do Norte já produziu 52.200 mudas e a previsão é atingir 165 mil até dezembro.

A Secretaria da Administração Penitenciária (SEAP) desenvolve dois projetos envolvendo a cajucultura em Mossoró. Um na unidade prisional masculina e outro no estabelecimento feminino. O projeto “Semeando a Cidadania” na unidade masculina conta com a parceria do Poder Judiciário, Banco do Nordeste, Prefeitura de Porto do Mangue, COOAPESCA, Secretaria de Agricultura de Carnaubais, Comunidade/Cooperativa Novos Pingos de Assú, e prevê a produção 65 mil mudas.
Atualmente, 16 privados de liberdade trabalham na ação de ressocialização, com apoio da Vara de Execuções Penais de Mossoró (VEP), por
meio da juíza Cinthia Cibele. A cada três dias de trabalho, o interno tem um dia da pena remido. A Justiça, por meio de recursos pecuniários, colaborou na construção de estufas nas dependências do estabelecimento penal onde são pro-
Um projeto de cidadania no Complexo Penitenciário de Alcaçuz, no município de Nísia Floresta, vem beneficiando cerca de 2,6 mil pessoas privadas de liberdade, tendo como foco o atendimento de saúde de 100% da população carcerária.

Ação da Senappen com articulação da SEAP/RN e apoio da Fiocruz, do Ministério da Saúde e das secretarias de Saúde do RN e de Nísia Floresta, oferece atendimentos de triagem, testagem rápida para HIV, sífilis e hepatites virais, coletas de amostras para exames laboratoriais e de tuberculose, além de aplicações de vacinas e palestras para educação e cuidado em saúde. Os profissionais da segurança também são atendidos e recebem as vacinas imunizantes para covid-19, influen-
za e febre amarela.
A ação ocupa todos os pavilhões para atender todas as pessoas privadas de liberdade do complexo prisional, que compreende a Penitenciária de Alcaçuz, a Penitenciária Estadual Rogério Coutinho Madruga e, ainda, os detentos provisoriamente transferidos do Complexo Penitenciário João Chaves, que passa por ampla reforma estrutural.
A organização da iniciativa inclui uma complexa estratégia de saúde e de segurança durante os atendimentos, com a participação de mais de 50 profissionais da saúde, entre médicos, técnicos de enfermagem, enfermeiros e psicólogos, além de assistentes sociais, representantes da Secretaria de Vigilância em Saúde e Ambiente e da
duzidas e enxertadas as mudas de cajueiro.
O projeto envolvendo as instituições tem o objetivo de fortalecer a cadeia produtiva da cajucultura, melhorando a produção, a renda e a qualidade de vida dos agricultores e
suas famílias.
Segundo o diretor da penitenciária de Mossoró masculina, Rodolpho Saldanha, cerca de 40 mil mudas já foram produzidas pelos internos em 2023. “O trabalho envolve a seleção das castanhas, o plan-
tio, o manejo e toda a manutenção da estufa. O interno envolvido no projeto contribui com um importante serviço para a sociedade através da revitalização da cajucultura”, disse.
Já na Penitenciária Doutor Mário Negócio Feminina, a meta do projeto “Cultivando a Cidadania” para 2023 é ousada: 100 mil mudas. Segundo a diretora, policial penal Águida Larissa, 33.605 enxertos foram realizados até a primeira semana de abril e 12.200 mudas de cajueiro já foram doadas. Onze internas trabalham no cultivo de manhã e estudam à tarde.
Na unidade feminina, participam da ação a SEAP e a Secretaria de Agricultura, da Pecuária e da Pesca (SAPE), com apoio da Vara de Execuções Penais de Mossoró (VEP).
O projeto não tem fins lucrativos e as mudas são distribuídas de forma gratuita. As mudas de cajueiro anão precoce são destinadas para doação aos afetados pela seca e já mudou a paisagem de muitas comunidades rurais onde o fruto já é produzido em grande escala.

Em 2022, foram feitas doações de 30 mil mudas aos municípios de Rafael Godeiro, Boa Saúde, São Bento do Norte, Pedra Grande, Viçosa, Lagoa Nova, Ceará-Mirim, São Gonçalo do Amarante, Umarizal, Severiano Melo, Riacho da Cruz; Upanema, Paraú, João Dias, Triunfo Potiguar, Florânia, São Fernando, Lucrécia, Doutor Severiano, Portalegre, Luís Gomes, Serrinha dos Pintos, Lagoa Nova e Mossoró.
A iniciativa das ações de cidadania surgiu como resposta às crises vindas de rebeliões em 2017 nos estados do Rio Grande do Norte, Amazonas e Roraima.
As ações visam ofertar um reforço à assistência à saúde – e demais aspectos que demandem reforço nas unidades – para promover o direito à saúde e à assistência social das pessoas privadas de liberdade e da comunidade carcerária como um todo.
Pessoas privadas de liberdade são atendidas com ações voltadas à saúde
A ação de cidadania no Complexo Penitenciário de Alcaçuz é realizada no âmbito do Projeto Valoriza: Saúde em Foco, uma iniciativa da Senappen com a Fiocruz para a promoção da saúde, do bem-estar e qualidade de vida dos servidores penitenciários, mas também para a saúde das pessoas privadas de liberdade.
Internos trabalham nas estufas da Penitenciária Agrícola Doutor Mário Negócio, em MossoróMudas são doadas aos afetados pela seca; em 2022, 30 mil mudas foram destinadas a 25 municípios potiguaresSEAP - Assessoria Augusto Bezerra Secretaria de Atenção Primária à Saúde do Ministério da Saúde, servidores de segurança da For- ça de Cooperação Penitenciária (FOCOPEN) e policiais penais estaduais.

http://www.rn.gov.br
/governodorn/GovernodoRN/GovernodoRN
OMinistério do Desenvolvimento Regional confirma a liberação dos recursos para a execução de importantes obras de segurança hídrica para no Grande do Norte: o Complexo Oiticica, na região do Seridó, e o Ramal Apodi, na região Oeste.
O investimento, no total de R$ 62 milhões, foi garantido pelo ministro da Integração e do Desenvolvimento Regional, Waldez Góes, em contato, por telefone, com a governadora
Fátima Bezerra. A conclusão das obras de segurança hídrica no RN faz parte do pacote de obras prioritárias apresentado pela governadora ao Governo Federal em janeiro deste ano. Na ocasião, o presidente da república Luiz Inácio Lula da Silva, reunido com os governadores de todos os estados, afirmou a execução de um plano de ações e obras prioritárias.
O Complexo Oiticica inclui a barragem Oiticica e as obras sociais, como as agrovilas. O Go-
verno do RN recebeu a garantia de liberação de recursos no valor de R$ 19 milhões para a conclusão da obra. Atualmente, a barragem Oiticica encontra-se com 93,27% de obra executada, com previsão de conclusão para dezembro deste ano.
“É motivo de grande alegria a liberação desses recursos, tão necessários para executar nossas obras prioritárias em infraestrutura hídrica, e assim podermos avançar no desenvolvimento econômico e social para
a população do nosso estado”, destacou a governadora.
Já o ramal do Apodi, que vai levar água da transposição do rio São Francisco para o Oeste potiguar, receberá R$ 43 milhões de reais para a continuidade da obra. O prazo de entrega foi antecipado e a chegada da água ao Rio Grande do Norte está prevista até 2025.


O secretário do Meio Ambiente e dos Recursos Hídricos, Paulo Varella, salienta que a partir da liberação, as obras po-
derão ter sua continuidade para garantir segurança hídrica para a região.
O Ramal do Apodi faz parte do Projeto de Integração do Rio São Francisco com (PISF) e vai levar a água do Eixo Norte a 54 municípios nos estados do Rio Grande do Norte (32), Paraíba (13) e Ceará (9), beneficiando 750 mil pessoas. As águas do “Velho Chico” chegam ao RN por meio de duas entradas: pelo ramal Apodi e pelo ramal Piranhas-Açu.

Barragem de Oiticica encontra-se com 93,27% de obra executada

Números

62 mi 43 mi 19 mi 93,27% 32
de reais serão liberados para o RN de reais para obras do Ramal Apodi de reais para conclusão do Complexo Oiticica de obra concluída da barragem de Oiticica cidades da região Oeste serão beneficiadas com Ramal Apodi

O Governo do RN assinou neste mês de abril o projeto de revisão da segunda etapa da Meta 2 do Programa de Infraestrutura de Transporte e da Mobilidade Urbana – PróTransporte, na Zona Norte de Natal. A assinatura garante o repasse final dos recursos para a continuidade e conclusão desta etapa. Com isso, o trecho do entroncamento da Avenida Moema Tinoco ao Viaduto da
Avenida das Fronteiras será finalizado.
O Pró-Transporte é originário do Ministério das Cidades e tem por objetivo financiar o poder público e a iniciativa privada de infraestrutura de transporte coletivo urbano, com a realização de obras viárias, que contribuem para melhoria do fluxo de veículos e pedestres nas vidas públicas dos municípios.
A previsão é que essa etapa será concluída em março de 2024. Além disso, o Governo do Estado assegurou com o ministro das Cidades, Jader Filho, a liberação dos recursos para a realização da terceira e última etapa da importante obra.
Natécia Nunes, diretorageral do DER, confirma que o projeto básico à terceira etapa já foi concluído e o próximo passo será apresentá-lo ao Ministério das Cidades.
A continuidade e conclusão da obra do Pró-Transporte na Zona Norte de Natal faz parte do pacote de obras prioritárias apresentado ao Governo Federal em janeiro deste ano,
quando também o foi realizada reunião complementar com o secretário Nacional de Mobilidade Urbana, Marcos Daniel, para discutir a possibilidade de um aporte de recursos suficientes para a conclusão da obra. Após a audiência, o governo enviou toda a documentação necessária para o Ministério das Cidades e então recebeu a confirmação de que serão repassados os valores restantes.
O Pró-Transporte é considerado um dos projetos mais importantes para a mobilidade urbana da Região Metropolitana de Natal. Quando estiver concluído, o complexo viário
beneficiará mais de 400 mil pessoas entre Natal e municípios da Região Metropolitana. O Governo do Estado, por meio do DER-RN e da Secretaria de Infraestrutura do Rio Grande do Norte, retomou os trabalhos na 2ª etapa das obras do Programa Pró-Transporte, na Zona Norte da capital, em junho de 2021. A atual gestão resolveu todas as pendências com projetos e licenciamentos para retomada das obras que foram iniciadas em 2005, sob a responsabilidade da Prefeitura de Natal e, depois de um longo tempo paralisadas, transferidas para o Governo do Estado.
Conclusão das obras de segurança hídrica no estado faz parte do pacote de obras prioritárias apresentado pelo governo
MOSSORÓ (RN), DOMINGO, 23 DE ABRIL DE 2023 http://www.rn.gov.br
Arecuperação da malha viária estadual, que tem sido castigada pelo grande volume de chuvas, é prioridade do Governo do Rio Grande do Norte. O Estado vai investir, de imediato, R$ 62 milhões que contemplará sete distritos rodoviários, beneficiando todas as regiões do RN.
A Secretaria Estadual de Infraestrutura (SIN) e o Departamento de Estradas e Rodagens (DER/RN) assinaram um total de sete contratos relativos às obras de conservação de rodovia. A etapa de execução destas obras faz parte das primeiras ações previstas pelo planejamento de manutenção e recuperação da malha viária estadual.
Há um planejamento do Governo do RN para a recuperação das estradas, que começa com a conservação dos casos urgentes, passa pela restauração de trechos críticos e culmina em obras de maior complexidade, como a construção de novas estradas e requalificação com aumento de capacidade de rodovias já existentes. Os projetos prontos, segundo o secretário da Infraestrutura Gustavo Coelho.
A segunda etapa deste planejamento também terá início o mais rápido possível, com a publicação dos editais de licitação. Os processos licitatórios contemplarão a restauração de diversos trechos críticos, intervenção que consistirá em ações mais profundas do que as realizadas no primeiro nível do planejamento.
A previsão é que as obras comecem a partir de julho e, assim como na primeira etapa, todos os sete distritos rodoviários do estado serão contemplados. O investimento total será de R$ 150 milhões entre 2023 e 2024, com recursos do próprio Governo do RN.

Já a terceira fase contará com aporte de recursos federais e compreende a implantação de novas rodovias novas, além da readequação e do aumento da capacidade de rodovias já existentes.

- 1º Distrito Rodoviário (DR), sediado em Mossoró: RN-117 (Mossoró - Caraúbas - Olho d’Água do Borges); RN-015 (Mossoró - Baraúna - Divisa RN/CE); RN-016 / RN-404 (Entroncamento BR-404 - Assú - Carnaubais - Porto do Mangue);

- 2º DR – sediado em Caicó: RN-118 (Caicó - São João do SabugiIpueira - Divisa RN/PB); RN-041 (Currais Novos - Lagoa Nova); RN-086 (Parelhas - Equador - Divisa RN/PB); RN-288 (Caicó - Acari).
- 3º DR - sediado em João Câmara: RN-221 (Guamaré - Macau); RN023 (Touros - João Câmara); RN-120 (João Câmara - Bento FernandesEntroncamento BR-304);
O Departamento de Estradas e Rodagens (DER/RN) trabalhou com agilidade para garantir a retomada do trânsito pela RN-117, entre os municípios de Caraúbas e Olho d’Água do Borges, na região Oeste, no trecho que houve rompimento devido às fortes chuvas registradas neste mês de março.
Uma equipe técnica fez o isolamento da rodovia para evitar acidentes e, em seguida, de forma emergencial, iniciou a construção de um desvio paralelo ao trecho que cedeu da RN117, a fim de permitir o tráfego de veículos.
A obra de recuperação da
rodovia será iniciada logo. A Secretaria de Infraestrutura aguarda autorização da Procuradoria Geral do Estado (PGE) para dar prosseguimento aos trâmites de contrato emergencial para a recomposição da via.
A RN-117 cedeu devido à atípica acumulação de grande volume de água, em pouco espaço de tempo, sobrecarregando o sistema de drenagem, o que ocasionou a erosão e resultando no seccionamento da rodovia. Segundo a Emparn, no dia que houve o rompimento, foram registrados 128 mm em apenas quatro horas de precipitação.
- 4º DR - sediado em Nova Cruz: RN-023 (BR 226 - Lajes Pintadas); R-093 (Sítio Novo - Passa e Fica); RN-120 (Serra Caiada - Santo Antônio);

- 5º DR - sediado em Natal: RN-064 (Santa Maria - Ceará-Mirim); RN-312 (Macaíba - Igreja Nova); RN-002 (Georgino Avelino - Entroncamento BR-101); RN313 (Entroncamento BR-101 - Pium); RN-063 (Tabatinga - São José de Mipibu).
- 6º DR - sediado em Pau dos Ferros): RN-177 (São Miguel - EncantoPau dos Ferros); RN-079 (Alexandria - Marcelino Vieira - Entroncamento BR-405); RN-117 (Serrinha dos Pintos - Martins - Umarizal - Olho d’Água do Borges - Umarizal - Itaú).
- 7º DR - sediado em Santana do Matos: RN-263 (Angicos - Afonso Bezerra - Pedro Avelino); RN-118 (Macau - Pendências - Alto dos Rodrigues - Ipanguaçu - São Rafael - Jucurutu).
Máquina trabalha na construção de um desvio na RN-117 entre Caraúbas e Olho d’Água do BorgesPlanejamento que está pronto prevê a recuperação de toda a malha rodoviária do Rio Grande do Norte
http://www.rn.gov.br
/governodorn/GovernodoRN/GovernodoRN
As maricultoras do Rio Grande do Norte ganharam uma nova e importante alternativa de renda com o cultivo da macroalga Kappaphycus Alvarezzi. A ótima notícia consta na emissão de Nota Técnica nº 4/2023, do Instituto Brasileiro de Meio Ambiente e dos Recursos Naturais Renováveis (IBAMA). É o resultado de dois anos de estudos e articulações para comprovar a viabilidade ambiental no litoral do Rio Grande do Norte.

Para conseguir a liberação, o Estado criou um Grupo de Trabalho coordenado pelo subsecretário de Pesca e Aquicultura da Secretaria Estadual da Agricultura, da Pecuária e da Pesca (SAPE/RN), David Soares, e formado por pesquisadores da Universidade Federal do Rio Grande do Norte (UFRN), Universidade Federal Rural do Semi-Árido (UFERSA), Universidade Federal do Rio de Janeiro (UFRJ) e Instituto Federal do Rio Grande do Norte (IFRN), além de colaboradores independentes.
“O Governo do RN preza pela proatividade e muito diálogo, com foco nos resultados que beneficiem o conjunto da sociedade e com responsabilidade ambiental. O cultivo da Kappaphycus Alvarezii além de preservar nossos bancos de algas nativas, fomentará uma nova atividade aquícola que encontra no Rio Grande do Norte condições climáticas mais favoráveis para o seu desenvolvimento”, afirma David Soares. “O próximo passo, seguindo as condicionantes da Nota Técnica do Ibama, é a comprovação de que esta macroalga não é invasora”, adiantou.
O titular da SAPE/RN, Guilherme Saldanha, comemorou o resultado. “A Kappaphycus Alvarezii tem um potencial incrível para a produção de potássio, usado nos fertilizantes, e de carragenana, muito utilizada na indústria de cosméticos e alimentos. Na gestão da professora Fátima Bezerra nós teremos uma nova atividade econômica gerando emprego e renda para o povo potiguar”, enfatizou o secretário.
Para o professor Dárlio Teixeira, da UFRN, a liberação foi um passo muito positivo. “Agora precisaremos responder a alguns quesitos técnicos relacionados ao manejo, mas todos dentro de nossa área de compe-
tência”, explicou.
O professor Maulori Cabral, também da UFRN, ressaltou que o Rio Grande do Norte já
está preparado para responder, de forma concreta e objetiva, as questões condicionantes abordadas pela Nota Técnica.
A Kappaphycus Alvarezii é uma espécie de macroalga marinha robusta e seu cultivo já está introduzido em mais de 20 países. O interesse nessa alga se dá, principalmente, por ser a matéria-prima para a produção de ficocolóides conhecidas como carragenanas.

O potencial do uso das algas marinhas é conhecido mundialmente devido à grande variedade de usos e aplicações industriais que vão desde a alimentação direta em humanos, em animais, em coloides, cosméticos, medicamentos e biofertilizantes agrícolas.
A Kappaphycus alvarezii gera a maior quantidade de biomassa por hectare por ano, quando comparadas com outros sistemas vegetais. O potencial econômico do cultivo destes organismos, uma vez que são sequestradoras de gás
carbônico (CO2) a partir da fotossintetização, constitui uma fonte natural de biofertilizantes, que podem favorecer diversas atividades produtivas, a exemplo da agricultura – por meio do plantio para obtenção de alimentos – como para biocombustíveis. O Crédito de Carbono é mais um produto a ser explorado, a médio ou longo prazo, por esta cadeia produtiva.
A macroalga Kappaphycus alvarezii é, principalmente, utilizada como fonte de matéria-prima para a produção de ficocolóides conhecidas como Carragenas, utilizadas como estabilizantes e espessantes na indústria alimentícia (produtos cárneos, bebidas, chocolates, rações, cosméticos, etc.), representando um mercado mundial da ordem de US$ 6,00 milhões anualmente.
“No que se refere ao delineamento de possíveis áreas propícias para o cultivo e as estratégicas que aqui serão usadas
para assegurar os critérios de vigilância ambiental no monitoramento da atividade”, concluiu o professor.
Parâmetros para escolha da instalação do cultivo das algas
- Temperatura da água do mar acima de 20°C durante todo o ano;
- Salinidade acima de 25 ppt;

- Zonas protegidas do embate de ondas fortes (preferencialmente, devem ser escolhidas enseadas protegidas);
- Profundidade máxima de 20 metros;
- Áreas livres do tráfego de embarcações e turismo.

secretário adjunto da Sape, Marcelo Pessoa.
É por isso que o Governo do Estado, por meio da Secretaria de Agricultura, faz questão de promover o Circuito de Exposições. “Este ano estamos investindo cerca de R$ 3 milhões para o circuito. E esperamos que ano que vem esse valor seja maior e tenhamos mais que os 34 eventos marcados para este ano”, disse Pessoa.
O Governo do Estado aproveitou a ExpoNovos para promover exposição das ações e serviços de Secretarias Estaduais e órgãos da Administração Indireta. A Empresa de Pesquisa Agropecuária do RN (Emparn) apresentou bovinos das raças Sindi, Gir e Guzerá e fez a distribuição de raquetes de Palma Forrageira para produtores rurais da região.
O Instituto de Assistência Técnica e Extensão Rural (Emater/RN), em parceria com a Secretaria Municipal de Currais Novos, promoveu o espaço denominado “Fazendinha”, uma unidade demonstrativa que expôs temas inerentes à convivência com o semiárido, como barragens subterrâneas e cisternas, entre outros.
OGoverno do Rio Grande do Norte vai investir cerca de R$
3 milhões com o Circuito Agropecuário deste ano, que contemplará mais de 30 municípios. O investimento é justificado no entendimento da importância e necessidade no desenvolvimento rural que ganha um grande impulso com o conjunto de
eventos em todas as regiões do estado.
O calendário foi aberto na cidade de Currais Novos, na região do Seridó, com Exposição Agropecuária (ExpoNovos) no Parque José Bezerra de Araújo. A programação incluiu Torneio Leiteiro Bovino e Caprino, Julgamento de Raças, Leilão, Feira de Negócios, atrações culturais e shows
musicais, entre outros.
Na abertura, o governador em exercício Walter Alves frisou que o circuito promove grande volume de negócios e também movimenta a economia em geral, com geração de renda para grandes e pequenas empresas. A ExpoNovos reuniu cerca de 1.500 animais.
“As exposições agropecuá-


rias são de extrema importância para as cidades potiguares, uma oportunidade de geração de renda que se estende desde os que vêm para vender seus animais e serviços como para os comerciantes da cidade e também os empreendedores que aproveitam as feiras para vender algum serviço ou produto”, afirmou Walter Alves, que esteve acompanhado do

O Instituto de Gestão das Águas do Estado (Igarn) também esteve presente realizando o cadastramento de usuários de água de Currais Novos e região. E a Agência de Fomento do RN (AGN) montou uma equipe de consultores da instituição, atendendo o público em um estande e oferecendo a linha de crédito Pró-Pecuária. O financiamento é voltado, especialmente, para os produtores da pecuária do estado do Rio Grande do Norte.
O Circuito de Exposições conta, ainda, com a parceria de Secretarias estaduais, órgãos da administração indireta, instituições financeiras, Prefeituras e diversas entidades ligadas ao setor como a Associação Norte-Riograndense de Criadores (Anorc) e a Associação Norte-Riograndense de Ovinos e Caprinos (Ancoc).
- Exponovos

Currais Novos - 13 a 16 de abril
- Festa do Cavalo
Parnamirim - 27 a 29 de abril
- Expo Potengi
São Paulo Potengi - 12 a 14 de maio
- Expo Caicó
Caicó - 25 a 28 de maio
- Expo Coronel Ezequiel
Coronel Ezequiel - 9 a 11 de junho
- Parelhas


Parelhas - 16 a 18 de junho
- Acari





Acari - 23 a 25 de junho
- Expoeste
Caraúbas - 30 de junho a 2 de julho
- Nova Cruz
Nova Cruz - 7 a 9 de julho
- Feira de Apodi
Apodi - 14 a 16 de julho
- Feira de Afonso Bezerra

Afonso Bezerra - 21 a 23 de julho
- ExpoAssú
Assú - 28 a 30 de julho
- AgroFest São Gonçalo do Amarante - 28 a 30 de julho
- Festa do Bode
Mossoró - 10 a 13 de agosto
- Feira de Jandaíra
Jandaíra - 18 a 20 de agosto
- Expofruit

Mossoró - 23 a 25 de agosto
- ExpoLajes
Lajes - 25 a 27 de agosto
- Expo Upanema
Upanema - 8 a 10 de setembro
- Festa do Boi
Parnamirim - 7 a 15 de outubro
- Fenacam Natal - 14 a 17 de novembro
- Expo Jaçanã
Jaçanã - 14 a 17 de dezembro
Exposições e feiras têm grande importância para a economia e fortalecimento do agronegócio no estadoSandro Menezes Governador em exercício Walter Alves confere produtos da agricultura familiar na ExpoNovos em Currais Novos
OHospital Giselda Trigueiro é uma das principais unidades da rede de saúde do Rio Grande do Norte, sendo a referência para o tratamento de doenças infectocontagiosas, informação toxicológica e imunobiológicos especiais. A unidade, coordenada pela Secretaria de Estado da Saúde Pública (Sesap/RN), tem em abril o mês especial, pois celebra 80 anos de funcionamento (veja história nessa página).


Localizada no bairro das Quintas, zona oeste de Natal, o hospital é historicamente responsável pela linha de frente nos cuidados de casos de HIV, meningites, doença de Chagas, tuberculose, dengue, febre tifóide, sarampo, coqueluche, difteria, entre outros. Mais recentemente, O HGT reforçou seu perfil para cuidar de pacientes acometidos por doenças novas, como a Covid19 e a MPOX.
“O Giselda Trigueiro vem
- HIV
- Meningites
- Doença de Chagas
- Tuberculose

- Dengue
- Febre tifóide
- Sarampo

- Coqueluche
- Difteria
- Covid-19
- MPOX
salvando vidas durante todas essas décadas. Continuaremos nos esforçando para atender cada vez melhor os usuários do SUS com toda dedicação. Que muitos outros oitenta anos venham pela frente”, afirma o secretário de Saúde do RN, Cipriano Maia.

Desde 2019, o Governo do Estado, por meio da Sesap, vem investindo na qualificação do hospital, desde melhorias na infraestrutura até abertura de novos leitos, em especial du-
rante a pandemia. A unidade conta com 27 leitos de UTI para receber casos graves de Covid-19, além de outros 32 leitos de UTI para casos gerais e outras dezenas de leitos de enfermaria.
“Ao longo desses anos, este hospital jamais se furtou a tratar de todas as pandemias, endemias. Fica aqui a gratidão a todos que construíram a história desse hospital”, destaca André Prudente, diretor do Giselda Trigueiro.
Em 14 de abril de 1943, foi inaugurado o prédio onde hoje funciona o Hospital Giselda Trigueiro. Inicialmente nomeado de Sanatório Getúlio Vargas, era destinado ao tratamento de pessoas com tuberculose pulmonar. Ao lado funcionava o Hospital Evandro Chagas, que era a referência no RN para o tratamento das outras doenças infecciosas.
Em 1982, foi feita a fusão dos dois hospitais, prevalecendo a denominação de Hospital Evandro Chagas, sob a direção
Em pesquisa divulgada no mês de abril de 2021, o desempenho do Hospital Giselda Trigueiro no tratamento em UTI de pessoas atingidas pela Covid19 mostrou-se acima da média nacional. De acordo com levantamento da Associação de Medicina Intensiva Brasileira (AMIB), o índice de óbitos nas UTIs públicas era então de 36,6% e nas privadas de 29,7%. No caso do Giselda, o número chegava a 21,5%, levando-se em conta o período entre o início da pandemia e março daquele ano.
O hospital realiza mais de seis mil atendimentos por mês, sendo ainda referência no ensino e pesquisa a partir de parcerias com o Departamento de Infectologia e o Instituto de Medicina Tropical da Universidade Federal do Rio Grande do Norte (UFRN), além de diversos cursos da área da saúde como enfermagem, nutrição, farmácia e serviço social.

da dra. Maria Giselda da Silva Trigueiro, médica infectologista falecida em 1986.
Já no ano seguinte, em 15 de março de 1987, o hospital receberia o nome de sua ex-diretora. Giselda nasceu em Vila Velha, no Ceará, e morreu em Natal, vitimada por um câncer de mama. Ela comandou o então Hospital Evandro Chagas por mais de 20 anos, estabelecendo uma série de linhas de cuidados e projetos importantes para melhorar o atendimento à sociedade.
Unidade da rede estadual é referência para tratamento de doenças infectocontagiosas no RN
Nestes 60 anos, a Fundação José Augusto foi administrada pelos presidentes e diretores gerais Diógenes da Cunha Lima, Sanderson Negreiros, Franco Maria Jasiello, Evilásio Leão de Moura, Cláudio Emerenciano, Valério Mesquita, Paulo Macedo, Woden Madruga, Iaperi Araújo, François Silvestre, Isaura Amélia Rosado, Ana Neuma de Lima, Ivanira Ribeiro, Sérgio Cunha de Aragão Mendes, Rodrigo Bico, Crispiniano Neto, Amaury Júnior e agora Gilson Matias.
A FJA apresenta nestas seis décadas uma rica história repleta de ações fundamentais para o desenvolvimento da cultura e a preservação da memória cultural do povo do Rio Grande do Norte.
AFundação José Augusto (FJA) tem a alma da cultura potiguar. Durante seis décadas, completadas no dia 8 de abril, transformou-se na principal base de apoio às atividades culturais do Rio Grande do Norte.
A FJA é responsável por desenvolver, incentivar, apoiar, difundir, estimular e documentar a história do estado.
Compete à instituição também o processo de tombamento do patrimônio histórico e arquitetônico e também do patrimônio cultural imaterial.
Criada no governo Aluísio Alves, pelo Decreto-lei nº 2.885, de 8 de abril de 1963, a Fundação José Augusto nasceu como instituição cultural e de ensino superior. Abrigou, incialmente, três cursos: Jornalismo, Filosofia e Sociologia. Com o crescimento das universidades públicas, notadamente da Federal do Rio Grande do Norte (UFRN), desvinculou-se da educação formal e concentrou suas atividades na gestão da cultura e na administração de vários equipamentos culturais. No total, são 50 equipamentos culturais e quatro grupos artísticos sob sua administração direta.
O órgão também gerencia dois programas permanentes, um de financiamento da produção cultural e um de apoio às manifestações da cultura popular. O Programa Cultural Câmara Cascudo destina, anualmente, em torno de R$ 10 milhões para a produção de espetáculos de música, teatro e dança, e para a organização de feiras de livros e de artesanato. O Registro do Patrimônio Vivo (RPV) destina bolsas vitalícias a mes-

tres e grupos artísticos ligados à cultura popular.
Foi responsável pela aplicação de editais importantes para o fomento artístico-cultural do RN como o Edital de Fomento à Cultura e Pauta Livre (2019), e os emergenciais “Tô em Casa, Tô na Rede”, “Glorinha Oliveira” e a Lei Aldir Blanc (2020), que destinou cerca de R$ 32 milhões para artistas potiguares, cuja produção foi afetada pela pandemia da Covid-19.
A FJA editou três revistas ao longo de sua trajetória: O Galo, de caráter ensaístico, dedicada à reflexão e à divulgação literária; a Preá, dedicada à cultura popular, e a Carcará, dirigida à divulgação do audiovisual potiguar.
Com a reativação da Gráfica Manibu, será retomado o histórico concurso literário Luís Carlos Guimarães destinado a obras poéticas. Nas artes cênicas, a atual gestão do órgão deverá reativar o Centro Experimental de Teatro.
Agora, novos investimentos são feitos pelo Governo do RN para o fortalecimento das atividades e valorização das raízes culturais. A recriação da Secretaria Extraordinária da Cultura, comandada por Mary Land Brito, é uma prova disso. Nesse novo momento, o governo vai incentivar uma integração maior com os municípios no sentido de valorizar as manifestações culturais de cada localidade e região.

- Pinacoteca do Estado;
- Memorial Câmara Cascudo;
- Museu Café Filho;
- Forte dos Reis Magos;
- Teatro Alberto Maranhão, em Natal;
- Teatro de Cultura Popular Chico Daniel, em Natal;
- Teatro Lauro Monte Filho, em Mossoró;

- Teatro Adjuto Dias, em Caicó;
- Instituto de Música Waldemar de Almeida;
- Escola de Dança do Teatro Alberto Maranhão;
- Biblioteca Estadual Câmara Cascudo;

- Orquestra Sinfônica do RN;

- Corais Canto do Povo, Camerata de Vozes e Coral Harmus;
- Parque Cidade da Criança;
- Gráfica Manibu;
- 27 Casas de Cultura Popular.

Criada há 60 anos, FJA é responsável por desenvolver, incentivar, difundir, estimular e documentar as atividades culturais


Entre os dias 31 de maio e 3 de junho, acontece em São Paulo a Celebra Show, maior feira nacional do segmento de festas e eventos, promovida pela ABCasa. A decoradora Isadora Sousa vai participar da programação da feira com um espaço montado para apresentar seu trabalho. A Celebra Show reúne grandes empresas e profissionais, e lançou o desafio para decoradores de todo o Brasil interessados em apresentar seu trabalho durante os dias de evento. Ao todo foram abertas apenas sete vagas, e ela, que sempre participou do evento como visitante, decidiu se inscrever por acreditar que seja uma grande oportunidade de apresentar seu trabalho não só para o Brasil, mas tendo a chance, inclusive, de ser conhecida por representantes de outros países. Durante a feira, os profissionais vão concorrer ao prêmio de melhor decoração. Os participantes do desafio serão avaliados e julgados por representantes da grande mídia nacional (maior peso na avaliação), profissionais renomados e, por fim, o voto popular entre os visitantes no evento.
Gerente Financeira e Articuladora, Júlia Costa, explica como funciona o Projeto Jovem Empreendedor
Rural da Secretaria Municipal de Agricultura e Desenvolvimento Rural (SEADRU). Página 4
mossoroense na celebra Show
Decoradora Isadora Sousa está entre grupo de profissionais do segmento de festas selecionado para montar um espaço na maior feira de eventos do Brasil, representando o Nordeste. Página 8
• Edição – C&S Assessoria de Comunicação
• Editora – Nara Andrade

• Diagramação – Rick Waekmann
• Projeto gráfico – Augusto Paiva
• Impressão – Gráfica De Fato
• Revisão – Gilcileno Amorim
• Foto – Marcos Garcia
Redação, publicidade e correspondência
Av. Rio Branco, 2203 – Mossoró (RN)
Fones: (0xx84) 3323-8900/8909
Site: www.defato.com/domingo
E-mail: redacao@defato.com

Página 3
Página 14


O objetivo principal é mostrá-los que eles são capazes de vencer independente de onde estejam’PoR nARA AnDRADE naraandrade@gmail.com
Jovens de comunidades da Zona Rural de Mossoró estão tendo a oportunidade de participar de ações que visam impulsionar o empreendedorismo, promovidas por meio de uma parceria entre a Secretaria Municipal de Agricultura e Desenvolvimento Rural (SEADRU), o Serviço Brasileiro de Apoio às Micro e Pequenas Empresas (SEBRAE) e Fundação de Apoio à Educação e ao Desenvolvimento
O que é o Jovem Empreendedor Rural?
É uma estratégia para identificar e impulsionar as características empreendedoras dos jovens da Zona Rural de Mossoró. Até pouco tempo atrás, quando falávamos de empreendedores, logo se vinha à mente a abertura ou continuidade de um negócio ou uma empresa, não que seja errado caracterizá-los dessa forma, mas empreender vai além de um CNPJ. O conceito está diretamente ligado à capacidade de colocar ideias em práticas. É prática na extensão rural, instruir os líderes familiares (homens, pais) dentro da propriedade/comunidade rural. Pensando na sucessão rural, surgiu o projeto Jovem Empreendedor Rural.
Qual o público-alvo?
Adolescentes/Jovens de 13 a 18 anos residentes nas comunidades rurais de Mossoró.
Como funciona?
O Projeto é dividido em cinco encontros, sendo o primeiro uma mobilização com pais e responsáveis objetivando o apoio na execução das atividades. Dois destes encontros são destinados à apresentação dos principais conceitos e características do empreendedo -
Tecnológico do Rio Grande do Norte (FUNCERN). O projeto “Jovem Empreendedor Rural” já está em sua segunda edição, e desta vez contempla o Assentamento Favela. A Gerente Financeira e Articuladora do Projeto Jovem Empreendedor Rural da Seadru, Júlia Costa, é a responsável pelo projeto e explica como funciona, qual o público-alvo, e os objetivos dessa ação.

rismo, entre eles: Liderança, trabalho em equipe, inovação, persistência, estabelecimento de metas, entre outros. No quarto encontro é apresentado um esboço do trabalho de conclusão do projeto, intitulado MEU PROJETO DE VIDA. Nele os jovens terão a oportunidade de colocar no papel todos os sonhos e anseios dentro de uma linha de tempo (curto/ médio e longo prazo. A apresentação deste plano ocorre no quinto encontro.
Qual o período de realização?
Os encontros acontecem geralmente aos sábados ou domingos devido ao fato dos jovens estudarem no decorrer da semana.
Quem promove?
O projeto faz parte do Programa Mossoró Rural, idealizado e realizado pela Prefeitura de Mossoró, por meio da Secretaria de Agricultura e Desenvolvimento Rural, em parceria com alguns órgãos como SEBRAE/ SENAR e FUNCERN.
Quais os objetivos?
Capacitar os jovens da zona rural de Mossoró. Pois, geralmente, o que acontece? Os jovens são incentivados a deixar a zona rural como pré-requisito para ser alguém na vida. E o objetivo principal é mostrá-los que eles são capazes de vencer independente de onde estejam e, principalmente, mudar ou
melhorar a realidade do local onde vivem. No caso, as comunidades rurais.
Quantos jovens contemplados?
Na primeira etapa foram contemplados, aproximadamente, 20 jovens do polo Maísa. Para segunda edição, a meta é capacitar 50 jovens até agosto/2023. Entre as comunidades estão P.A Favela, Cordão de Sombra 1, Novo Espinheiro, Boa Fé, entre outros.

Como esses jovens são selecionados para participar?
Por meio do banco de dados das atividades desenvolvidas pela Se -
cretaria de Agricultura. Entramos em contato com os líderes das comunidades rurais onde apresentamos o projeto e verificamos a viabilidade da execução do mesmo.
Quais as atividades promovidas dentro do projeto?

Utilizamos meios para atrair a faixa etária do público. Dinâmicas, filmes, músicas, redes sociais, jogos educativos entre outros.
Tem previsão para novas edições depois dessa segunda?
Sim, a intenção é atingirmos o maior número possível de comunidades rurais.
Como as comunidades são escolhidas?
Por meio do banco de dados das atividades desenvolvidas pela Secretaria de Agricultura. Caso alguém se interesse, é só procurar a secretaria e expressar o desejo de participar do projeto, que teremos o maior prazer de passar as informações referentes ao projeto.

>> Decoradora, Isadora Sousa, está entre grupo de profissionais do segmento de festas selecionado para montar um espaço na maior feira de eventos do Brasil, representando o Rio Grande do Norte e o Nordeste.

Entre os dias 31 de maio e 3 de junho, acontece em São Paulo a Celebra Show, feira nacional do segmento de festas e eventos considerada a maior do país. E este ano, além de visitantes do evento, terá representante de Mossoró entre os expositores. A decoradora Isadora Sousa vai participar da programação da feira com um espaço montado para apresentar seu trabalho. A profissional explica como surgiu a oportunidade de fazer parte da feira, que ela sempre visitou para conhecer as novidades do segmento.
Isadora Sousa explica que a ABCasa comprou todas as feiras de entretenimento que eram realizadas durante o ano e juntou em uma só, assim se tornou a Celebra Show, e entre os dias do evento os visitantes terão oportunidade de conhecer as últimas tendências nos segmentos de parques, festas, decorações, halloween, natal, confeitaria e etc.
Ela diz que a Celebra Show reúne, anualmente, grandes empresas e profissionais, e lançou o desafio para decoradores de todo o Brasil interessados em apresentar seu trabalho durante os dias de evento. Ao todo foram abertas apenas sete vagas, e ela, que sempre participou do evento como visitante, decidiu se inscrever, por acreditar que seja uma grande oportunidade de apresentar seu tra-


Decoradora mossoroense montará uma decoração com tema escolhido por organizadores do evento, concorrendo a prêmio.
balho não só para o Brasil, mas tendo a chance, inclusive, se ser conhecida por representantes de outros países.
“Foram selecionados sete decoradores e fui chamada para integrar esse grupo de profissionais. Durante a feira, vamos concorrer ao prêmio de melhor decoração; para a avaliação deveremos montar um espaço com uma decoração de vitrine baseada nas cores da Louis Vuitton 2023”, comenta.
Os sete profissionais participantes do desafio serão avaliados e julgados por representantes da grande mídia nacional (maior peso na avaliação), profissionais renomados e, por fim, o voto popular entre os visitantes no evento.
“É a maior feira de entretenimento da América Latina; lá estão os maiores e melhores profissionais do mercado, com tendências novas e fornecedores de diversos lugares do mundo. Então meu trabalho pode ser reconhecido nacionalmente e, quem sabe, abrir possibilidades para o mundo.”
A profissional destaca que os decoradores selecionados deverão executar o projeto de decoração dois dias antes da abertura dos portões do evento para o público. “Antes dessa abertura fazemos entrevistas para as equipes das emissoras presentes”.
Isadora Sousa enfatiza que o grupo ficará no primeiro pavilhão da feira. “Assim que todos entrarem na feira darão de cara com nosso stand, gostaria muito do apoio da minha cidade e região, para juntos trazermos essa vitória para nossa cidade; aqui do Nordeste só temos eu e um cearense. Então, quem for para feira passe por nós e deixe seu voto, vamos dar nosso melhor”.
Para conhecer mais sobre o trabalho desenvolvido no segmento de festas por Isadora Sousa, e acompanhar detalhes sobre sua participação na Celebra Show, é só acessar o perfil da profissional no Instagram (@ isadorasousadecor).




>> Inscrições para a prova, que conta com três modalidades, já estão abertas. Evento é organizado em conjunto pelas
Lojas Maçônicas Betel, 24 de Junho e João da Escóssia
Já estão abertas as inscrições para a 1 ª Corrida Rústica Maçônica Beneficente de Mossoró. A prova, que conta com três diferentes modalidades e premiação em dinheiro para os três primeiros colocados, acontece no dia 7 de maio.
Por ser um evento de cunho beneficente os participantes inscritos ainda têm a oportunidade de ajudar ao Albergue de Mossoró (Albem).
A competição é organizada pela Loja Maçônica Betel n.12, e conta com o apoio da Loja Maçônica 24 de Junho e da Loja Maçônica João da Escóssia.
Disputada em diferentes categorias, os inscritos têm a possibilidade de participar nas modalidades: distância de 2,5 km caminhada, corrida 5 km e 10 km.

A prova está prevista para largar às 6h, e os atletas participantes deverão se concentrar na Universidade Uninassau a partir das 5h. Às 5h50, será realizado um aquecimento antes do início da prova, no pátio do estacionamento da faculdade, conduzido por um profissional de Educação Física.
Para se inscrever os interessados devem acessar o site www.cronoteam.com.br. Os organizadores da competição frisam que a prova terá a duração máxima de 1h40 (1 hora e 40 minutos) e o atleta que
Por ser um evento de cunho beneficente os participantes inscritos ainda têm a oportunidade de ajudar ao Albergue de Mossoró (Albem).
não cumprir todo o trajeto dentro do tempo de corte estabelecido não terá seu tempo cronometrado.
Também fica estabelecido pela organização que atletas de ambos os sexos, regularmente inscritos de acordo com o Regulamento Oficial, poderão participar da prova que será dividida por faixas etárias e categorias. E haverá Premiação Geral, Premiação por Faixa Etária, por sexo.
Para se inscrever na 1 ª Corrida Rústica Maçônica Beneficente de Mossoró os interessados devem preencher formulário no portal Crono Team, escolhendo a categoria que vai disputar.

Os inscritos receberão o Kit da corrida, composto por produtos que identifiquem o atleta, de acordo com o tipo de inscrição que realizou. Quem optou pela inscrição sem a camisa, receberá o kit com número de peito, chip e produtos de possíveis patrocinadores. E quem efetuou a inscrição com Camisa, terá direito ao kit composto por camisa, Número de peito, chip e produtos de patrocinadores. A entrega dos kits será realizada no dia 5/5 (das 9h às 12h e das 5h às 20h), e no dia 6/5 (das 9h às 14h), e o local será informado uma semana antes da data para a retirada. O atleta que não retirar seu kit na data e horário estipulado pela organização ficará impedido de participar da prova e perderá o direito ao kit.
Os organizadores informam ainda que todos os participantes inscritos, que completarem a prova receberão uma medalha da competição. E os três primeiros colocados receberão troféu e medalha, além de premiação em dinheiro, sendo R$ 500 em premiação para masculino e R$ 500 para feminino, categoria 5 km. A categoria 10 km também conta com R$ 500 em premiação para masculino e R$ 500 para feminino. O valor será dividido entre os três
primeiros colocados, sendo R$250,00 para o 1° lugar, R$ 150,00 para o 2 º e R$ 100,00 para o 3 º , em



500 g de filé de peito de frango
4 dentes de alho
130 g de cebola
180 g de alho-poró
2 xícaras de creme de leite
Noz moscada a gosto
4 colheres de queijo parmesão
4 ovos
130 g de Cream Cracker Pilar
200 g de farinha de trigo
150 g de margarina
Sal a gosto
Pimenta do reino a gosto
100 ml de azeite
200 g de cream cheese
150 g de milho verde
massa
Processe a bolacha Cream cracker Pilar. Misture com a margarina e o trigo formando uma massa homogênea. Coloque a massa em uma forma de fundo móvel e leve em forno preaquecido a 180 graus por 10 minutos. Recheio
Tempere o peito de frango com sal, pimenta do reino, alho e reserve. Coloque na panela de pressão o azeite e a cebola. Adicione o frango temperado dando uma leve refogada. Cubra com água e deixe cozinhar. Depois que pegar pressão, conte 10 minutos e desligue. Após retirar a pressão, desfie o frango e reserve.
Em uma panela coloque azeite, alho-poró em rodelinhas, o frango desfiado, requeijão, creme de leite e o queijo parmesão ralado. Retire do fogo e acrescente os ovos e o milho verde. Tempere com sal, pimenta do reino e noz moscada a gosto.
Finalização
Cubra a massa pré-assada com o recheio de frango e leve ao forno preaquecido a 180 graus por 15 minutos. Sirva com tomatinhos cereja.



defato com

>> Bastidores Com novidades no elenco, nova temporada “Cine Holliúdy” na globo retoma a universalidade da comédia nordestina

>> inside Com cenário rural como pano de fundo, “Terra e Paixão” mergulha em dramas e brigas familiares
@defato_rn /jornaldefatorn /photos/jornaldefatorn moSSoRÓ (Rn), Domingo, 23 de abril de 2023
>> principal Em “Travessia”, Rodrigo Lombardi se sente à vontade nas novelas e valoriza sua longa trajetória no gênero pÁGina 3
Chega ao HBO Max a quarta e última temporada do sucesso "Barry". Criada por Alec Berg e Bill Hader, a produção estreou na HBO em 2018. Com uma trama simples, abordando um personagem titular controverso que se infiltra no mundo das artes para se libertar de sua rotina como um assassino de aluguel, a narrativa conquistou fãs no mundo inteiro. A nova temporada vai mostrar as consequências das ações de Cousineau (Henry Winkler) e da prisão de Barry (Bill Hader), que promete reviravoltas chocantes. As três primeiras temporadas da série receberam 44 indicações ao Emmy Awards, conquistando nove delas, incluindo Melhor Ator em Série de Comédia para Hader e Melhor Ator Coadjuvante em Série de Comédia para Winkler. O elenco ainda conta com as participações de Stephen Root como Monroe Fuches, Sarah Goldberg como Sally, Anthony Carrigan como Noho Hank e Robert Wisdom como Jim Moss.

(Star+, S eg, dia 24)
A série "Mães da Máfia" já está disponível no Star+ com todos os seis episódios da primeira temporada. No enredo, três mulheres sofrem constantemente com a violência dos homens da família – maridos e pais autoritários envolvidos com os negócios sujos da máfia. Cansadas dessa vida, elas começam a colaborar com uma promotora que está investigando o clã Ndrangheta. Com fácil acesso aos mafiosos e informações privilegiadas, Denise, Giuseppina e Maria Concetta podem ser a grande chance das autoridades de destruir a organização criminosa. As personagens, no entanto, não conseguirão fazer isso sem colocarem a própria vida em risco nessa história eletrizante adaptada do livro do jornalista britânico Alex Perry.
( g loboplay, qua, dia 26)
Uma das mais premiadas novelas da história recente da Globo, "Lado a Lado" estreia no Globoplay como parte do projeto de resgate de clássicos da teledramaturgia. Exibida originalmente em 2012, o folhetim conta a história de duas mulheres, Laura e Isabel, que apesar de originárias de mundos totalmente diferentes, caminham na mesma direção: buscam conciliar amor e liberdade na conservadora sociedade carioca do início do século XX. De origem bastante humilde, órfã de mãe, e filha única de Afonso, um ex-escravo, Isabel não pôde estudar, e trabalha desde os 14 anos como empregada doméstica na mansão de uma dama francesa, Madame Besançon. Professora, amante das artes literárias e dos livros de poema, Laura, uma jovem doce, porém afrente do seu tempo, vê o casamento como
um empecilho a seus sonhos de estudar e trabalhar fora de casa, atitudes jamais aceitas por sua mãe, a impiedosa Constância, uma ex-baronesa muito arrogante e preconceituosa, que vê na união da filha com Edgar, filho do poderoso senador Bonifácio Vieira, a possibilidade de voltar aos velhos tempos de luxo e poder, já que o seu marido, Dr. Assunção, perdeu muito dinheiro com o advento da República.
( p rime Video, S ex, dia 28)
O Prime Video estreia "Citadel", série de ação original da Amazon estrelada por Richard Madden e Priyanka Chopra. A obra é produzida pelos Irmãos Russo e Josh Appelbaum. Na trama, oito anos após a queda da agência de espionagem global Citadel, os agentes secretos Mason Kane e Nadia Sihn, vividos por Madden e Chopra, precisam se unir para impedir que a Manticore, uma organização rival, instaure uma nova ordem mundial. Mas, a situação fica ainda mais complicada quando eles descobrem que suas memórias foram apagadas por um traidor da antiga Citadel. No elenco, Stanley Tucci, Ashleigh Cummings, Caoilinn Springalle Lesley Manville, entre outros.
( d i S ney+, S ex, dia 28)
"Peter Pan & Wendy" traz a história atemporal de uma jovem que, desafiando os desejos de seus pais de frequentar um internato, viaja com seus dois irmãos mais novos para a mágica Terra do Nunca. Lá, ela conhece um garoto que se recusa a crescer, uma pequena fada e um capitão pirata malvado, e logo se encontram em uma aventura emocionante e perigosa muito, muito longe de sua família e do conforto de casa. Esperado lançamento da Disney+, o longa é inspirado no icônico livro homônimo publicado por J.M. Barrie em 1911, que posteriormente foi adaptado para animações e muito mais.
Rodrigo Lombardi é um apaixonado por novelas. E o ator faz questão de explicitar isso pelos corredores dos Estúdios Globo, no Rio de Janeiro. No ar em “Travessia”, ele retorna ao gênero no horário nobre como o dúbio Moretti. Por mais que a trajetória seja longa e exaustiva até o último capítulo do folhetim, Rodrigo vibra com cada nova oportunidade de integrar o elenco de uma novela inédita. “Não sei se aprendi (fazer), se é um gênero que casa comigo, mas sei que gosto de fazer. Então, é sempre bom estar de volta. Quando começou a ideia dessa novela, eu não estava no elenco, mas, quando a direção da emissora me ligou e falou que era uma novela da Gloria Perez, eu fiquei bem feliz”, vibra.

Na história das nove, Moretti é um empresário do ramo da Construção Civil. Ele já foi amigo e sócio de Guerra, papel de Humberto Martins, mas os dois se tornaram rivais após Moretti se envolver com a amada do parceiro. “É um personagem que não é vilão ou mocinho. A novela traz coisas para se reconhecer, refletir e melhorarmos”, aponta.
P – A trama de “Travessia” marcou seu retorno às novelas após “A Força do Querer”, que foi ao ar em 2017. Você sentia falta do gênero?
R – Eu estava com saudade de contar uma história em 200 capítulos. Porque a gente sabe que, quando faz um filme, é um
ma de que os fins justificam os meios e você vai quebrar o seu discurso e vai cair na dúvida das pessoas, porque todo mundo é assim. Todos nós já fomos mal interpretados por alguém ou já erramos com alguém ou machucamos alguém. Já fomos machucados por tanta gente.
P – A novela levanta muitos debates sobre tecnologias e o universo das redes sociais. Você se considera uma pessoa tecnológica?
mês de filmagem, que quando faz uma série, são 12 semanas, e quando a gente faz uma novela, é um ano. Então, a gente forma essa família. E de repente, em uma sexta, quando acaba o último capítulo, a gente não sabe o que fazer no sábado. Chega em casa, acorda, abre a geladeira e fala assim: “nossa, mas já sei tudo o que tem aqui dentro, é a quinta vez que abro essa geladeira em dez minutos” (risos). Eu não sei o que fazer da minha vida até fazer outro trabalho.
P – Como surgiu a oportunidade para “Travessia”?
R – Mais uma vez esse personagem não era para mim (risos). O personagem era do Alexandre Borges. Acho que 90% dos papéis que eu fiz não eram para mim. Esse é mais um. “Carcereiros” não era eu. “Meu Pedacinho de Chão” não era eu... acho que vou chorar (risos). Mas sempre entrego um trabalho honesto. É sempre um prazer estar em uma novela da Gloria. Eu tenho uma sintonia muito boa com ela.
P – Como assim?
R – Eu entendo como ela escreve e como ela funciona. Em contrapartida, ela também é capaz de entender como um ator funciona fazendo uma cena dela. Então, ela começa a escrever os próximos capítulos já com isso na cabeça. Fazer quatro novelas dela me dá uma certeza na primeira leitura do capítulo que eu já sei a música que ela escreve, a velocidade dela, o que posso emprestar do meu melhor para que aquilo tenha peso ainda maior.
P – O Moretti é um personagem dúbio. Essa complexidade dos papéis é algo que tem atraído você?
R – Eu gosto muito que essa novela porque é um retrato fiel da vida real. Ela foge o tempo todo do herói e do vilão. Todo mundo é tudo. O Moretti começa a novela com traços de vilania, mas ele não é vilão. Têm momentos em que você vai precisar quebrar as suas regras. Vai precisar ir contra sua ética, sua moral, seus valores, seus costumes. Você vai usar aquela máxi-
R – Sou completamente analógico. As pessoas sabem fazer desenho ou editar em aplicativo e eu sei fazer origami (risos). Até hoje se eu quiser mandar um email com anexo, peço para meu filho. Eu gosto de ser assim. Hoje, graças a Deus, eu tenho condição de poder continuar assim, são certas qualidades do meu trabalho, mas se eu precisar ser assim tecnológico, posso chamar alguém para fazer para mim. Meu trabalho é mexer com a alma, com o ser humano. Fiquei mais ativo na internet durante a pandemia.
P – Por quê?
R – Foi mais por conta do meu irmão. Ele tem uma agência de influencers e ele passou dez dias na minha casa. Então, falou que eu tinha de que fazer isso e aquilo. Fiz e adorei. Fiz lives, fiz entrevistas, eu chamei pessoas, achei que ninguém ia querer falar comigo e pessoas incríveis estavam falando comigo, foi um processo de autoconhecimento muito grande.
P – Foi diferente voltar aos estúdios após um período de isolamento?
R – A gente passou um tempo bem esquisito, né? Inclusive, acho muito interessante fazer essa novela nesse momento. A gente ficou enclausurado na nossa caverna e, quando saímos, estávamos com internet 5G.
>> principal Em “Travessia”, Rodrigo Lombardi se sente à vontade nas novelas e valoriza sua longa trajetória no gênero
dinheiro. Hoje, porém, a situação é outra e Chiara decidiu trabalhar ali. “Ela quer ajudar. Está acostumada a vida inteira a todo mundo fazer tudo por ela. Mas agora quer colocar a mão na massa e isso é muito legal”, conta Jade, entusiasmada.
Uma estreia em novela, sendo ou não no horário mais nobre de uma emissora, é sempre um momento de tensão e, ao mesmo tempo, de emoções muito intensas para qualquer profissional das artes cênicas. Principalmente quando se trata de um dos personagens centrais. Jade Picon viveu isso em “Travessia”, folhetim das 21h da Globo, quando pouco depois de ter ganhado ainda mais fama com sua participação impactante no “Big Brother Brasil 22”, foi chamada para dar vida à então mimada Chiara. Hoje, porém, a história é outra. A garota foi enganada pelo amado Ari, papel de Chay Suede, e se transformou. “Estou amando tudo o que está acontecendo. Confesso que a reação da Chiara me surpreendeu. Amei, fiquei fascinada”, valoriza.
O ponto de partida para a mudança no comportamento de Chiara foi o golpe que sua família sofreu de Ari. Depois de formalizar uma união estável com a garota, ele se apresentou como sócio da empresa de Guerra, pai da moça, uma movimentação feita sem que ninguém soubesse. Ao se tocar que poderia estar dormindo com um inimigo, a menina tenta dar a volta por cima para ajudar o pai. “São nesses momentos difíceis e de extrema mudança que você tem de resgatar, de uma hora para a outra, forças de um lugar que
nem sabe que tinha. Ou você é derrubado e se entrega a esse sentimento de perda e de desamparo”, avalia Jade.
Essa trajetória inusitada de Chiara fez dessa estreia de Jade na teledramaturgia um momento ainda mais instigante. Afinal, proporcionou à atriz paulistana, que tem apenas 21 anos, um processo de reconstrução de personagem. “Achei lindo como tudo aconteceu. Inicialmente, ela fica desampa-

rada, sem entender. Mas, a partir do momento em que compreende o que está acontecendo, não se entrega, não desiste e fica ainda mais forte”, analisa a ex-“BBB”.
Essa nova fase de Chiara marca uma reviravolta na relação da garota com os negócios do pai. No início, a personagem só aparecia na construtora do pai para passear, conversar, ver o namorado ou, como toda boa herdeira, pedir
Jade sabe bem o que fez com que Chiara passasse por um amadurecimento tão intenso e em tão pouco tempo: a desilusão amorosa. “Foi o golpe de Ari que desencadeou essa vontade de aprender, de querer assumir os negócios no futuro. Ela não quer deixar ninguém sentar na cadeira que, por direito, é dela”, atesta. Para que a mudança parecesse mais crível, muitos aspectos da personagem foram explorados. “Tenho trabalhado, tanto nas cenas quanto na caracterização e no figurino, para ela não perder a essência. Ninguém muda da noite para o dia e vira completamente outra pessoa”, explica.
Uma das maiores surpresas das transformações ocorridas em Chiara foi a aproximação dela com Brisa, a mocinha interpretada por Lucy Alves. Uma união inesperada que, na visão de Jade, levanta a pauta da sororidade. “Acaba acontecendo uma conexão entre as duas que eu acho muito bacana. Duas mulheres completamente diferentes, que tinham seus embates, seus problemas, mas estão se ajudando”, enaltece. Enquanto Brisa anda desesperada com a possibilidade de perder de vez o filho, Tonho, interpretado por Vicente Alvite, Chiara precisa superar o fracasso de sua relação com Ari. “As duas sofreram na mão do mesmo homem. Esse sofrimento, querendo ou não, conecta”, pontua.
Jade Picon foi de menina rica e mimada a mulher traída e desamparada tentando se reerguer na pele de Chiara



Operíodo da pandemia forçou o late show “Conversa com Bial” a uma adaptação inevitável: a de encaixar o programa em um formato remoto. Superados os entraves tecnológicos, a equipe percebeu que poderia expandir as possibilidades do programa a partir do novo modo de operar, com convidados que dificilmente poderiam aparecer no estúdio, em especial, os internacionais. Muitas doses de vacina depois, a produção volta ao ar aproveitando-se de todas as experiências adquiridas ao longo desses seis anos de existência. Desta forma, a dinâmica das entrevistas funciona muito bem em gravações feitas nos Estúdios Globo, em ambientes externos nos quais o apresentador vai até o convidado e também em conversas remotas. A espera-

da volta ao estúdio, entretanto, é também um retorno ao esquema de entrevista que público e convidados mais saudosistas estavam acostumados.

Existe uma grande diferença entre programas de entrevistas e talk shows. No primeiro, a estrela é basicamente o entrevistado e o foco da produção é no conteúdo da conversa. No segundo, a conversa com o convidado ainda se mostra importante, mas é o entretenimento que comanda a ação. É neste último que reside o “Conversa com Bial”. É claro que os formatos podem se misturar e ganhar outros contornos de acordo com a proposta de cada projeto. Na esteira do fim do “De Frente com Gabi”, em 2015, e do “Programa do Jô”, em 2016, houve um boom de produções do gênero. De Luciana Jime-
nez a Fábio Porchat, passando por Danilo Gentili, Marcelo Adnet e Tatá Werneck, emissoras escalaram figuras de diferentes áreas para conversas de formatos, linguagens e resultados oscilantes. Hoje, o cenário é bem diferente e a verdade é que o telespectador que gostava de assistir a boas entrevistas antes de dormir está carente de opções. Sendo assim, é revigorante que o estilo tradicional e sem amarras do “Conversa Com Bial” volte ao ar em todas as suas possibilidades.
Bial mostra uma vaidade intelectual que não se justifica pelo seu currículo – repleto de apresentações de “BBB” –, mas sabe muito bem conduzir seus convidados. Mas segue pecando na reverência aos feitos dos entrevistados – alguns textos introdutórios, in-
clusive, parecem feitos por uma assessoria –, na excessiva demonstração de ficar emocionado e se levando a sério demais em um horário onde o público quer se desligar do mundo e apenas se deixar entreter. Em contrapartida, o jornalista dispõe de um espaço com prestígio para atrair nomes do primeiro time de qualquer tema. Em algumas noites, galãs e heroínas da Globo podem falar sobre fofocas e sair do rasteiro esquema para publicizar as produções da própria emissora. Em outras, políticos e membros do judiciário conseguem burlar o protocolo em papos que vão além da corrupção ou autopromoção. Quando quer e o convidado ajuda, Bial tem munição suficiente para se destacar e mostrar a real relevância de suas conversas.

De volta ao conforto do estúdio, “Conversa com Bial” acerta ao apostar na liberdade e manter esquema experimental de entrevistas
Até o fechamento da edição, a emissora não divulgou o resumo do capítulo.
Até o fechamento da edição, a emissora não divulgou o resumo do capítulo.
Até o fechamento da edição, a emissora não divulgou o resumo do capítulo.
Segunda – Érico se afasta antes de ser visto por gilda e gaspar. Turíbio persegue Elza e odilon. gaspar cobra sua recompensa de gilda. ione espalha a fofoca sobre Elza e odilon pela cidade. Érico finge surpresa ao ver gaspar chegando ao grande Hotel. marê, marcelino, orlando, manoel e os padres se divertem durante o piquenique. Verônica conta para Júlio que ajudou Elza e odilon a fugir. gilda fica tensa quando percebe que Érico a viu com gaspar.
Segunda – Tatá tenta convencer Jenifer a não denunciá-lo. Yuri e Bela decidem procurar as pessoas que ficaram na lista de espera para receber uma bolsa de estudo. Wilma questiona Lui sobre seu relacionamento com Sol. Wilma implica com Dora, que tenta manter a calma. Simas avisa a Ben que não testemunhará na audiência de paternidade. Lui decide entrar na igreja para assistir à apresentação de Duda e constrange Sol. Kate e Rafa interagem na frente da câmera fotográfica.
Segunda – Helô e Stenio não encontram Creusa. Yone avisa a Helô que terá que liberar Ari por causa do habeas corpus. guida implora a Brisa para não processar Rudá. Leonor diz a Cotinha que descobriu que guerra não viajou no ano em que Chiara nasceu. Pilar e seus comparsas estão com Creusa como refém. Karina se desespera ao saber que Joel confrontará Bruna. Helô deduz que os bandidos raptaram Creusa. Dante oferece apoio a Ari, com a condição de que não minta. A atriz Bruna diz a Joel que não conhece nenhuma Karina.
Segunda – Zezinho explica para Pedro e Chloe que cometeu muitos erros no passado e que se ele for pai biológico deles, ele vai recompensar todo tempo perdido. A população do Jardim Bem-Te-Vi faz manifestação contra o Cobra na comunidade. Renato fica a sós com Edite e canta música romântica para a professora; Bento e Kessya aparecem no local e ficam incomodados com a atitude, já que Renato namora a Ruth. glória se encontra com Celeste na padaria; a garota tenta jogar seu encanto em cima de glória. Celeste chama glória de vó e diz que tem vergonha da Tânia.

Terça – marê e Érico confrontam gilda. gilda inventa uma história para justificar a feitura do testamento de Leonel. marê conversa com Érico e Júlio sobre a veracidade do testamento. marê descobre que o cofre da mansão está vazio. orlando discute com gilda. Justino se preocupa com o sumiço de mindim. marê descobre que gaspar enganou neiva para invadir a mansão com gilda. As crianças encontram mindim machucado e o levam até orlando.
Quarta – gilda e gaspar confabulam contra Érico. Justino se alegra com a volta de mindim. gilda e gaspar ameaçam Érico, que passa mal é levado para o hospital. marê acompanha Érico na ambulância, e se surpreende quando o advogado fala o nome de gilda. Anselmo não gosta ver a preocupação de Verônica com Érico. Justino é hostil com Sônia. marê questiona gilda sobre o mal-estar de Érico. Verônica percebe o incômodo de orlando ao ver marê e Júlio conversando.
Terça – Ben tira satisfações com Theo. Sol incentiva Lui a abraçar Fábio. Bruna conta para Ben que Sol decidiu se afastar quando percebeu que Theo também poderia ser o pai de Jenifer. Lumiar cuida dos ferimentos de Theo. Rafa convida Kate para ir a sua casa, e Jenifer a repreende. Clara desconfia quando Theo avisa que está na casa de Lumiar cuidando de um ferimento causado por Ben. Wilma bebe um chá alucinógeno no refúgio e vê Lui e Sol se beijando.
Terça – Creusa aparece no vídeo identificada como o mapa das joias. Dante conta a Ari que descobriu quem é Zezinho. guerra manda Dina devolver a núbia o documento que certifica a devolução da venda da mãe de Ari. Ari diz a Cidália que eles não resgataram todas as folhas assinadas por guerra. Leonor estranha a rapidez com que Chiara assina o contrato do apartamento. guida aceita comprar dólares em seu nome para moretti, em troca de dinheiro. Pilar aparece no vídeo para Helô e Stenio, ameaçando matar Creusa.
Terça – Jefferson e otto contam a Pinóquio que Luca vai ajudar a encontrar Tânia. Tânia manda Celeste continuar a se aproximar de glória. Branca aconselha glória a não cometer com Celeste a mesma inocência que tinha com Roger. Tânia fala a Celeste que vai retomar o controle da comunidade colocando fogo no CLL. Pedro e Chloe realizam o exame de DnA. Bento revela a João a aproximação de Renato com Edite. Renato chega na casa de Ruth, João fica furioso e pede para ele se explicar. Lorena vai sem maquiagem para a escola e tenta elevar sua autoestima.
Quarta – Kate pergunta sobre o pai de Rafa. Theo faz uma oferta para o apartamento de Lumiar. Wilma não deixa Lui e Fábio conversarem. Hugo se oferece para dar aulas de desenho igreja. Ben avisa a Lumiar que fará o exame DnA com Jenifer. Tatá vê o vídeo com os candidatos que perderam a vaga para bolsa de estudos no iCAES. Bruna conversa com Antônio, o funcionário do laboratório que será indicado por Ben. Tatá se entrega para o reitor da faculdade.
Quarta – Brisa perdoa Rudá, mas diz que não poderá retirar a queixa contra o menino. Tininha conta a Brisa que Creusa foi sequestrada. núbia conta Adalgisa que recuperou a venda. Helô avisa que policiais localizaram o paradeiro de Creusa. Pilar as coordenadas a Helô para a delegada salvar Creusa. Leonor comenta com Cotinha que tem algo estranho acontecendo com Chiara e Júlia. isa avisa família que um menino da escola disse que viu uma foto íntima de Karina. os policiais conseguem resgatar Creusa e prender Pilar e seus comparsas.
Quarta – Ruth decide terminar com Renato após o fim do namoro, Renato entrega as rosas chocolates às mulheres da escola. gael evita falar para não mostrar sua voz falha. os amigos colegial vão até a casa do Luigi se divertir. Éric começa a atrapalhar as cantadas de João em Poliana. Luísa assina contrato com Joana para desenvolvimento artístico em jogo de vídeo game. Jefferson e otto acham que Luca desistiu do plano de obter a confissão de Celeste. Em ligação, Luca responde Jeff que precisa ir com calma, que Celeste anda desconfiada.
não Até o fechamento da edição, a emissora não divulgou o resumo do capítulo.
Até o fechamento da edição, a emissora não divulgou o resumo do capítulo.
contra mindim. mal e Érico advode Justisobre incômoconversando.
Quinta – gilda exige que Érico confirme a avaliação do perito. orlando tenta consolar marê. o médico afirma para Frei João que provará a inocência de seu pai. Érico não conta para marê sobre a ameaça de gilda. Sônia se martiriza com os comentários hostis de Justino. marê demite gaspar, que finge indignação. marê e Júlio levam o falso perito, Jackson, ao encontro de Érico. Albuquerque tenta convencer Turíbio a desistir de denunciar Elza. Ademar vai atrás de Sônia no cemitério.
Sexta – marê não se conforma com a legitimação do testamento de seu pai. Sônia discute com Ademar. marcelino tenta escrever uma poesia para Aninha. Júlio apoia marê, e orlando tenta disfarçar o ciúme. gaspar ameaça gilda. Érico chora ao conversar com Verônica. marcelino sonha com Aninha. Júlio fala com mirtes no cartório de Belo Horizonte, e alerta marê, que se desespera. os padres decidem acolher marê na irmandade, e marcelino fica radiante.
Sábado – gilda e gaspar recebem os cumprimentos dos presentes na cerimônia. marê e marcelino brincam juntos. orlando é vítima de racismo no hospital. gilda não aceita a demissão de Érico. Érico termina seu romance com Romeu. ivan se insinua para Tânia, que o repele. no seminário, um padre flagra Luís com um livro proibido e o leva até o reitor. marcelino faz um pedido inusitado para marê. marê e orlando compartilham dos sentimentos por marcelino.
Rafa. Luconversarem. na de candiestudos funBen.
não conconta a os dá Creuesavisa à uma resga-
Renato e rosas e falar do Éric Podegame. plaligação, calma, já
Quinta – Ben tenta tranquilizar Sol. Theo é hostil com Helena. Rafa elogia Clara. Sol se aconselha com o pastor miguel. Antônio pede dinheiro para fazer o serviço. Theo leva Clara para trabalhar no galpão. Lumiar avisa a Theo que ele não poderá ir à clínica no mesmo horário que Ben, Jenifer e Sol. Fred conta para Jenifer que Tatá está trabalhando no Bar do Simas. Ben e Jenifer recolhem o material para o exame de DnA. Jenifer pensa estar grávida de Tatá e confidencia a Kate.
Quinta – Chiara fica assustada quando Lídia comenta que a jovem engordou. Ari mostra a foto do suposto maurício a Helô, que identifica moretti. Zezinho identifica moretti na foto que Helô lhe mostra. Karina deixa a escola quando um colega mostra uma foto sua retirada de um site adulto. Brisa é roubada quando deixa Tonho no curso, e recebe ajuda de um homem. Ari e núbia entram para ver Tonho, deixando Brisa do lado de fora. Bia vê Brisa em uma praça e chama oto para testar a reação do namorado.

Quinta – Dentro do CLL com diversos voluntários, Vini fala com Jeff pelo telefone e descobre que a gleyce não convocou nenhuma reunião e que tudo fez parte do plano do Cobra. Em diálogo com Éric, João fala em alto tom que vai ganhar a aposta e namorar Poliana; Helena escuta tudo e fica inconformada. os capangas do Cobra disparam diversos coquetéis molotov contra o CLL e um incêndio se inicia. na frente da instituição beneficente, um homem grita para toda comunidade que gleyce desvia dinheiro de doações. Jeff entra no CLL para ajudar a socorrer as pessoas.
Sexta – Antônio colhe o material de Theo. Jenifer e Kate esperam o resultado do teste de gravidez. Lumiar questiona Ben sobre o telefonema para Antônio. Jenifer e Tatá terminam o namoro. Sol chega à mansão transtornada, e Lui tenta acalmar a parceira. Ben revela a Lumiar que Theo abusou de Sol. Lui se oferece para ir com Sol até a clínica. Rafa sofre uma crise de ansiedade na faculdade, e Kate se preocupa. Lui e Sol chegam para a gravação do clipe.

Sexta – Bia percebe que oto escolheu ficar com Brisa. Joel e marineide se desesperam à procura de Karina. Dante consola Bia. Karina pede ajuda a isa. Joel solicita a Helô que encontre Karina. Helô descobre que Karina sofreu estupro virtual e aconselha Joel e marineide a acolherem a filha. Cidália pergunta a Chiara quem era a mulher que esteve conversando com Júlia no apartamento que a filha de guerra alugou. guida conta a Cidália sobre as barrigas de grávida que viu no quarto de Chiara. moretti é abordado por policiais no aeroporto.

Sexta – Pinóquio fica feliz com a notícia do namoro de João e Poliana, mas acha que vai ficar de lado. Luísa desabafa com Antônio sobre sentimento com otto e relata que marcelo ainda está vivo no coração dela; Antônio acha que ela deve viver como marcelo gostaria: livre e feliz. Pedro recebe uma carta do laboratório com resultado do exame, mas esconde para ninguém ler. Um capanga da Tânia tenta convencer a população que o Cobra vai fazer muito mais para a comunidade do que a gleyce. o CLL fica totalmente destruído.
Sábado – Luiz quer que Antônio desista da fraude. Theo ajuda Lumiar a apagar as lembranças de Ben em seu apartamento. Bruna tenta convencer Antônio a manter o acordo e alterar o exame. Lumiar deixa de usar sua aliança de casamento, e Ben nota. Theo humilha Clara após falar com orfeu. guiga convida Yuri, Bela, Jenifer e outra pessoas do iCAES para uma festa em sua casa. Helena convida Clara para sair. Kate vai à casa de Rafa.
Sábado – Laís avisa a Stenio que moretti foi preso. guerra termina com guida ao saber que a noiva emprestou dólares para moretti. Stenio diz a moretti que não pode fazer nada por ele. guida coloca um rato na cela de moretti. monteiro pede aos alunos para terem empatia com Karina. Ari diz a núbia que precisa de uma arma para se defender. Ari afirma a gil que precisa encontrar algo que desabone a conduta de guerra. Brisa se depara com Bia na casa de Dante.
Domingo, 23 de abril de 2023
Simas de “Vai na Fé”
Marcos Veras tem uma energia que parece não ter fim. Isso fica evidenciado na sua capacidade em fazer graça com quase qualquer situação que se apresente ou pela velocidade de sua fala. Mas, principalmente, por sua disposição em emendar um trabalho no outro. Pelo menos nos últimos anos, Veras tem se envolvido com projetos seguidos, sem dar grandes intervalos entre eles. Essa urgência foi muito representativa durante o auge da pandemia, quando mesmo com os estúdios paralisados, o ator se manteve no ar em produções como o remake da “Escolinha do Professor Raimundo” e a minissérie “Filhas de Eva”. Com a normalização dos trabalhos na Globo, o ator já participou da novela “Além da Ilusão”, no ano passado, e agora dá expediente como o eternamente jovem Simas de “Vai na Fé”. “Só pelo título já me deu vontade de fazer essa novela. Gosto de como a Rosane (Svartman, autora) fala de cotidiano de modo leve e, ainda assim, com profundidade. A mensagem da trama é capaz de conquistar até os mais incrédulos. Acho que é aí que reside o sucesso deste trabalho”, avalia.
Carioca e vascaíno, Veras era radialista quando começou a se interessar pela televisão. Suas primeiras experiências foram como figuração em pro-
duções como “Sítio do Picapau Amarelo”, da Globo, e “Bicho do Mato”, da Record. Foi pelo humor, entretanto, que ele começou a se destacar a partir de suas participações no antigo “Zorra Total”, onde ficou de 2009 a 2013. “Foi quando senti o poder da televisão. De repente, passei a ser reconhecido e parado nas ruas”, relembra. Nos anos seguintes, integrou o elenco do “Encontro com Fátima Bernardes” e, a convite de Gilberto Braga, acabou com um papel de destaque em “Babilônia”, de 2015, onde viveu o divertido Norberto. “Até este trabalho, meus papéis em novelas eram bem pequenos. Foi uma experiência muito interessante e me deu vontade de fazer mais. Gosto do processo de es-
tudar a trama, entender personagens e me preparar para cada nova cena”, valoriza.
P - Simas parece sofrer de Síndrome de Peter Pan e se recusa a amadurecer e se assumir como alguém que já passou dos 40 anos. É um personagem fácil de encontrar no cotidiano?
R - Muito. Estou com 42 anos e tenho diversos amigos da minha geração que insistem na juventude. Alguns de forma esporádica e outros de forma mais ampla. O que não falta é inspiração para o Simas, que mostra essa atitude por um lado mais voltado para o humor. O tempo vai passando e ele vai criando subterfúgios e motivos para não se comprometer tanto com a vida adulta.
P - Quais?
R - Ele vive no meio de outros jovens. Pegou o dinheiro que herdou e juntou para abrir um bar ao lado de uma faculdade. Namora uma garota de 20 anos que estuda nesta instituição. Ele até tem doses de saudosismo da época em que era mais novo, mas consegue se conectar bem com a garotada, vai se atualizando com o objetivo de ainda soar como um adolescente.

P - Os cabelos mais longos fazem parte deste processo?
R - Com certeza. Dão um ar mais aventureiro e acho que combinou muito com o Simas. Ele tentou ser artista, DJ e marqueteiro. Hoje é dono de bar e está aparentemente feliz com isso. Os cabelos completam esse ar meio rebelde dele. Nunca tive o cabelo tão grande.
P - Como está sendo a experiência?
R - Demorei a me acostumar. Achei estranho e me senti feio no início. Depois, comecei a me sentir mais forte e cool. No fim, é sempre bom mudar de visual para um novo personagem, ainda mais que meu último trabalho foi “Além da Ilusão”, uma novela de época. Então, foi uma proposta da direção e da Lu Moraes, caracterizadora da novela. Acho que o resultado foi bem feliz.
P - Como você lida com o passar do tempo?
R - Acho que eu lido muito bem. Gosto muito da idade que eu tenho. Eu estou com 42 anos e não troco pelos meus 20 anos. Curti muito todas as fases da minha vida. Então, ao contrário do personagem, não tenho essa nostalgia. Olho para trás com muito carinho e vejo o futuro com muita esperança. Porém, dedico meu amor ao presente. A vida é agora.
marcos Veras se diverte com o desejo de juventude eterna do quarentão
Para muitos atores, interpretar personagens reais é um dos maiores desafios que as artes cênicas podem propor. Herton Gustavo Gratto viveu isso recentemente, um trabalho que agora pode ser visto na segunda temporada de “O Rei da TV”, série disponível no Star+ sobre a trajetória de Silvio Santos. Na produção, o ator encarna um dos nomes mais emblemáticos da televisão: Fausto Silva, o Faustão, que virou a grande aposta da Globo, por 32 anos, para disputar público com o próprio Silvio. “O recorte que aborda o Faustão é o momento em que ele entra na Globo e trava uma disputa acirrada com o SBT pela liderança na audiência dos domingos. O resultado é uma programação, de ambos os lados, digamos que bem polêmica”, avalia Herton, que também é roteirista do sitcom “A Sogra que Te Pariu”, da Netflix, que estreou segunda temporada recentemente.
Para o trabalho, Herton foi chamado, inicialmente, para um teste. A seleção, porém, se desdobrou em outras avaliações. “O briefing que recebi é que não queriam uma imitação, mas sim a energia do Faustão. Embarquei nessa provocação e conquistei o papel”, conta. E
foi justamente a chance de se ver na pele de Faustão o que mais o motivou a querer o posto. “A possibilidade de dar vida a um ícone da comunicação, que faz parte do imaginário de milhões de brasileiros, foi muito desafiador. E eu sou movido por desafios”, atesta.
Depois que foi confirmado na série, Herton tratou de fazer uma imensa busca por informações sobre Faustão na internet. “Entrevistas, programas na íntegra, desde os tempos do ‘Perdidos na Noite’ (que chegou a ser exibido na TV Gazeta, na Record e na Band, em fases distintas) até o ‘Domingão’. O maior desafio foi imprimir toda a dimensão que, na minha opinião, Faustão ocupa”, explica o ator. Dentre os materiais guardados nessa pesquisa, um detalhe chamou bastante a atenção de Herton. “Achei surpreendente a ansiedade em estre-

ar na Globo. Como a série mistura fatos reais com ficcionais, não sei até que ponto, de fato, ele ficou inseguro. Mas gosto de acreditar nessa humanidade e imaginar que Faustão, com toda a sua imponência e autoestima, também teve seus momentos de vulnerabilidade diante do novo”, supõe.
Herton nunca se achou parecido com Faustão, nem mesmo na infância. Mas, por ser gordinho, sofria bullying e um dos apelidos que recebia era justamente o do apresentador. Quando foi chamado para o teste, ironicamente, passava por um processo de reeducação alimentar que culminou em perda de peso e medidas. Mas, diante da oportunidade, tomou uma decisão radical. “Por conta própria, para me aproximar fisicamente da imagem do Faustão, decidi engordar”, entrega ele, que ganhou 20 quilos.
Nome completo: Herton Gustavo Gratto.
Nascimento: 18 de agosto de 1988, em Poxoréu, no Mato Grosso.
Atuação inesquecível: “Minha primeira participação em uma novela, como o policial Leopoldo de ‘Haja Coração’. Afinal, a primeira vez a gente não esquece”.
Momento marcante na carreira: “Contracenar com Natália do Vale em ‘Orgulho e Paixão’, quando vivi a personagem Tião”.
O que sobra na televisão: “Falta de representatividade”. Com quem gostaria de contracenar: Murilo Benício.
Se não fosse ator, seria: “Autor. Sou os dois”.
Ator: Murilo Benício.
Atriz: Marjorie Estiano.
Novela: “A Vida da Gente”, escrita por Lícia Manzo e exibida originalmente pela Globo entre 2011 e 2012.
Vilão marcante: Juca Cipó, papel de Murilo Benício no remake de “Irmãos Coragem”, original de Janete Clair reescrito por Dias Gomes e exibido pela Globo em 1995.
Personagem mais difícil de compor: “Os personagens reais”.
Que papel gostaria de representar: “Um vilão engraçado”.
Filme: “Forrest Gump – O Contador de Histórias”, dirigido por Robert Zemeckis e lançado em 1994 no Brasil.
Autor: “De teatro, Nicky Silver; de literatura, João Anzanello Carrascoza; de novela, João Emanuel Carneiro; e de cinema, Aly Muritiba”.
Diretor: Aly Muritiba e Karim Aïnouz.
Mania: “Evitar usar o número 4 sempre que posso. Não comproquatromaçãs, compro três ou cinco. Não compro 400 gramas de queijo, são 300 ou 500”.
Medo: “De morrer sem realizar os meus sonhos”.
gustavo gratto dá vida a Faustão, o apresentador que tomou a liderança na audiência
Explorar novos universos e temáticas é uma das características marcantes dos trabalhos de Walcyr Carrasco. O consagrado autor já mergulhou em assuntos como Book Rosa, autismo, violência contra a mulher e racismo. De volta ao horário das nove, ele vai explorar a força feminina em meio a um Brasil rural e modernizado na trama de “Terra e Paixão”, que tem estreia marcada para o próximo dia 8. A força do amor, esperança e ambição irão nortear boa parte do enredo inédito, que contou com gravações em grandiosas plantações do Mato Grosso do Sul. “A história apresenta um grande drama amoroso e uma luta por herança, dentro de um ambiente agrícola, rural, uma parte do país ainda desconhecida por muitos, de uma maneira que não estamos acostumados a ver em novelas. Estou fascinado pela tecnologia implantada na agricultura nos dias atuais, me apaixonei por esse ambiente e quis trazer para as telas”, aponta Walcyr.
Guiada por sua força e coragem, Aline, papel de Barbara Reis, começa uma trajetória para defender seu legado e construir um futuro melhor para ela e sua família. Após o assassinato do marido em uma tentativa de invasão das terras onde vivem, a professora se torna produtora agrícola sem nunca ter plantado uma semente, enfrentando
tudo e todos para realizar seu novo sonho. “Aline é uma mulher simples, mas nobre em seus ideais. Ela é a força através da ação, uma seta que só vai para frente, não retrocede e não desiste. Vive uma constante sede de justiça e quer transformar o sonho do marido em legado para o seu filho”, explica a atriz, que estreia na posição de protagonista do horário nobre.
Ao longo de sua saga de superação, ela se conecta com Caio e Daniel, interpretados por Cauã Reymond e Johnny Massaro. Os dois irmãos se amam, mas estão no centro de uma disputa por herança e sucessão na abastada família do produtor rural Antônio, de Tony Ramos, que tem Irene, sua segunda esposa vivida por Gloria Pires, como principal incentivadora. Separadamente, têm um contato com Aline, se encantam a força da moça
e se apaixonam perdidamente por ela. Falam entre si sobre ela, sem saberem que se trata da mesma pessoa. “O Caio decide enfrentar o pai, ele gostaria muito de ser amado e admirado por ser realmente um grande trabalhador, a pessoa que toma conta da fazenda e dos negócios da família. Ele vê a madrasta como uma grande manipuladora, uma pessoa que se casou com o pai por interesses financeiros, e ele ama muito o irmão Daniel, mas fica triste de vê-lo sendo manipulado e não conseguindo enxergar a mãe que tem”, defende Cauã.
Maior produtor rural da região de Nova Primavera, cidade fictícia onde a trama é ambientada, Antônio La Selva é dono de terras a perder de vista. Homem autoritário e crítico, ele tem uma relação conturbada com o filho Caio. Ao lado de Irene, o fazendeiro
ainda é pai de Daniel e Petra, de Debora Ozório. Manipuladora e misteriosa, Irene tenta mover suas peças para fazer a cabeça do marido a escolher um dos seus filhos para assumir os negócios da fazenda no futuro, embora seja o enteado Caio quem detém os maiores conhecimentos sobre agronegócio e que acompanha toda a produção diariamente. “O Antônio aumentou a fortuna da família, que começou na geração do avô. É um homem de ambições desmedidas, mas que se preocupa com a família. Ele prega sempre a união de uma forma muito, muito controversa. É um personagem fascinante, difícil, mas, principalmente, palpável. O que mais me estimula na criação de um personagem é o quanto ele é controverso, por melhor ou pior que ele possa ser no seu caráter. É isso que me inspira”, aponta o veterano ator.

Com cenário rural como pano de fundo, “Terra e Paixão” mergulha em dramas e brigas
Adiretoria da Globo tem dividido suas atenções entre a tevê aberta e o streaming há algum tempo. A linha de shows da emissora, inclusive, tem virado um espaço para receber as produções já disponíveis para os assinantes do Globoplay há meses. A série de humor “Cine Holliúdy”, no entanto, vem na contramão dessa lógica. Prestes a estrear sua terceira temporada na tevê aberta, a produção escrita por Marcio Wilson chega totalmente inédita na grade do canal a partir da próxima quinta, dia 27. “É um projeto muito especial. Nosso maior compromisso é fazer o espectador rir de si mesmo. Se determinados comportamentos políticos ou sociais são dignos de riso, então serão contemplados em nossa eterna sátira ao brasileiro”, explica o escritor.
A fictícia cidade de Pitombas volta a ser palco da bemhumorada briga do cinema contra a tevê nos anos 1970 e 1980. O protagonista Francisgleydisson, papel de Edmilson Filho, continua sendo um cabra apaixonado pela sétima arte, que tenta de tudo para manter vivo seu estabelecimento, enquanto os morado -
res seguem encantados nas modernidades da televisão. “Esse nosso humor (nordestino), que o Brasil precisa tanto, é um humor que chega em todas as idades, sabe? As crianças são muito fãs, os adultos também”, valoriza o protagonista. A grande novidade da temporada é chegada de um investidor misterioso na vida de Francis. Interpretado por Alexandre Borges, o figurão de terno vermelho propõe dinheiro e prosperidade em troca da alma do sujeito. Com dívida até o pescoço, o cinemista começa a ser ameaçado por credores sanguinários e percebe que a única saída para não vender seu maior tesouro vai ser fechar negócio com o tal empresário. “Não bus -
quei a coisa do mal, que assusta. Ele é descolado, vê humor nas coisas e tem uma certa despreocupação com a moral”, aponta Alexandre.
O pacto, porém, não irá agradar ao novo amor de Francis, Rosalinda, vivida pela atriz cearense Larissa Goes. Certa de seu amor pelo cinemista, a cantora de forró decide largar tudo para trás ao chegar em Pitombas com sua banda itinerante, só para viver o romance com Francis – e vai exigir dele a mesma entrega e dedicação. “Eu vejo nela uma segurança de tomar essa escolha, sabendo que, em outro momento, ela pode tomar outra escolha, a partir do que ela vai percebendo. No decorrer da temporada, quando ela percebe o que ele
fez, que o Francis mentiu, ela se afasta. Ela impõe o que ela prioriza na relação”, adianta a atriz.
Heloísa Périssé, Matheus Nachtergaele, Lorena Comparato e Cacá Carvalho também retornam para a nova temporada. Com direção de Patricia Pedrosa, a série de humor ainda contará com as participações especiais de Vladimir Brichta, Samantha Schmütz, Linn da Quebrada e Heloisa Jorge. “O Cine continua sendo um feliz encontro com a nossa brasilidade e uma ótima oportunidade de juntar a família em frente à telinha para relaxar e dar boas risadas juntos. É um antídoto para qualquer baixoastral”, destaca a diretora.

nova
“Cine Holliúdy” na globo retoma a universalidade da comédia nordestina
>> por caroline BorGes
Camila Queiroz sabe que novela é um trabalho em grupo. No ar em “Amor Perfeito”, a atriz ressalta a importância de criar vínculos sólidos com Diogo Almeida, que vive o protagonista Orlando. “Nosso encontro foi uma surpresa. A gente foi se conhecendo, se tocando... Foi uma preparação rápida, mas intensa e importante. Estamos subindo degraus na nossa relação a cada dia. Muito feliz de estar ao lado dele nesse trabalho”, afirma. Na história, Camila interpreta a mocinha Marê, que faz de tudo para encontrar seu filho perdido. “Ela não tem direito de viver essa maternidade porque o filho é roubado. Ela quer criar esse laço que foi rompido. A Marê quer se descobrir mãe”, aponta.
Irandhir Santos, que esteve em “Pantanal”, está escalado para “Guerreiros do Sol”, próxima novela original Globoplay. Escrita por George Moura e Sergio Golderberg, a produção tem estreia prevista para o ano que vem.
A trama da nova temporada de “Justiça” terá Brasília e Ceilândia como locações. Criada e escrita por Manuela Dias, a produção original Globoplay é estrelada por Murilo Benício, Paolla Oliveira e Nanda Costa. O projeto tem estreia prevista para o segundo semestre.
O ator Rômulo Braga será um dos protagonistas da série “DNA do Crime”, novo original Netflix. A produção nacional tem criação de Heitor Dhalia, Leonardo Levis e Bernardo Barcellos e direção de Heitor Dhalia.
No ar em “Poliana Moça”, Isabella Moreira estará no elenco de “Dois Tempos”, novo original Star+. A produção, que conta a história de duas garotas que viajam no tempo, estreia no próximo dia 10 de maio.

O Grupo Bandeirantes e a LIGA-RJ renovaram o contrato de transmissão da Série Ouro do Carnaval carioca por mais dois anos. Com isso, a Band levará ao ar com exclusividade os desfiles de 2024 e 2025. No ano que vem, as agremiações da Série Ouro se apresentarão na sexta e sábado de folia na Marquês de Sapucaí.
Após “Quanto Mais Vida, Melhor!”, Pedroca Monteiro participará da segunda temporada de “Matches”, do canal Warner Channel. Ainda sem data prevista para a estreia, a série é uma coprodução da Migdal com a WBD para a Warner Channel.
Ainda este ano, Luana Piovanni grava a segunda temporada de “Luana É De Lua”, do E!. No “reality show”, a atriz levanta temas relevantes e de interesse geral, com roda de conversa e experimentações que a tiram de sua zona de conforto. A cada programa, Piovanni recebe convidados para debater assuntos como separação, relacionamentos amorosos via internet, sanidade mental e genialidade.

No ar em “Travessia”, Duda Santos também estará no “streaming” em breve. A intérprete de Isa está no elenco de “Um Ano Inesquecível – Verão”, do Amazon Prime Vídeo. Na história, ela viverá uma jovem carioca. “Foi uma experiência incrível e aprendi demais. Foi meu segundo trabalho. Acho que eu nunca aprendi tanto quanto ali. O filme está lindo e eu amei fazer”, explica a atriz, que foi chamada para a novela das nove logo após finalizar as gravações do longa. “Foi tudo muito rápido. Fiz o teste e duas semanas depois fiquei sabendo que tinha sido aprovada”, completa.